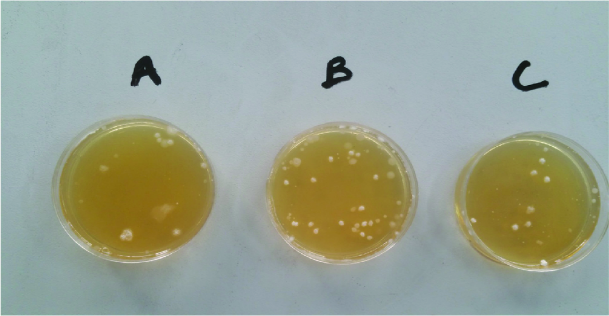
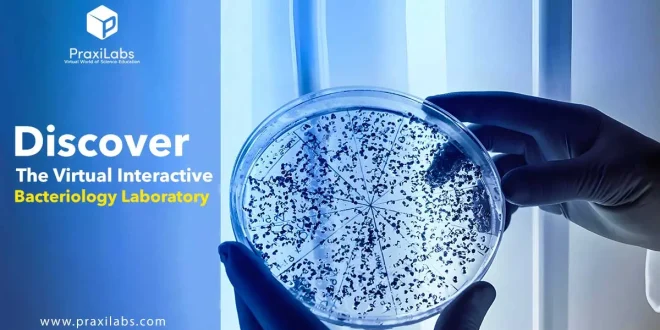

Фазылова Жибек Убеновна
«Жасанды интеллект және биологияның болашақ зерттеулері» авторлық бағдарлама
Атырау – 2025
УДК 371.214
ББК 74.202
Ф 16
Рецензент:
Калиманова Данагул Жаскайратовна - Х.Досмұхамедов атындағы Атырау университеті КеАҚ
“Химия және химиялық технология” кафедрасының қауымдастырылған профессоры, биология ғылымдарының кандидаты
Фазылова Ж.У.
«Жасанды интеллект және биологияның болашақ зерттеулері» авторлық бағдарлама. Атырау. Ақжайық баспасы. 70 бет.
ISBN 978-601-12-4135-9
Бағдарлама негізінен жоғары сынып оқушыларына, жаңа технологияларға қызығушылығы бар жас зерттеушілерге арналған. Негізгі мақсат – биология мен жасанды интеллект салаларының өзара байланысын ғылыми тұрғыда түсіндіру және болашақтағы қолданбалы зерттеулерге жол ашу.Бұл бағдарлама – ғылымға қызығатын жастар үшін болашақтағы инновациялық жетістіктерге алғашқы қадам. ЖИ мен биологияны үйлестіре отырып, оқушылар шынайы өмірге бағытталған мәселелерді ғылыми тұрғыда шешуді үйренеді, өз зерттеуін жүргізуге ынталанады.
УДК 371.214
ББК 74.202
Ф 16
Фазылова Ж.У.., 2025
Түсінік хат
Бүгінгі таңда ғылым мен техниканың жедел дамуы жасанды интеллект (ЖИ) технологияларын әртүрлі салада, соның ішінде биологияда да кеңінен қолдануға мүмкіндік беріп отыр. ЖИ құралдарының көмегімен күрделі биологиялық жүйелерді модельдеу, генетикалық деректерді талдау, ауруларды ерте диагностикалау және емдеу стратегияларын оңтайландыру сияқты міндеттерді тиімді шешуге болады. Осыған орай, биология мен ЖИ-дің тоғысқан тұсында орналасқан пәнаралық бағыттар – қазіргі ғылымның басым бағыттарының бірі ретінде айқындалып отыр.
Ұсынылып отырған авторлық бағдарлама білім алушылардың биология және жасанды интеллект салалары бойынша іргелі және қолданбалы білімін тереңдетуге, сондай-ақ зерттеушілік құзыреттерін дамытуға бағытталған. Бағдарлама мазмұны биологиялық деректерді сандық түрде өңдеу, оларды талдауда заманауи алгоритмдер мен модельдерді қолдану, сондай-ақ деректер ғылымы мен биоинформатика негіздеріне сүйену арқылы құрылымдалған.
Курс аясында білім алушылар жасанды интеллекттің теориялық негіздерімен танысып қана қоймай, нақты биологиялық міндеттерді шешуге арналған практикалық дағдыларды меңгереді. Атап айтқанда, геномдық мәліметтерді машиналық оқыту әдістері арқылы өңдеу, жасушалық процестерді модельдеу, ақуыз құрылымын болжау, экологиялық мониторинг жүйелерін автоматтандыру және медициналық диагнозды қолдау сияқты нақты жобалар қарастырылады.
Сонымен қатар, бағдарлама ғылыми ізденіске ынталандыру, ақпараттық технологияларды биологиялық зерттеулерге интеграциялау және оқушылардың болашақ кәсіби бағдарын айқындауға жәрдемдесу мақсатын көздейді. Оқыту процесі жобалық және зертханалық жұмыстармен, дербес зерттеулермен, цифрлық ресурстармен жұмыс істеумен толықтырылады.
Осы арқылы курс білім алушыларды XXI ғасыр ғылымына қажетті пәнаралық біліммен және заманауи зерттеу дағдыларымен қаруландыруға бағытталған инновациялық білім беру өнімі ретінде қызмет етеді.
Кіріспе
XXI ғасырдың басынан бастап ғылым мен технология қарқынды дамып, жаратылыстану және ақпараттық технологиялар салаларының түйіскен тұсында жаңа пәнаралық бағыттар пайда болуда. Солардың бірі – биология мен жасанды интеллекттің (ЖИ) интеграциясына негізделген биоинформатика мен деректер ғылымы бағытындағы зерттеулер. ЖИ технологиялары биологиялық деректерді өңдеу мен талдауда, күрделі жүйелерді модельдеуде, және медициналық-биологиялық міндеттерді шешуде тиімді құрал ретінде қалыптасып келеді.
Осы авторлық курс биология мен жасанды интеллект салаларының өзара байланысын, олардың болашақтағы ғылыми зерттеулердегі әлеуетін зерттеуге бағытталған. Бағдарлама аясында білім алушылар ЖИ-дің теориялық негіздерін меңгеріп қана қоймай, оларды биологиялық мәселелерді шешу үшін қолдануды тәжірибе жүзінде үйренеді. Сонымен қатар, курс оқушылардың зерттеушілік құзыреттерін дамытуға, пәнаралық ойлау қабілетін қалыптастыруға, заманауи ғылыми әдістермен жұмыс істеуге бейімдеуге мүмкіндік береді.
Бағдарлама мазмұны қазіргі ғылыми-практикалық талаптарға сай құрылып, оқушылардың болашақта биомедицина, биоинформатика, экология, биотехнология сияқты салаларда кәсіби бағдар алуына негіз болады.
Мақсаты:
Биологиялық ғылымдар мен жасанды интеллекттің тоғысқан тұсындағы өзекті ғылыми бағыттарды меңгерту арқылы білім алушылардың пәнаралық танымын кеңейту, биологиялық деректерді талдау және модельдеу үшін ЖИ әдістерін қолдануға машықтандыру, сондай-ақ зерттеушілік және жобалық қызметке бейімдеу.
Міндеттері:
-
Жасанды интеллекттің теориялық негіздерін (машиналық оқыту, нейрондық желілер, алгоритмдер) жүйелі түрде меңгерту.
-
Биологиядағы күрделі деректерді өңдеу мен талдауда ЖИ құралдарын қолданудың мүмкіндіктерін көрсету.
-
Биоинформатика, геномика, экология, молекулалық биология салаларында қолданылатын нақты ЖИ-бағытталған жобалармен таныстыру.
-
Python тілі және биоинформатикалық кітапханалар негізінде биологиялық мәліметтермен жұмыс істеу дағдыларын қалыптастыру.
-
Оқушылардың сыни ойлауын, ғылыми зерттеу жүргізу дағдыларын және пәнаралық құзыреттіліктерін дамыту.
-
Цифрлық сауаттылықты, ақпаратпен жұмыс істеу мәдениетін және деректерге негізделген шешім қабылдау қабілетін жетілдіру.
-
Оқушылардың болашақ кәсіби бағдарын (биотехнология, биомедицина, деректер ғылымы, т.б.) айқындауға ықпал ету.
Бағдарламаның тәжірибелік құндылығы:
«Жасанды интеллект және биологияның болашақ зерттеулері» бағдарламасының тәжірибелік құндылығы – білім алушылардың теориялық білімін нақты тәжірибелік әрекетпен ұштастыра отырып, оларды пәнаралық ғылыми-зерттеу дағдыларына баулуға бағытталғанында. Бағдарлама мазмұны биологиялық мәліметтерді талдау мен модельдеуде қолданылатын заманауи жасанды интеллект технологияларын меңгеруге мүмкіндік береді, бұл өз кезегінде оқушылардың болашақта кәсіби қызметке бейімделуіне негіз болады.
Курс барысында білім алушылар нақты деректермен жұмыс істей отырып, Python бағдарламалау тілі арқылы биоинформатикалық есептерді шешуді, мәліметтерді сандық өңдеуді, визуализация жасауды және қарапайым алгоритмдер құруды үйренеді. Мұндай дағдылар биология, медицина, экология, биотехнология және ақпараттық технологиялар салаларындағы қолданбалы зерттеулер мен практикалық жобаларда кеңінен қолданылады.
Бағдарламада ұсынылған практикалық тапсырмалар мен жобалық жұмыстар оқушыларды дербес ойлауға, ғылыми проблемаларды пәнаралық тәсілмен шешуге және өз жобаларын жоспарлап, нәтижесін негіздеп ұсынуға үйретеді. Сонымен қатар, оқушылар биологиялық және медициналық деректер қорларымен (мысалы, NCBI, EMBL, PubMed) жұмыс істеу дағдыларын меңгеріп, цифрлық сауаттылық пен ақпараттық мәдениетті дамытады.Осылайша, бағдарлама білім алушыларға болашақ ғылыми-зерттеу және инженерлік жобаларға қатысуға дайындық беріп, жоғары оқу орындары мен ғылыми орталықтардағы пәнаралық білім беру және ғылыми ортаға бейімделуіне мүмкіндік жасайды. Бағдарламаның тәжірибелік бағыттылығы – оны жаратылыстану және техникалық білім беру саласында қолдануға ыңғайлы, өмірлік маңызы бар дағдыларды қалыптастыратын заманауи білім беру құралы ретінде қарастыруға мүмкіндік береді.
Бағдарламаны оқытудан күтілетін нәтижелер:
Бағдарламаны меңгеру нәтижесінде білім алушылар жасанды интеллект пен биологияның тоғысқан тұсындағы пәнаралық мәселелерді түсініп, оларды ғылыми негізде талдай алуға қабілетті болады. Оқушылар жасанды интеллекттің теориялық негіздерін, оның ішінде машиналық оқыту, нейрондық желілер және деректерді өңдеу алгоритмдерін меңгеріп, оларды нақты биологиялық міндеттерді шешуде тиімді қолдануды үйренеді.
Биологиялық деректермен (геномдық, протеомдық, физиологиялық және экологиялық) жұмыс істеу дағдыларын игере отырып, білім алушылар Python бағдарламалау тілі және заманауи биоинформатикалық құралдар арқылы деректерді өңдеу, талдау және визуализациялау әдістерін практикада қолдана алады. Сонымен қатар, олар қарапайым жасанды интеллект модельдерін құру, оларды нақты биологиялық кейстерге бейімдеу және нәтижелерін ғылыми тұрғыдан интерпретациялау қабілеттерін қалыптастырады.
Оқушылардың зерттеушілік дағдылары да дамиды: олар ғылыми гипотеза құру, деректер жинау мен талдау, қорытынды жасау және нәтижені ғылыми тілде ұсыну іскерліктерін меңгереді. Бағдарлама қатысушылардың пәнаралық ойлау қабілетін, сыни көзқарасын, жобалық және командалық жұмыс дағдыларын жетілдіреді. Сонымен қатар, оқушылар биология, биотехнология, биомедицина, деректер ғылымы және жасанды интеллект салаларында болашақ кәсіби бағдарын саналы түрде айқындай алады.
Жалпы алғанда, бағдарлама оқушыларға ХХІ ғасырдың ғылымына тән пәнаралық құзыреттіліктерді игеруге, ғылыми-зерттеу жұмыстарына дайындық деңгейін арттыруға және заманауи технологияларды саналы қолдануға мүмкіндік береді.
Нормативтік бөлім
«Жасанды интеллект және биологияның болашақ зерттеулері» авторлық бағдарламасының күнтізбелік – тақырыптық жоспары:
|
Р/с |
Тақырыптар |
Сағат |
|
1 |
Жасанды интеллект және қазіргі биология |
1 |
|
2 |
Ферментативті катализде белсенді орталықтың ролі. Ферменттердің иммобилизациясы. Зертханалық жұмыс "Иммобилизациялаудың ферменттердің белсенділігіне әсерін зерттеу" |
1 |
|
3 |
Трансляция кезеңдері,нәруыз биосинтезі |
1 |
|
4 |
Генетикалық кодтың қасиеттері: үшөрімділігі,көптігі, әмбебаптығы, бірін-бірі жаппайтындығы |
1 |
|
5 |
Хлоропластың құрылымдық компоненттері және олардыңқызметтері |
1 |
|
6 |
Фотосинтездің жарық кезеңі |
1 |
|
7 |
Заттар тасымалының симпластық,апопластық,вакуолярлық жолдары мен олардың маңызы |
1 |
|
8 |
Биологиядағы басқару жүйесі |
1 |
|
9 |
Гормондардың әсер ету механизмі.Инсулин мысалында гормондардың нысана жасушаларға әсер ету механизмі |
1 |
|
10 |
Өсіргіш заттар .Өсіргіш заттардың өсімдіктерге әсер ету механизмі |
1 |
|
11 |
Гаметогенез.Адам гаметогенезінің сатылары |
1 |
|
12 |
Бағаналы жасушалар ұғымы және олардың қасиеттері |
1 |
|
13 |
Бағаналы жасушалардың түрлері :эмбриональды және соматикалық.Практикада қолданылуы |
1 |
|
14-15 |
ДНҚ-ның кездейсоқ мутациясы ,генетикалық үдеріс қателіктері,репликация.ДНҚ-ның кездейсоқ мутациясы,репарация,репкомбинация |
2 |
|
16 |
«Адам геномы» жобасы.Адамның геномдықДНҚ-сын секвенирлеу |
1 |
|
17 |
Микробиологиялық зерттеудің кезеңдері |
1 |
|
18 |
Зертханалық жұмыс: Сүт қышқылды өнімдердің әртүрлікоректікортадағы микрофлорасын зерттеу |
1 |
|
19 |
Грамм оң грамм теріс бактериялар және олардың құрылыс ерекшеліктері |
1 |
|
20 |
«Рекомбинативті ДНҚ » ұғымы,алутәсілдері,қолданылуы |
1 |
|
21 |
Плазмиданың қасиеттері және олардың генетикалық клондауда қолданылуы |
1 |
|
22 |
Электромагниттік дыбыс толқындарының адам ағзасына әсерету ерекшеліктері |
1 |
|
23 |
Эпигенетиканың молекулярлық негіздері негіздері,оның адамдағы салдарлары |
1 |
|
24 |
«Биоинформатика» ұғымы. Биоинформатикақұралдарын зерттеулерге қолдану |
1 |
|
25 |
Экстракорпоралды ұрықтандыру әдісі және оның маңызы |
1 |
|
26 |
Экстракорпоральды ұрықтандырудың этикалық аспектілері |
1 |
|
27 |
Моноклоналды антиденелер көмегімен ауруларды диагностикалау және емдеу |
1 |
|
28 |
Харди-Вайнберг генетикалық тепе-теңдік заңы.Сирек кездесетін және жойылып бара жатқан өсімдіктер мен жануарлардың түрлерін қорғау |
1 |
|
29 |
Экологиялық жағдайлар менэкологиялық есептерді шешу жолдары |
|
|
30 |
Жергілікті экожүйенің биоалуантүрлілігн анықтауда кездейсоқ іріктеу әдісінің маңызы |
1 |
|
31 |
Климаттың экологиядлық проблемалары және оны шешу жолдары дебат сабақ |
1 |
|
32 |
Ғаламдық жылыну оның себептерімен салдарлары ,шешу жолдары |
1 |
|
33 |
«Дебат: «Табиғат – ортақ үйіміз» (Атырау қаласы мысалында) |
1 |
|
34 |
«Жасыл желек -ауыл тынысы» жоба қорғау |
1 |
1 сабақ ҚМЖ
|
Ұзақ мерзімді жоспар бөлімі: |
Кіріспе бөлім |
||||||||||||||||||||
|
Күні: |
Мұғалімнің аты-жөні: |
||||||||||||||||||||
|
Сынып: 11 |
Қатысқандар саны: |
Қатыспағандар саны: |
|||||||||||||||||||
|
Сабақ тақырыбы |
Жасанды интеллект және қазіргі биология |
||||||||||||||||||||
|
Осы сабақта қол жеткізілетін оқу мақсаттары (оқу бағдарламасына сілтеме) |
ЖИ ұғымын және оның биологиядағы қолданылу бағыттарын түсіндіру, биологиядағы нақты мысалдар арқылы ЖИ қолданудың маңызын дәлелдеу.
|
||||||||||||||||||||
|
Сабақ мақсаттары |
ЖИ ұғымын және оның биологиядағы қолданылу бағыттарын түсінеді биологиядағы нақты мысалдар арқылы ЖИ қолданудың маңызын дәлелдейді
|
||||||||||||||||||||
|
Адал азамат» біртұтас тәрбие бағдарламасы құндылықтарын енгізу |
Академиялық шыншылдық, нақтылық, өзін өзі реттей білу , ойды реттей білу, сенімділік, дәлелдерді қолдана білу ,өзіне деген сенімділік, өзін-өзі көрсету болу құндылықтары дамытылады. |
||||||||||||||||||||
|
Сабақ барысы |
|||||||||||||||||||||
|
Сабақтың жоспарланған кезеңдері |
Сабақтағы жоспарланған іс-әрекет |
Ресурстар |
|||||||||||||||||||
|
Сабақтың басы 0-2 САБАҚТЫҢ ОРТАСЫ |
Қызығушылықты ояту – Жеке жұмыс (5 минут)Тапсырма 1. «ЖИ менің өмірімде» (жеке) Оқушы күнделікті өмірде кездесетін ЖИ мысалдарын жазады ЖИ қолданылатын биологиялық салалар (қысқаша шолу)
Қортынды ойларын айтады
ЖИ – биологияны жылдам, дәл және болашаққа бағытталған ғылымға айналдырады деп ойлаймыз
Жаңа білім – Мұғалім түсіндірмесіҒылыми негізде түсіндіру: презентациямен виожазбамен түсінік беру
ЖИ – бұл деректерді талдап, үйрену арқылы шешім қабылдайтын компьютерлік жүйе; Биологияда ЖИ үлкен деректермен (геном, ДНҚ, медициналық суреттер) жұмыс істейді;
ЖИ биоинформатика, медицина, экология, генетика салаларында қолданылады.
Нақты ғылыми мысалдар: ЖИ рентген және МРТ арқылы қатерлі ісікті анықтайды; Геномды талдау арқылы тұқым қуалайтын ауруларды болжайды; Ақуыз құрылымын болжау (AlphaFold Жұптық жұмысТапсырма 2. «Күнделікті өмір Ғылыми биология» (жұптық) Кестені толтыр:
Оқушы жауабтары ЖИ – бұл деректерді талдап, үйрену арқылы шешім қабылдайтын компьютерлік жүйе. Күнделікті өмірден:Face ID – бет-әлпетті таниды; YouTube – қызығушылығыңа сай видео ұсынады; Google Translate – мәтінді аударады. Биологиядағы дәл сол принцип:ЖИ мыңдаған медициналық суретті көріп үйренеді; Қалыпты мен ауру жасушаны ажыратуды үйренеді; Кейін жаңа дерекке өз бетінше шешім шығарады.
Айырмашылығы: Топтық жұмыс (12 минут)Тапсырма 3. «ЖИ биологияны қалай өзгертеді?» Әр топқа бір бағыт беріледі:
1-топ – Медицинадағы ЖИ Топтық жауаптардың нақты мазмұны: Медицина: ауруды ерте анықтау, дәрі таңдауды оңтайландыру; Генетика: ДНҚ тізбектерін салыстыру, мутацияны табу; Экология: жануарлар санын есептеу, климат өзгерісін болжау. Дескриптор: ЖИ қолданылатын саланы дұрыс сипаттайды – 1 балл Нақты ғылыми мысал келтіреді – 1 балл Топта бірлесіп постер/ауызша қорғау жасайды – 1 балл 1топ Медицинадағы ЖИАуруды ерте анықтау, дәрі таңдауды оңтайландыру Нақты мысалдар мен деректерҚатерлі ісікті ерте анықтау Google Health жасаған ЖИ маммография суреттері арқылы сүт безі обырын дәрігерлерге қарағанда 5–10% дәл анықтайды. ЖИ рентген, КТ, МРТ суреттеріндегі көзге көрінбейтін өзгерістерді табады. COVID-19 кезінде ЖИ өкпе КТ-сын талдап, аурудың ауырлығын алдын ала болжады. Кейбір елдерде диагноз қою уақыты 2–3 есе қысқарды. Дәрі таңдауды оңтайландыру (personalized medicine) ЖИ науқастың: жасы, генетикалық ерекшелігі,
бұрынғы аурулары Онкологияда бұл әдіс жанама әсерді азайтады. Қызықты дерекКейбір ЖИ жүйелері ауруды адам белгілерін сезбей тұрып анықтай алады. 2 топ Генетикадағы ЖИДНҚ тізбектерін салыстыру, мутацияны табу Нақты мысалдар мен деректер
ЖИ: BRCA1/BRCA2 мутацияларын анықтап, сүт безі обырының қаупін болжайды. Сирек генетикалық ауруларды (мысалы, муковисцидоз) анықтауда қолданылады. AlphaFold (DeepMind) Ақуыздардың 3D құрылымын болжады. Бұл жаңалық биологиядағы 50 жылдық мәселені шешті. Қызықты дерек2021 жылы AlphaFold 200 миллионнан астам ақуыз құрылымын болжады – бұл бүкіл тірі ағзалардың көп бөлігі. Экологиядағы ЖИЖануарлар санын есептеу, климат өзгерісін болжау Нақты мысалдар мен деректерЖануарларды санау Дрон + ЖИ арқылы: піл, кит, киік сияқты жануарлар автоматты саналады. Бұл әдіс адамға қарағанда 10 есе жылдам және қауіпсіз. Қызыл кітап түрлерін қорғау Камера-тұзақтағы миллиондаған суреттерді ЖИ сұрыптайды. Сирек жануарлар қозғалысы бақыланады. Климат өзгерісін болжау ЖИ: температура, жауын-шашын,
мұздықтардың еруі Қызықты дерекКейбір ЖИ модельдері орман өртін бірнеше күн бұрын болжай алады |
Презентация PowerPoint Слайд 1 Слайд 2-4
Презентация
(PowerPoint) Видео |
|||||||||||||||||||
|
Сабақтың соңы 39-40 мин |
Қорытынды және рефлексия«3–2–1» әдісі:
Үйге тапсырма «ЖИ болашақта биологияны қалай өзгертеді?» тақырыбына 5–6 сөйлемдік шағын эссе.
|
Слайд 8
|
|||||||||||||||||||
2 сабақ Қысқа мерзімді жоспар
|
Ұзақ мерзімді жоспар |
|
|
|
Күні: |
Мұғалімнің аты-жөні: |
|
|
|
Қатысқандар саны: |
Қатыспағандар саны: |
|
Сабақ тақырыбы |
Ферментативті катализде белсенді орталықтың ролі. Ферменттердің иммобилизациясы. Зертханалық жұмыс "Иммобилизациялаудың ферменттердің белсенділігіне әсерін зерттеу" |
|||||||||||
|
Осы сабақта қол жеткізілетін оқумақсаттары (оқу бағдарламасына сілтеме) |
11.4.1.2 - фермент-субстраткомплексініңтүзілумеханизмінтүсіндіру |
|||||||||||
|
Сабақ мақсаттары |
Оқушыларғафермент-субстраткомплексініңтүзілумеханизмінтүсіндіру |
|||||||||||
|
Бағалау критерийлері |
ОқушыларФермент пен субстраттың өзара әрекеттесуін түсінеді; Иммобилизациялаудың ферменттердің белсенділігіне әсерін зерттей алады; |
|||||||||||
|
Адал азамат» біртұтас тәрбие бағдарламасы құндылықтарын енгізу |
Академиялық шыншылдық, нақтылық, өзін өзі реттей білу , ойды реттей білу, сенімділік, дәлелдерді қолдана білу ,өзіне деген сенімділік, өзін-өзі көрсету болу құндылықтары дамытылады. |
|||||||||||
|
Сабақ барысы |
||||||||||||
|
Сабақтың жоспарланған кезеңдері |
Сабақтағы іс-әрекет
|
Ресурстар |
||||||||||
|
Сабақтың басы |
Сабақбасында: - оқушылардыңзейініншоғырландыруүшіналдыңғыбілімдерінтексерусұрақтары:
Жұппен жұмыс Тапсырма 1. Теориялық сұрақтар 1) Фермент дегеніміз не? 2) Белсенді орталық деген ұғымды түсіндіріңіз. 3) «Кілт–құлып» және «индукцияланған сәйкестік» модельдерін салыстырыңыз. 4) Иммобилденген ферменттер дегеніміз не? Дескриптор: – Фермент анықтамасын дұрыс береді;1б – Белсенді орталықтың қызметін сипаттайды;2б – Екі модельдің айырмашылығын көрсетеді; 2б – Иммобилизация ұғымын түсіндіреді. 1б Жеке жұмыс
Тапсырма 2. Сәйкестендіру тапсырмасы Ферменттер Субстраттар 1. Амилаза а) Крахмал 2. Интерфаза б) Сахароза Дұрыс жауабы: 1–а, 2–б Дескриптор: – Фермент пен субстрат арасындағы сәйкестікті дұрыс табады.2б - оқушылармен бірге бүгінгі зерттханалық сабақ мақсаттарын талдау, бағалау критерийлерімен таныстыру. |
Презентация
|
||||||||||
|
Сабақтың ортасы |
Зертханалықжұмыс "Иммобилизациялаудыңферменттердіңбелсенділігінеәсерінзерттеу" Мақсаты: Ферменттік -субстрат кешенінің түзілу механизмі түсіндіру Құрал-жабдықтар: 2%-дық крахмал және сахароза қоспасы, амилаза және интерфаза ферменттері. Болжам (болжамды жазу үшін сұраққа толық жауап беріңіз): Ферменттік-субстрат кешенінің түзудің жолы Қауіп-қатер:__________________________________________ ______________________________________________________ Нұсқаулық: Ферменттік реакция былай жүреді:
E + Е – фермент, S - субстрат ES – фермент-субстраттық кешен EP –фермент –өнім А, В – реакцияның соңғы өнімдері Фермент-субстрат кешенінің түзілуі ферменттің белгілі бір қасиеттеріне байланысты.Ферменттің белсенділігі стандартты жағдайларда ферменттің салмағына бір минутта өзгеріске ұшырайтын субстраттың мольдік санымен көрсетілетін молекулалық белсенділіктің шамасымен бағаланады. Жұмыстың барысы: 4 пробирка алып, 1-ші және 2-ші пробиркаларға 2мл 2%-тік крахмал қоспасын, ал 3-ші және 4-ші пробиркаларға 2мл сахароза қоспасын құямыз. Содан соң 1-ші және 3-ші пробиркаларға 0,5мл амилаза ферментін, ал 2-ші және 4-ші пробиркаларға 0,5мл интерфаза ферментін қосамыз. Пробиркалардағы қоспаларды жақсылап араластырып, 40º С-тық су буында 15 минут ұстаймыз. Одан кейін пробирканы суытып, йодпен және Троммер реакциясын жүргіземіз. Троммер реакциясы үшін 1мл ерітінді алынады, ал қалған ерітінділерге 2-3 тамшы йод ерітіндісін қосады. Тәжірибе қорытындысын 1-ші кестеге жазамыз
Ферменттердің белсенділігі биохимиялық қосылыстардың жылдамдығы әсерінен қарапайым түрде былай сипатталады: фермент субстрат өнім Бұл жерде амилаза Фермент, Крахмал субстрат, кейін өнім алынады Амилазаны крахмал қоспасы бар пробиркаға құйып жаймен шайқау керек
Қорытынды: Ферменттік субстрат кешенінің түзілу қалай жүзеге асады , жұмысты қорытындылау
.......................................................................................... Дескриптор: – Тәжірибені нұсқаулыққа сай жүргізеді;1б – Нәтижені кестеге дұрыс жазады;2б – Реакция нәтижесін түсіндіреді 1б
Тест тапсырмаларын орындайды
1. Ферменттің белсенді орталығы дегеніміз не?
A) Ферменттің барлық молекуласы Дұрыс жауап: B
2. Белсенді орталықтың субстратқа сәйкестігін түсіндіретін модель:
A) Энергетикалық модель Дұрыс жауап: B
3. Белсенді орталықтағы аминқышқылдарының негізгі ролі:
A) Ферменттің еруін арттыру Дұрыс жауап: B
4. Индуцирленген сәйкестік моделінің мәні неде?
A) Белсенді орталық өзгермейді Дұрыс жауап: C
5. Ферментативті катализ кезінде белсенді орталықта қандай байланыстар түзіледі?
A) Тек ковалентті Дұрыс жауап: C
6. Ферменттердің иммобилизациясы дегеніміз:
A) Ферменттің бұзылуы Дұрыс жауап: C
7. Иммобилизацияланған ферменттердің артықшылығы:
A) Белсенділігі әрдайым төмен Дұрыс жауап: C
8. Ферменттерді иммобилизациялаудың бір әдісі:
A) Қыздыру Дұрыс жауап: C
9. Иммобилизацияланған ферменттер көбіне қай салада қолданылады?
A) Астрономияда Дұрыс жауап: B
10. Иммобилизацияның кемшілігі болып табылады:
A) Ферменттің толық жойылуы Дұрыс жауап: B
|
https://youtu.be/ISf6ClTbg78
|
||||||||||
|
Сабақтың соңы |
Сабақсоңындаоқушыларбағалау критерийлеріне оралу арқылы рефлексияжүргізеді: ОқушыларФерментпенсубстраттыңөзараәрекеттесуін түсінеді; Иммобилизациялаудың ферменттердің белсенділігіне әсерін зерттей алады; - нені білдім, нені үйрендім - нені толық түсінбедім - немен жұмысты жалғастыру қажет
Оқушылар өздерінің жұмысы мен сыныптастарының жұмысын белгілі бір критерийлер бойынша бағалай алады |
|
||||||||||
3 сабақ Қысқа мерзімді жоспар
|
|
|
|||||||||||||||||||||||||||||||||||||||||||||||||||||||||||||||||
|
Күні: |
Мұғалімнің аты-жөні: |
|||||||||||||||||||||||||||||||||||||||||||||||||||||||||||||||||
|
|
Қатысқандар саны: |
Қатыспағандар саны: |
||||||||||||||||||||||||||||||||||||||||||||||||||||||||||||||||
|
Сабақ тақырыбы |
Трансляция кезеңдері,нәруыз биосинтезі |
|||||||||||||||||||||||||||||||||||||||||||||||||||||||||||||||||
|
Осысабақтақолжеткізілетіноқумақсаттары |
ДНҚ молекулаларындағы ақуыздардың құрылымдық ақпараттардың кодтауын көрсету нәруыз синтезі процесін сипаттау |
|||||||||||||||||||||||||||||||||||||||||||||||||||||||||||||||||
|
Сабақ мақсаттары |
11.4.1.3 - Нәруыз биосинтез кезеңдерін сипаттайды |
|||||||||||||||||||||||||||||||||||||||||||||||||||||||||||||||||
|
Бағалау критерийлері |
Транскрипция және трансляция үрдістерін кемінде сегіз сөзді пайдаланып сипаттайды Ақуыз синтезі процесін түсіндіреді |
|||||||||||||||||||||||||||||||||||||||||||||||||||||||||||||||||
|
Адал азамат» біртұтас тәрбие бағдарламасы құндылықтарын енгізу |
Академиялық шыншылдық, нақтылық, өзін өзі реттей білу , ойды реттей білу, сенімділік, дәлелдерді қолдана білу ,өзіне деген сенімділік, өзін-өзі көрсету болу құндылықтары дамытылады. |
|||||||||||||||||||||||||||||||||||||||||||||||||||||||||||||||||
|
Сабақ барысы |
||||||||||||||||||||||||||||||||||||||||||||||||||||||||||||||||||
|
Сабақтың жоспарланған кезеңдері |
Сабақтағы жоспарланған іс-әрекет |
Ресурстар |
||||||||||||||||||||||||||||||||||||||||||||||||||||||||||||||||
|
Сабақтың басы
|
(W) Алдыңғы өтілген ақуыз синтезінің кезеңдерін топтардың естеріне түсіру үшін сұрақтар қойылады |
ноутбукте түрлі –түрлі сызбаларды қарау, қажетті қосымша ақпараттарды іздеп тауып ала білу дағдылары |
||||||||||||||||||||||||||||||||||||||||||||||||||||||||||||||||
|
Сабақтың ортасы
Сабақтың ортасы |
(Р) оқушылар жұбына жеке тапсырмалар беріліп, оқушылар әр кезеңді сызбалап түсіндіреді. 1жұп-трансляция кезеңдерін жалпы сипаттау 2жұп-генетикалық ақпараттың ДНҚ дан кодталуы 3жұп- тРНҚ құрылысы 4жұп-инициация 5жұп-элонгация 6жұп-терминация Нәруыз синтезі туралы видеолар көрсетіледі
(G) (f) Жұптарға трансляция кезеңдері бейнелген суреттері мен түсініктемелері жазылған карточкалар жиынтығын беріледі. Оқушылар карточкаларды логикалық тәртіпте орналастырады. Оқушылар жұбы басқа жұптарға сұрақтар қояды.
|
https://www.youtube.com/watch?v=eik96kz5Kn4
|
||||||||||||||||||||||||||||||||||||||||||||||||||||||||||||||||
|
|
|
|||||||||||||||||||||||||||||||||||||||||||||||||||||||||||||||||
|
Сабақтың ортасы
|
Оқушылар транскрипциядан бастап, нәруыз синтезінің кезеңдерін жалпылама түрде модельдейді. Ең маңызды кезеңдеріне, яғни маңызды процесстеріне тоқталулары тиіс.
Карточкалар жиынтығын дайындаңыз. Әр карточкада нәруыз синтезінің бір кезеңінің қысқаша сипаттамасы болуы керек. Топтардағы оқушыларға кезеңдердің ретін (тәртібін) - егер олар әлі өтілмеген болса да логиканы пайдаланып табу керек. 2-бөлім. Карточкалар жиынтығы
3-бөлім. Қорытынды тест тапсырмалары
Карточкалардың көшірмелері жасалғасын, кезекті (тәртібін) тексергеннен кейін, оқушылар оларды өз кітаптарында қалдыра алады. Олардан бүкіл процесті – генетикалық кодтан бастап, гемоглобин түзілгенге дейін толық пысықтау талап етіледі. Бұл оларға нәруыздар ұйымдасуының 4 кезеңін көруге мүмкіндік береді. Түрлі топтарға түрлі ақуыздарды беруге болады. Оқушылар модельде түсіндіреді1-МОДЕЛЬ: «ТАҒАМ → ҚАН → СҮЙЕК КӨМІГІ → ГЕМОГЛОБИН Кеңейтілген жұмыс: гемоглобинде темірдің қалай пайда болатындығы сұралады 1 модель
1-кезең. Темірдің тағамнан түсуі Темір адам ағзасына тағам арқылы түседі: • ет, бауыр (гемдік темір) • бұршақ, жасыл өсімдіктер (гемдік емес темір) ? Бұл кезеңде темір Fe³⁺күйіндеболады. Дескриптор: • темірдің тағамнан түсетінін біледі • темірдің бастапқы күйін атай 2модель
2-кезең. Ішекте темірдің сіңірілуі Аш ішекте темір Fe³⁺ → Fe²⁺ түріне айналып, қанға өтеді.
Қанда темір арнайы
тасымалдаушы ақуыз – Дескриптор:
3 модель
3-кезең. Темірдің қоры Артық темір бауырда жинақталады. Ол жерде темірді сақтайтын ақуыз – ферритин. Дескриптор: • темірдің қор ретінде сақталатынын біледі • ферритиннің қызметін түсіндіреді
4 модель
Сүйек кемігінде гем түзілуі Қызыл сүйек кемігінде темір гем молекуласының ортасына орналасады. Гем – гемоглобиннің негізгі бөлігі, оның ортасында Fe²⁺ионыболады. Дескриптор: • гемнің құрылымдық рөлін түсіндіреді • темірдің гемге кіретінін көрсетеді СҰРАҚ (КЕҢЕЙТІЛГЕН ОЙЛАУҒА) Неліктен гемоглобиндегі темір Fe²⁺ күйінде болуы керек? Себебі Fe²⁺ ғана оттекті қайтымды түрде байланыстыра алады.
Бағалау үшін қысқа дескриптор (қорытынды)
тест тапсырмасы 1. Трансляция дегеніміз не?A) ДНҚ-ның
екі еселенуі Дұрыс жауап: B
2. Трансляция қай жасушалық құрылымда жүреді?A) Ядро Дұрыс жауап: C
3. Трансляцияның бірінші кезеңі:A) Элонгация Дұрыс жауап: C
4. Инициация кезінде бірінші болып қандай кодон танылады?A) UAA Дұрыс жауап: C
5. AUG кодоны қандай аминқышқылын кодтайды?A) Глицин Дұрыс жауап: C
6. Трансляция кезінде аминқышқылдарын рибосомаға жеткізетін РНҚ:A) мРНҚ Дұрыс жауап: B
7. Элонгация кезеңінде не жүреді?A) Рибосома мРНҚ-дан ажырайды Дұрыс жауап: B
8. Трансляцияның аяқталуы (терминация) қашан жүреді?A) Старт-кодонға жеткенде Дұрыс жауап: B
9. Стоп-кодондарға қайсысы жатады?A) AUG Дұрыс жауап: C
10. Нәруыз биосинтезінің соңғы нәтижесі:A)
РНҚ молекуласы Дұрыс жауап: C
|
|
||||||||||||||||||||||||||||||||||||||||||||||||||||||||||||||||
|
Сабақтың соңы |
Рефлексия - ненібілдім, неніүйрендім - ненітолықтүсінбедім - немен жұмыстыжалғастыруқажет |
|
||||||||||||||||||||||||||||||||||||||||||||||||||||||||||||||||
4 сабақ ҚМЖ
|
Ұзақ мерзімді жоспар бөлімі: Молекулярлықбиология жәнебиохимия
|
Мектеп: |
||||||||||||||
|
Күні: |
Мұғалімнің аты-жөні: |
||||||||||||||
|
Сынып:11 |
Қатысқандар саны: Қатыспағандар саны: |
||||||||||||||
|
Сабақ тақырыбы |
Генетикалықкодтың қасиеттері: үшөрімділігі,көптігі, әмбебаптығы, бірін-бірі жаппайтындығы |
||||||||||||||
|
Осы сабақта қол жеткізілетін оқу мақсаттары (оқу бағдарламасына сілтеме) |
11.4.1.5 - генетикалық кодтың қасиеттерін түсіндіру |
||||||||||||||
|
Сабақ мақсаттары |
Генетикалық кодтың қасиеттерін түсінеді |
||||||||||||||
|
Бағалау критерийлері |
|
||||||||||||||
|
Адал азамат» біртұтас тәрбие бағдарламасы құндылықтарын енгізу |
Академиялық шыншылдық, нақтылық, өзін өзі реттей білу , ойды реттей білу, сенімділік, дәлелдерді қолдана білу ,өзіне деген сенімділік, өзін-өзі көрсету болу құндылықтары дамытылады. |
||||||||||||||
|
Сабақ барысы |
|||||||||||||||
|
Сабақтың жоспарланған кезеңдері |
Сабақтағы жоспарланған іс-әрекет
|
Ресурстар |
|||||||||||||
|
Сабақтың басы |
Оқушылармен амандасу. Оқушылардың зейінін сабаққа аударту. Мұғалім сабақ тақырыбымен таныстырады. - оқушылармен бірге сабақ мақсаттарын/ОМ анықтап алу, сабақ соңында күтілетін нәтижелерді анықтау |
|
|||||||||||||
|
Сабақтың ортасы Сабақтың ортасы Сабақтың ортасы |
Оқушылардың
алдыңғы білімін тексеруге арналған
сұрақтар
Миға шабуыл: Гендеген не? Ген қайда орналасады? Генетикалық код не үшін керек? Топтық жұмыс Оқушыларды екі топқа бөлу. Әрбір топқа дидактикалық материалдар беріледі, сол бойынша кластер құрастыру 1 топ: Генетикалықкодтың қасиеттері: үшөрімділігі,көптігі 2 топ: Генетикалықкодтың қасиеттері: әмбебаптығы, бірін-бірі жаппайтындығы Критерий:
1-тапсырма. КЛАСТЕР ҚҰРАСТЫРУ (В деңгей) Тапсырма: «Генетикалық кодтың қасиеттері» тақырыбына кластер құрастырыңыз. Кластерде төмендегі қасиеттер міндетті түрде қамтылсын: Үшөрімділігі Көптігі Кластер мазмұнына қойылатын талаптар: Анықтамасы Мысал Маңызы Бағалау критерийі Генетикалық код қасиеттерін дұрыс анықтайды Кластерді логикалық байланыстырады Дескриптор Үшөрімділікке анықтама береді Көптік қасиетін түсіндіреді Әр қасиетке мысал келтіреді
Бұл схема: мРНҚ кодондары аминқышқылдардың кодталуы трансляция үдерісін көрсетеді Дұрыс жауап Үшөрімділігі – бір аминқышқылды 3 нуклеотид (кодон) кодтайды Көптігі – бір аминқышқылды бірнеше кодон кодтай алады (мысалы: лейцин – 6 кодон)
Әрбір топ жұмыстарын қорғайды және келесі топ бағалау жүргізеді Мұғалім кері байланыс беріп өтеді Тақырып: Генетикалық кодтың қасиеттері: әмбебаптығы, бірін-бірі жаппайтындығы 1. Генетикалық кодтың жалпы схемасы
Бұл схема кодон →
аминқышқыл принципін
көрсетеді. 2. Үшөрімділік қасиетінің схемасыНуклеотидтер: A U G | C C U Кодондар: AUG | CCU
Мағынасы: 1 кодон =
3 нуклеотид 3. Көптік (дегенерация) қасиетінің схемасыЛейцин аминқышқылы:
UUA, UUG, CUU, CUC,
CUA, CUG 4. Әмбебаптық қасиетінің схемасы
AUG
→ метионин (адам,
өсімдік,
бактерия) 5. Бірін-бірі жаппайтындығыAUG | GCU | UAC
Кодондар қабаттаспайды,
әр нуклеотид бір рет қолданылады. 2-тапсырма. САЛЫСТЫРУ (С деңгей)
Тапсырма:
Бағалау критерийі
Дескриптор
Өздік жұмыс: Оқушылар тақырыпқа байланысты тапсырмала орындайды Тақтада марк схема көрсетіледі оқушылар өзін-өзі бағалайды
Бекіту Оқушыларға 2 түрлі деңгейдегі В және С тапсырмалар беріледі (Дифференцация) Тақтада марк схема көрсетіледі жұптар бірін-бірі тексереді
3-тапсырма. ТЕСТ (В деңгей)
1. Генетикалық кодтың үшөрімділігі дегеніміз: A) Бір аминқышқылды бір кодон кодтайды B) Үш нуклеотид бір аминқышқылды кодтайды C) Бір кодон бірнеше аминқышқылды кодтайды D) Кодондар қабаттасады
Дұрыс жауап: B
Тақырып: Генетикалық кодтың қасиеттері: әмбебаптығы, бірін-бірі жаппайтындығы
1-тапсырма. КЛАСТЕР ҚҰРАСТЫРУ (В деңгей)
Тапсырма:
Кластер құрамында болсын:
Бағалау критерийі
Дескриптор
Жауап
2-тапсырма. ТАЛДАУ (С деңгей)
Тапсырма: Бағалау критерийі
Дескриптор
Жауап:
3-тапсырма. ТЕСТ (С деңгей)
1. Генетикалық кодтың бірін-бірі
жаппайтындығы нені білдіреді? Дұрыс жауап:C ҚОРЫТЫНДЫ ДИФФЕРЕНЦИАЦИЯ
Тест тапсырмасы
|
Ppt
https://infourok.ru/sabati-tairibi-genetikali-kod-859005.html
Презентация
Презентация
Презентация
Презентация
Слайд 12
Слайд 14 |
|||||||||||||
|
Сабақтың соңы |
Рефлексия: оқушылар тақырыпқа байланысты:
|
|
|||||||||||||
![]()
5-сабақ ҚМЖ
|
Ұзақ мерзімді жоспар бөлімі: Қоректену |
Мектеп: |
|||||||||||||||||||||||||||||||||||
|
Күні: |
Мұғалімнің аты-жөні: |
|||||||||||||||||||||||||||||||||||
|
Сынып: 11 |
Қатысқандар саны: |
Қатыспағандар саны: |
||||||||||||||||||||||||||||||||||
|
Сабақ тақырыбы |
Хлоропластың құрылымдық компоненттері және олардың қызметтері. Фотосинтездің пигменттері. |
|||||||||||||||||||||||||||||||||||
|
Осы сабақта қол жеткізілетін оқу мақсаттары (оқу бағдарламасына сілтеме) |
хлоропластың құрылымы мен қызметі арасындағы өзара байланысты орнату |
|||||||||||||||||||||||||||||||||||
|
Сабақмақсаттары |
Оқушылар орындай алады: хлоропласттың құрылымын және оның құрамдас бөліктерінің қызметтерімен өзара байланысын сипаттап түсіндіреді. |
|||||||||||||||||||||||||||||||||||
|
Бағалау критерийлері |
|
|||||||||||||||||||||||||||||||||||
|
Адал азамат» біртұтас тәрбие бағдарламасы құндылықтарын енгізу |
Академиялық шыншылдық, нақтылық, өзін өзі реттей білу , ойды реттей білу, сенімділік, дәлелдерді қолдана білу ,өзіне деген сенімділік, өзін-өзі көрсету болу құндылықтары дамытылады. |
|||||||||||||||||||||||||||||||||||
|
Сабақбарысы |
||||||||||||||||||||||||||||||||||||
|
Сабақтыңжоспарланғанкезеңдері |
Сабақтағыжоспарланғаніс-әрекет |
Ресурстар |
||||||||||||||||||||||||||||||||||
|
Сабақтың басы 0-10 мин. |
Ұйымдастыру кезеңі Ынтымақтастық атмосферасын орнату. 1.Хлоропласт құрылымы мен қызметі арасындағы байланысты қалыптстыру мақсатында оқушылардан хлорпласт құрлысы туралы бұрынғы білімдерін қолдана отырып жұпта сипаттама құрасыруды ұсынылады. 2.Өсімдіктегі пигменттер түрлерін атаңыз және олардың құрылыс арасындағы айырмашылықтар қандай? 3.Қандай өсімдіктерде пигмент көбірек кездесуі мүмкін? 4.Каротин, ксантрофилл, хлорофилл а, хлорофилл b, каротиноид пигменттеріне сипаттама беріңіз. Тақырып пен оқыту мақсаты, сабақтың мақсаттары, бағалау критерийлері тұжырымдалады. Жұптық жұмыс тапсырмасы (Алдыңғы білімді қолдану) Тапсырма: Бағыттаушы сұрақтар:
2. Бағалау критерийлері № Критерий Дескриптор 1 Хлорпласт құрылысын сипаттайды Грана, тилакоид, строманы атайды 2 Пигменттерді ажыратады Хлорофилл, каротиноидтарды атайды 3 Салыстырады Айырмашылығын түсіндіреді
3. Кластер (мәтіндік үлгі)ХЛОРПЛАСТ |
РРТ
|
||||||||||||||||||||||||||||||||||
|
11-16 мин.
17-25 мин.
26-37 мин. |
(Ұ) Оқушыларға «хлоропласт» анықтамасына ассоциативті сөздерді тауып, бір-біріне айтады. Сосын оқушыларға бұл органоидтің құрылысы, қызметі мен маңызын өзара байланыстыруы ұсынылады. КБ: мұғалім әр оқушыға көмек көрсетеді. (М)Оқушыларға хлоропласттың электронды суреті көрсетіледі. Мұғалім хлоропластың құрылысы түсіндіреді. Хлоропласттың құрылысы, түрлері оның атқаратын қызметтерімен байланыс жүргізіледі. Фотосинтездің пигменттерімен оқушыларды таныстырылады.
4. Өсімдік пигменттері (кесте)
ҚБ: Келесі, оқушыларға топтық жұмыс ұсынылады (әр топқа тапсырмалар беріледі). Топтық жұмысты бағалау критерийлері (топ атынан бағалау критерийлерді қосуға болады): - нақты ақпарат беру; -қосымша материалдарды пайдалану; -топ мүшелерінің жұмысқа қатысуы; -қорғау уақытын сақтау ... (Т)1 топ оқушылары хлоропластың моделін құрастырады. Ал 2 топ оқушылары хлоропластың суретін салады.
Әр топ бір-бірін бағалау критерийлер арқылы бағалайды. КБ: мұғалім әр топтың жұмысын бағалайды. ҚБ: оқушыларға тапсырмалар таратылады.
Қай өсімдіктерде пигмент көп кездеседі? Пигменттер көп кездеседі:
ТЕСТ ТАПСЫРМАЛАРЫ
III бөлім. Бағалау критерийлері мен дескрипторлар
|
Хлоропласт туралы ақпарат (орыс тілінде) http://biologylib.ru/books/item/f00/s00/z0000009/st189.shtml
Хлоропласттың моделін жасау үшін қажетті құралдары: түсті ермексаз, түсті картон қағаз, қарындаштар, маркерлер. Хлоропласттың моделін жасауы бойынша видео (ағылш.): https://www.youtube.com/watch?v=mwPfTOCxt3w Тапсырмалар |
||||||||||||||||||||||||||||||||||
|
Сабақтың соңы: 38-40 мин. |
Рефлексия Мен сабақта ......................................білдім Бәріненде маған................................ұнады Мен үшін пайдалы ақпарат...........болды Мен ...................................................тілеймін Менің ұсыныстарым........................................ Үйге: хлоропласт туралы ақпарат жасау. |
|
||||||||||||||||||||||||||||||||||
6 -сабақ ҚМЖ
|
Ұзақмерзімдіжоспарбөлімі: |
Қоректену |
||||||||||||||||||||||||||||||||||||||||||||||||||||||
|
Күні |
Мұғалімнің аты-жөні: |
||||||||||||||||||||||||||||||||||||||||||||||||||||||
|
Сынып: 11 |
Қатысқандар саны: |
Қатыспағандар саны: |
|||||||||||||||||||||||||||||||||||||||||||||||||||||
|
Сынып: |
Қатысқандар саны: |
Қатыспағандар саны: |
|||||||||||||||||||||||||||||||||||||||||||||||||||||
|
Сабақ тақырыбы |
Фотосинтездің жарық кезеңі |
||||||||||||||||||||||||||||||||||||||||||||||||||||||
|
Осы сабақта қол жеткізілетін оқу мақсаттары (оқу бағдарламасына сілтеме) |
11.1.2.2 - фотосинтездің жарық кезеңінде өтетін үдерістерді түсіндіру |
||||||||||||||||||||||||||||||||||||||||||||||||||||||
|
Сабақ мақсаттары |
фотосинтездің жарық кезеңінде өтетін үдерістерді түсіндіре алады |
||||||||||||||||||||||||||||||||||||||||||||||||||||||
|
Адал азамат» біртұтас тәрбие бағдарламасы құндылықтарын енгізу |
Академиялық шыншылдық, нақтылық, өзін өзі реттей білу , ойды реттей білу, сенімділік, дәлелдерді қолдана білу ,өзіне деген сенімділік, өзін-өзі көрсету болу құндылықтары дамытылады. |
||||||||||||||||||||||||||||||||||||||||||||||||||||||
|
Сабақ барысы |
|||||||||||||||||||||||||||||||||||||||||||||||||||||||
|
Сабақтың жоспарланған кезеңдері |
Сабақтағы жоспарланған іс-әрекет |
Ресурстар |
|||||||||||||||||||||||||||||||||||||||||||||||||||||
|
Сабақтың басы 0-1 1-3 мин
3-5мин |
1. (К) ұйымдастыру сәті, оқушылардың сабаққа дайындығын тексеру.
«миға шабуылын»жүргізіңіз. Сұрақтар қойыңыз: * Хлоропласт матриксі неден тұрады? * Граннің негізгі функциясын атаңыз? Сабақ тақырыбына оқушылардың жауаптарын берді . |
Үлестірме материал (тест тапсырмалары), MS PowerPoint презентация |
|||||||||||||||||||||||||||||||||||||||||||||||||||||
|
Сабақтың ортасы (пайымдау) 5
|
1.мұғалім оқушылармен келесі сұрақтар бойынша әңгіме өткізеді: 1-тапсырма (ЖЕКЕ ЖҰМЫС) Әдіс: ЖИ көмегімен түсіндіру + ойлау картасы Фотосинтездің жарық фазасында жүретін негізгі үдерістерді түсінуPowerPoint презентация Тапсырма мазмұны: Оқушы ЖИ (ChatGPT, Copilot, Gemini т.б.) көмегімен келесі сұрақтарға жауап алады, содан кейін дәптеріне ойлау картасын (mind map) сызады. «Фотосинтездің жарық фазасында қандай үдерістер жүреді? Оларды ретімен қысқаша түсіндіру Сұрақтар беру * Фотосинтез терминін қалай түсінесіз? * Фотосинтез өнімі не болып табылады? * Фотосинтездеуші ағзалар органикалық заттарды неде түзеді? Сұрақтарды талқылау барысында тақтада мұғалім оқушылардың көмегімен Фотосинтездің жалпы теңдеуін құрайды. Мұғалім слайдта Фотосинтездің жиынтық теңдеуін көрсетеді. Фотосинтездегі үдерістер бір қарағанда неғұрлым күрделі ағымға ие екенін хабарлайды. Дескриптор: фотосинтездің жарық фазасының кемінде 4 үдерісін атайды 1б негізгі терминдерді (фотолиз, АТФ, НАДФН) қолданады2б ақпаратты логикалық байланыспен ұсынады 3б
2-тапсырма (ЖҰПТЫҚ ЖҰМЫС
– Әдіс: Think–Pair–Share + ЖИ-менсалыстыру Циклдікжәнециклдікемесфотофосфорилденудісалыстыру Тапсырма Жұптағыәроқушыәртүрлісұраққояды. 1-оқушы: «Циклдікфотофосфорилденудегенне?» 2-оқушы: «Циклдікемесфотофосфорилденуқалайжүреді?»
Дескриптор:
3-тапсырма (ЖЕКЕ → ЖҰП ) Әдіс: ЖИ көмегімен модельдеу Фотосинтездің жарық фазасын модельдеу Оқушы ЖИ-ге келесі тапсырманы береді: «Фотосинтездің жарық фазасының қарапайым модель сипаттамасын бер»
Содан кейін:
Модельде болуы тиіс:
Жұптық жұмыс: Фотосинтездің жарық фазасының динамикалық моделін құру
Нұсқаулық Келесі реакцияларға назар аударыңыз: • Жарық фазасы: фотолиз, АТФ синтезі. Қосымша НАДФ қалпына келтіру мен тотығуды қарастыруға болады.
Мұғалім оқушыларға екі фотожүйенің жұмыс сызбасын таратады, оқушылар бұл сызбаны бір-біріне түсіндіреді. Талқылау сыныпта. (К) оқушылар Фотосинтездің Жарық фазасы туралы бейнені көреді(5мин 04сек). Талқылау: * АТФ қалай құрылады? * АТФ синтезі, АТФ-синтазаның жұмысы үшін протондар қайдан алынады? Бұл протондар қайда орналасқан? * АТФ қайда босатылады? * НАДФ қалпына келтіру үшін протондар қайдан алынады? * НАДФН қайда босатылады? Оқушылар жұпта бірігіп, қағаз, стикер, стрелкалар арқылы фотосинтездің жарық фазасының динамикалық моделін құрастырады. Төмендегі кесте бойынша модель элементтерін орналастырып, жауаптарын толықтырыңыз.
.Дескриптор:
өз моделін дәлелдеп түсіндіреді Жарық фазалардың негізгі кезеңдерін түсіндіре отырып, анимацияны көрсетіңіз.
мұғалім әр жұпқа
келеді, оқушылардың түсініктерін тыңдайды және кері байланыс
береді. (И,П) оқушылар циклдық және циклдық емес фотофосфорлау туралы материал (оқулықтан үзінділер) алады. Алдымен материалдың бір бөлігімен жеке жұмыс істейді,содан кейін жұпта бұл ақпаратты бір-біріне ауызша түрде береді.
Оқушы ЖИ көмегімен терминдерге анықтама алады, бірақ өз сөзімен жазады.
Дескриптор:
тест тапсырмасы
|
MS PowerPoint презентация MS PowerPoint презентация
MSPowerPoint презентация
Анимацияо фотосинтезе (англ.): https://www.youtube.com/watch?v=prFaSe3s9e0 Бейнежазба 1)https://www.youtube.com/watch?v=pFaBpVoQD4E (на англ яз) 4мин 53сек или 2)https://www.youtube.com/watch?v=GgtflsxIgsg (на рус яз) 4мин 11сек
https://www.youtube.com/watch?v=1-uifqyHm88&list=PLNaLMqSph0LbHyqqZSteoN7a5bpJPjLIH&index=6 (5.04) Циклдық және циклдық емес фотофосфорлау туралы Мәтін, схема. апсырмалар |
|||||||||||||||||||||||||||||||||||||||||||||||||||||
|
Сабақтың соңы (рефлексия) 39-40 мин. |
Үй тапсырмасы Фотосинтездің Жарық фазасы кезінде не болып жатқанын түсіндіре білу.
Мен енді түсіндім
|
|
|||||||||||||||||||||||||||||||||||||||||||||||||||||
7 –сабақ ҚМЖ
|
Ұзақмерзімдіжоспарбөлімі: |
|
|||||||||||||||||||||
|
Күні |
Мұғалімнің аты-жөні: |
|||||||||||||||||||||
|
Сынып: |
Қатысқандар саны: |
Қатыспағандар саны: |
||||||||||||||||||||
|
Сынып: |
Қатысқандар саны: |
Қатыспағандар саны: |
||||||||||||||||||||
|
Сабақ тақырыбы |
Заттар тасымалдануының симпласттық, апопласттық, вакуолярлық жолдары және олардың маңызы |
|||||||||||||||||||||
|
Осы сабақта қол жеткізілетін оқу мақсаттары (оқу бағдарламасына сілтеме) |
11.1.3.2 - заттар тасымалданудың симпласттық, апопласттық, вакуолярлық жолдарының мәнін түсіндіру |
|||||||||||||||||||||
|
Сабақ мақсаттары |
|
|||||||||||||||||||||
|
Адал азамат» біртұтас тәрбие бағдарламасы құндылықтарын енгізу |
Академиялық шыншылдық, нақтылық, өзін өзі реттей білу , ойды реттей білу, сенімділік, дәлелдерді қолдана білу ,өзіне деген сенімділік, өзін-өзі көрсету болу құндылықтары дамытылады. |
|||||||||||||||||||||
|
Сабақ барысы |
||||||||||||||||||||||
|
Сабақтың жоспарланған кезеңдері |
Сабақтағы жоспарланған іс-әрекет |
Ресурстар |
||||||||||||||||||||
|
Сабақтың басы (үндеу)
1-3мин |
Амандасу. I. Ұйымдастыру кезеңі (2 минут)
Әдіс: «Ой
шақыру»
Апопласттық тасымалдау
Әдіс: Түсіндірмелі әңгіме + визуалды
схема
Симпласттық тасымалдау
Әдіс: «Сұрақ–жауап» Мазмұны: Заттар цитоплазма арқылы Плазмодесмалар арқылы бір жасушадан екіншісіне өтеді Мембранадан бір рет өтеді Маңызы: Тасымал реттеледі, таңдамалы вакуолярлық тасымалдау
Әдіс: «Миға
шабуыл» Заттар мембрана → цитоплазма → вакуоль арқылы өтеді
Әр жасушада бірнеше
мембранадан өтеді
Жеке жұмысТапсырма 1. Сәйкестендіру (жеке)
Дұрыс жауап: Дескриптор:Тасымал жолдарын дұрыс сәйкестендіреді – 1 балл Барлық жауап дұрыс – 2 балл
|
MS PowerPoint презентация таратпа материал |
||||||||||||||||||||
|
3-8мин
8-13мин
13-30мин
30-33мин
33-38 мин |
(С) Оқушыларға өсімдік жасушасының суретін дұрыс салуды және құрылысын жазуды тапсырыңыз.
Оқушылар үшін тақтаға өсімдік жасушасының суретін құрылымдық бөліктерімен бірге салыңыз, келесі тақтаға қателіктерін түзете отырып салыңыз. Салған жасуша қабырғасынан Каспари белдемшесін бояп көрсетіңіз және Каспари белдемшесі су жолын бөгейтін өткізбейтін барьер екендігін түсіндіріңіз.
(М) Оқушыларға өсімдік тамырының анатомиялық құрылысын түсіндіріңіз.
Оқушылардан өсімдік жасушалары арқылы қоректік заттардың өтуінің 3 жолын әр түрлі түсті пайдалану арқылы сурет салуды сұраңыз.
(Т)Тасымалдау жолдарының ерекшеліктері туралы кластер құруды ұсыну Бағалау критерийлері: * суретте симпласттық, апопласттық, вакуолярлық су тасымалдау жолдарын белгілейді; * кластерде өсімдіктердегі су тасымалдануының әрбір жолының мәнін көрсету керек. Жұптық жұмыс Тапсырма 2. Салыстырмалы кесте құру
Дұрыс жауап үлгісі Апопласттық – жасуша қабырғасы, мембранадан өтпейді
Дескриптор:
Жұптық жұмыс
Сонымен қоса заттарды тасымалдау жолдарын сіріңке қорапшасына сұйықты қапшықтар салу (вакуольді түсіндіру үшін) арқылы модельдеуге болады.
Бағалау: өзара топтық бағалау Тасымалдау жолдарының атауларын есте сақтау үшін анимация көрсетіледі. Оқушылардан өздеріне берілген жолдарды толық түсіндіруді сұраңыз, мысалы осмос/жеңілдетілген диффузия болса анықтамасын айтуды ұсыныңыз.
Тест тапсырмасы
|
MS PowerPoint презентация Өсімдіктердегі заттардың тасымалы жөнінде теориялық материалдар мен суреттер: 1)http://www.ebio.ru/org12.html 2)http://biologylib.ru/books/item/f00/s00/z0000018/st176.shtml апопласт симпласт вакуолярлық жолдар
Тамырдың құрылысы жөнінде видеоматериал: https://www.youtube.com/watch?v=vbgId5p14EM Судың қозғалысы жөнінде видеоматериал: https://www.youtube.com/watch?v=JFb-CWlz7kE(1мин 20с)
А3, маркерлер Макет үшін (сіріңке қорапшасы, сұйықты қапшықтар)
тасмалдаудың үш жолын да көрсететін интерактивті анимация (өзіңіз қарағыңыз келетінін таңдап алыңыз): http://www.kscience.co.uk/animations/transpiration.htm
|
||||||||||||||||||||
|
Сабақтың соңы (рефлексия) 38-40 мин. |
Үй тапсырмасы Параграф оқу(қажет болған жағдайда презентацияны қайта қарау). Терминдердің анықтамаларын білу. Апопласт, вакуолярлы, симпластты транспорт түрлері.
Рефлексивті экран Әрбір оқушы экрандағы сөздерді бір сөзбен кезегімен жалғастырады. : 1.Мен бүгін білдім… 2.Қызықты болды… 3.Қиын болды… 4.Мен тапсырманы орындадым… 5.Мен түсіндім, келесіні… 6.Енді мен білемін… 7.Мен істейалдым… |
|
||||||||||||||||||||
8 сабақ ҚМЖ
|
Ұзақ мерзімді жоспар бөлімі 11.2 В Басқару және реттеу |
Мектеп : |
||||||||||||||||||||||
|
Күні : |
Мұғалімнің аты-жөні |
||||||||||||||||||||||
|
Сынып: 11 |
Қатысқандар саны: |
Қатыспағаны |
|||||||||||||||||||||
|
Тақырыбы: |
Басқару жүйелері |
||||||||||||||||||||||
|
Осы сабақта орындалатын оқу мақсаттары |
Биологиядағы басқару жүйелері. Биологиядағы «басқару жүйесі» түсінігін қалыптастыру |
|
|||||||||||||||||||||
|
Оқу мақсаты |
Биологиядағы басқару жүйелері |
|
|||||||||||||||||||||
|
Бағалау критерийлері |
1. Гомеостазды анықтайды 2. Биологиядағы басқару жүйесінің негізгі компоненттерін анықтайды; 3. Оң және теріс кері байланыс арасындағы айырмашылықты сипаттайды; 4. Адамдарда глюкоза мен дене температурасының қалай бақыланатынын сипаттайды |
|
|||||||||||||||||||||
|
Адал азамат» біртұтас тәрбие бағдарламасы құндылықтарын енгізу |
Академиялық шыншылдық, нақтылық, өзін өзі реттей білу , ойды реттей білу, сенімділік, дәлелдерді қолдана білу ,өзіне деген сенімділік, өзін-өзі көрсету болу құндылықтары дамытылады. |
|
|||||||||||||||||||||
|
Жоспар |
|
||||||||||||||||||||||
|
Жоспарланған сабақ кезеңдері |
Сабақтағы іс шаралар |
Ресурстар |
|
||||||||||||||||||||
|
Сабақтың басы
Сабақтың ортасы |
Сәлемдесу. "Шаттықшеңбері" коллаборативтіортанықұру» Ой толғау Мұғалім жабық көзімен сурет салуды (кез келген) ұсынады. - Сіздің суретіңіз қаншалықты дәл? Неліктен? Теориялық көпір (мұғалімнің бағыттауы) Негізгі ұғым: Кері байланыс – реттеуіш жүйенің өз қызметінің нәтижесі туралы ақпарат алуы. Мысал: • Қандағы глюкоза ↑ → инсулин бөлінеді → глюкоза ↓ (теріс кері байланыс) Ағзаны тиімді басқару үшін реттеуіштер өз қызметінің нәтижелері туралы үнемі ақпарат алуы тиіс. Мұндай ақпаратты беру кері байланыс деп аталады. "Биологиядағы басқару жүйесі" сабағы. Сабақтың мақсатын бірлесіп анықтау. Білімді өзектендіру – «Миға шабуыл» (3 минут) Сұрақтар: 1. Гомеостаз дегеніміз не? 2. Реттелудің қандай түрлерін білесің? 3. Қандай реттеуші жүйелер бар?
Оқушы жауаптарының үлгісі: • Гомеостаз – ағзаның ішкі ортасының тұрақтылығы • Жүйкелік, гуморальдық (эндокриндік), иммундық реттел Мұғалім оқушыларды 3 топқа біріктіреді (түрлі – түсті жетондар) - материалдың қиындық деңгейі бойынша, ақпарат көзі бойынша дифференциация. Активити 1 Тапсырма: үш реттеуші жүйенің бірінің сызбасын немесе сөздік суретін құрастыру: жүйке, эндокриндік және иммундық. 1 топ – жүйке 2 топ – эндокриндік 3 топ – иммундық (деңгейі жоғары оқушылар, интернет көздерін пайдалана алады).
Топтың тиімді жұмыс істеуі үшін ағзадағы реттелудің негізгі принципі сипатталатын ақпараттық парақтарды үлестіру. Топтарды оқығаннан кейін өз интерпретациясында осы процестің схемасын жасайды. Активити 1. Топтық жұмыс Тапсырма:
1-топ – Жүйкелік реттелу (жауап үлгісі) Тітіркендіргіш → рецептор → сезгіш нейрон → ми/жұлын → қозғалтқыш нейрон → жауап 2-топ – Эндокриндік реттелу (жауап үлгісі) Өзгеріс → эндокриндік без → гормон → қан → нысана-мүше → жауап 3-топ – Иммундық реттелу (жауап үлгісі) Антиген → лейкоциттер → антидене түзілу → бөгде зат жойылады → жады жасушалары Дескрипторлар Жүйке жүйесінің жұмыс схемасы жасалды Эндокриндік жүйенің жұмыс схемасы жасалды Иммундық жүйенің жұмыс схемасы жасалды Проблемалық сұрақ Сұрақ: Дәлелді жауап Бұл жүйелер бір-бірімен тығыз
байланысты.
Қорытынды: ағза – біртұтас басқару жүйе
С. В. Барабановтың реттеу сызбасымен жұмыс
|
|
|
||||||||||||||||||||
|
|
Тапсырма:
Кері байланыс сұрағы:
Жеке тапсырма (үлгі):
«Иммундық реттелудің ағзадағы рөлі» тақырыбында Бағалау дескрипторы:
Жеке тапсырма Реттелу жүйелерін салыстыру, байланысын анықтау. «Үш реттеуші жүйені салыстыратын кестені құрыңдар»
Дескриптор: 1.Салыстыру толық – 2 балл 2.Ұқсастық/айырмашылық көрсетілген – 1 балл 3.Кесте/диаграмма сауатты – 1 балл Жұппен жұмыс Проблемалық сұрақтар Мына проблемалық жағдайды талдаңдар: «Стресс кезінде ағзада қандай реттеуші жүйелер қатар іске қосылады Жауап Жүйке жүйесі – қауіпті сезеді Эндокриндік жүйе – адреналин бөледі Иммундық жүйе – уақытша әлсірейді Бұл жүйелер бір-бірімен келісіп жұмыс істейді
Тест тапсырмасы
|
|
|
|
|||||||||||||||||||
|
|
|
||||||||||||||||||||||
|
38-39 мин |
Рефлексия "2 жұлдыз 1 тілек» |
|
|
||||||||||||||||||||
|
39-40 мин
|
Үй тапсырмасы.
|
|
|
||||||||||||||||||||
|
|
|
||||||||||||||||||||||
9 – сабақ ҚМЖ
|
Бөлім: Координация мен реттеу |
|
|||||||||||||||||||||||||||||||||||||
|
СЫНЫП: 11 |
Қатысушылар саны: |
Келмегендер: |
||||||||||||||||||||||||||||||||||||
|
Сабақтың тақырыбы |
Гормондардың әсер ету
механизмі. |
|||||||||||||||||||||||||||||||||||||
|
Оқыту мақсаттары |
11.1.7.2 - гормондардың әсер ету механизмін түсіндіру |
|||||||||||||||||||||||||||||||||||||
|
Сабақтың мақсаты |
гормондардың әсер ету механизмін түсіндіру |
|||||||||||||||||||||||||||||||||||||
|
Бағалау критерийлері |
- гормондардың қасиеттері мен гормоналды қабылдау түрлерін біледі; - инсулин мен эстрогеннің нысана-жасушаларға әсер ету механизмінің сызбаны жасай алады; - инсулин мен эстрогеннің нысана-жасушаларға әсер ету механизмін (ауызша және жазбаша) сипаттай алады; - инсулин мен эстрогеннің нысана-жасушаларға әсер ету механизмінің ұқсастығы мен айырмашылығын анықтай алады. |
|||||||||||||||||||||||||||||||||||||
|
Сабақ жоспары |
||||||||||||||||||||||||||||||||||||||
|
Сабақта жоспарланған кезеңдер |
Сабақтағы жоспарланған іс-әрекет
|
Ресурстар |
||||||||||||||||||||||||||||||||||||
|
Сабақтың басы
Сабақтың ортасы
|
«AI-сұрақгенераторы» арқылыОй шақыру 0-3 мин
ЖИ көмегімен интерактивті сұрақтар Сұрақтар:
Күтілетін
жауап: 2-кезең. Жаңа білімді меңгеру (интерактивті түсіндіру) 2.1 Гормондардың қасиеттері жеке жұмыс кестені толықтыру
Жеке тапсырма
(ЖИ):
2.2 Гормондардың жасушаға әсер ету механизмдері Жұптық тапсырма
1-жұп: Мембраналық механизм (инсулин) ? 2-жұп: Жасушаішілік механизм (эстроген)
Топтық жұмыс
Зерттеу және түсіндіру Тапсырма: «ЖИ + менталдық карта» Оқушылар инсулин немесе эстроген бойынша менталдық карта жасайды. Міндетті терминдер:
Дескриптор: гормон түрін дұрыс анықтайды әсер ету жолын кезең-кезеңімен көрсетеді терминдерді орынды қолданады топ мүшелерінің барлығы қатысады
Бейнематериалды көріп өзарапікіралмасу Гормонның әрекеті: жасуша сигналы түсіндіріледі
Инсулин және стероидты гормондар механизмі
Жеке жұмыс – Венн диаграммасы Тапсырма: «Инсулин мен эстрогеннің әсер ету механизмдерін салыстыр»
Бағалау дескрипторы:
Жеке жұмыс Тест тапсырмалары
|
Оқу презентациясы 1-15слайд
https://www.youtube.com/watch?v=QoSeNhcAbx4
Слайд 15-17 Қосымша 4 |
||||||||||||||||||||||||||||||||||||
|
Сабақтың соңы Рефлексия 39-40мин
|
Оқушылар бағалау критерийлері бойынша сабақтың мақсатына жетуді талқылайды. Ү/ж: қайталау. |
|
||||||||||||||||||||||||||||||||||||
10-сабақ ҚМЖ
|
Ұзақ мерзімді жоспар бөлімі: 11.2 B Координация және реттелу |
Мектеп: |
|||||||||||||||||||||||||||||
|
Күні: Мұғалім: |
||||||||||||||||||||||||||||||
|
Сынып: 11 |
Қатысқандар саны: Қатыспағандар саны: |
|
||||||||||||||||||||||||||||
|
Сабақ тақырыбы |
Өсіргіш заттар. Өсіргіш заттардың өсімдіктерге әсер ету механизмі. Ауксин әсері. |
|||||||||||||||||||||||||||||
|
Осы сабақта қол жеткізілетін оқу мақсаттары (оқу бағдарламасына сілтеме) |
11.1.7.3 - өсімдіктердің өсуіне стимуляторлардың (өсіргіш заттар) әсер етуін зерттеу |
|||||||||||||||||||||||||||||
|
Сабақ мақсаттары |
Өсімдіктердің өсуіне стимуляторлардың (өсіргіш заттар) әсер етуін зерттеу |
|||||||||||||||||||||||||||||
|
Бағалау критерийлері |
Оқушылар жаңа терминдерге сипаттама береді, өсімдіктердің өсуіне өсіргіш заттардың әсерінің механизмін түсіндіреді. Оқушылар өсімдіктерге гормондардың әсерін сипаттайды және түсіндіреді. |
|||||||||||||||||||||||||||||
|
Бастапқы білім |
Жүйке жасушасы, ұлпа, жүйке жүйесі: 7-10 сыныптар. Эндокринді жүйе: 7-10 сыныптар. |
|||||||||||||||||||||||||||||
|
Сабақ барысы |
||||||||||||||||||||||||||||||
|
Сабақтың жоспарланған кезеңдері |
Сабақтағы жоспарланған іс-әрекет |
Ресурстар |
||||||||||||||||||||||||||||
|
Сабақтың басы 1-5 мин
5-10 мин
Сабақтың ортасы
10-15
|
1.Өткен тақырыптың өзектілігі. «Сәйкестендіру»Тапсырма (жұптық):
|
|||||||||||||||||||||||||||||
|
Гормон |
Қызметі |
|
1. Ауксин |
A. Жапырақтың түсуін тежейді |
|
2. Цитокинин |
B. Жасушаның созылуын күшейтеді |
|
3. Этилен |
C. Қартаюды баяулатады |
|
4. Абсциз қышқылы |
D. Жапырақ түсуін тездетеді |
Дұрыс
жауабы:
1–B, 2–C, 3–A, 4–D
Дескриптор:
-
гормон мен қызметін дұрыс сәйкестендіреді – 1 б
-
ЖИ берген түсіндірмені қысқаша жазады – 1 б
-
биологиялық терминдерді қолданады – 1 б
Проблемалық сұрақ
Жеке жұмыс
Сұрақ:
«Егер өсімдікте ауксин
мүлде түзілмесе, қандай өзгерістер болар
еді?»
Оқушы ЖИ-ден 3
болжам алып, соның
ішінен ең ғылыми
негізделгенін таңдайды.
Мүмкін болатын жауап:
-
Өсімдік бойы аласа болады
-
Жасушалар созылмайды
-
Тропизмдер байқалмайды
Дескриптор:
-
кемінде 2 ғылыми дәлел келтіреді – 2 б
-
себеп–салдар байланысын көрсетеді – 1 б
Сабақ мақсатын қалыптастыру (Жұптық)
Тапсырма::
«Өсімдік гормондары
тақырыбына SMART форматында сабақ мақсатын құрастыр»
жауап:
Өсімдік гормондарының түрлерін анықтап, олардың өсу мен дамудағы рөлін түсіндіру.
Дескриптор:
-
мақсат нақты – 1 б
-
өлшенетін – 1 б
-
тақырыпқа сай – 1 б
Мұғалім түсіндірмесі + визуал тапсырма
Өсіргіш заттар. Өсіргіш заттардың өсімдіктерге әсер ету механизмі. Ауксин әсері
Мұғалім сабақтың негізгі тірек терминдерін түсіндіреді. Сонымен қатар өсімдіктің өсуіндегі және дамуындағы ауксиннің ролін түсіндіреді. Оқушылар дәптерге ауксиннің өсімдік жасушаларына әсерінің суретін салу қажет.
Оқу таныстырылымы
презентация
15-25 мин
25-35 мин
35-38 мин
4.Мұғалім түсіндірмесі. Өсіргіш заттар. Өсіргіш заттардың өсімдіктерге әсер ету механизмі. Ауксин әсері
Мұғалім сабақтың негізгі тірек терминдерін түсіндіреді. Сонымен қатар өсімдіктің өсуіндегі және дамуындағы ауксиннің ролін түсіндіреді. Оқушылар дәптерге ауксиннің өсімдік жасушаларына әсерінің суретін салу қажет.



Жеке жұмыс:
Оқушы дәптерге:
-
өсімдік жасушасын
-
ауксиннің біржақты жиналуын
-
жасушаның созылуын
сызба түрінде салады.
Дескриптор:
-
суретте гормон бағыты көрсетілген – 1 б
-
жасуша созылуы белгіленген – 1 б
Топтық жұмыс (зерттеу)
«Гормон + өмірлік жағдай»
|
Топ |
Гормон |
сұрақ |
|
1 |
Цитокинин |
Қартаюға қалай әсер етеді? |
|
2 |
Гиббереллин |
Сабақтың өсуін қалай арттырады? |
|
3 |
Абсциз қышқылы |
Стресте неге маңызды? |
|
4 |
Этилен |
Жемістің пісуін қалай реттейді? |
Постерде болуы керек:
-
гормонның қызметі
-
нақты мысал
-
схема / сурет
Дескриптор:
-
ғылыми дәлдік – 2 б
-
көрнекілік – 1 б
-
түсіндіру сапасы – 1 б
Қорғау кезіндегі тыңдаушыларға тапсырма (Жеке)
Тапсырма:
Әр топтан 1 жаңа факт жаз немесе мини-сызба сал.
Дескриптор:
4 гормон бойынша ақпарат жазылған – 2 б
қысқа әрі нақты – 1 б
да әртүрлі өсімдік гормондарын зерттеу қажет.
7. «Шындық/Жалған»
Оқушылар өз жетістіктерін «Шындық/Жалған» тапсырмасы арқылы тексере алады.
(Өзін-өзі бағалау)
|
Тұжырым |
Ш/Ж |
|
Ауксин жасушаның созылуын арттырады |
Ш |
|
Этилен – газ тәрізді гормон |
Ш |
|
Абсциз қышқылы өсу стимуляторы |
Ж |
|
Цитокинин қартаюды баяулатады |
Ш |
Дұрыс
жауаптар:
Ш, Ш, Ж, Ш
Тест тапсырмасы

Қосымша 1
Маркерлер, А3 форматындағы қағаздар, ноутбуктер
Қосымша 2
Сабақтың соңы
38-40
Кері байланыс:
Мұғалім сабақ мақсатына оралып, критерийлердің орындалу деңгейін талқылайды. Оқушылар сабақ барысында жақсы іске асқан немесе қиындық туғызған мәселелерді анықтайды.
стикерлер
11 сабақҚМЖ
|
Бөлім: |
11.2 Көбею |
|
Педагогтің аты-жөні: |
|
|
Күні: |
|
|
Сыныбы: |
Қатысушылар саны: Қатыспағандар саны: |
|
Сабақтың тақырыбы: |
Гаметогенез.Адам гаметогенезінің сатылары |
|
Оқу бағдарламасына сәйкес оқу мақсаты |
11.2.1.1 - адам гаметогенезінің сызбасын талдау |
|
Сабақтың мақсаты: |
Адам гаметогенезінің сызбасын талдап үйренеді. |
|
Адал азамат» біртұтас тәрбие бағдарламасы құндылықтарын енгізу |
Академиялық шыншылдық, нақтылық, өзін өзі реттей білу , ойды реттей білу, сенімділік, дәлелдерді қолдана білу ,өзіне деген сенімділік, өзін-өзі көрсету болу құндылықтары дамытылады. |
Сабақтың барысы:
|
Сабақ кезеңі/Уақыты |
Педагогтің іс-әрекеті |
Ресурстар |
||||||||||||||||||||
|
Сабақтың басы Қызығушылықты ояту. |
(Ұ). Ұйымдастыру кезеңі: 1. Оқушылармен амандасу, түгендеу. .Қызығушылықты ояту (ЖИ + визуал әдіс)
Проблемалық сұрақ Неліктен сперматогенез бен овогенез нәтижесінде түзілетін гаметалардың саны мен құрылысы әртүрлі? Оқушылар өз болжамдарын айтады (ауызша, ой шақыру). |
Оқулық, жұмыс дәптері Кітап, дәптер, қалам суреттері бейнеленген қима қағаздар топтамасы (Қазіргі жағдайда) ДК экраны |
||||||||||||||||||||
|
Жаңа сабаққа кіріспе
|
ЖИ көмегімен интерактивті түсіндіру Мұғалім гаметогенездің дайын сызбасын көрсетіп, ЖИ арқылы:
|
Өз ойын дұрыс мағынада білдіріп, талқылауға белсенділікпен қатысқан оқушыға «Жарайсың!» деген мадақтау сөзімен ынталандыру. |
||||||||||||||||||||
|
Сабақтың ортасы Мағынаны ашу. 26 мин. |
ЖЕКЕ ТАПСЫРМА (деңгейлік) 1-тапсырма. «Сызбаны талда» Берілген сызба бойынша кестені толтыр.
Дескриптор:
|
Тапсырма бойынша интернет құралдарын пайдаланып видео көру |
||||||||||||||||||||
|
|
ЖҰПТЫҚ ТАПСЫРМА 2-тапсырма. Венн диаграммасы Сперматогенез бен овогенезді салыстыр Ортақ белгілері:
Айырмашылықтары:
Дескриптор: КЕСТЕМЕНЖҰМЫС 3-тапсырма. Толықтыр
Дескриптор:
|
ДК экраны 11-сынып оқулығы. Жұмыс дәптерлері.
Бейнежазба презентация |
||||||||||||||||||||
|
|
Тест тапсырмалары
|
ДК экраны 11-сынып оқулығы. Жұмыс дәптерлері. |
||||||||||||||||||||
|
Сабақтың соңы Ой толғаныс. Рефлексия
|
Кері байланыс: Мұғалім сабақ мақсатына оралып, критерийлердің орындалу деңгейін талқылайды. Оқушылар сабақ барысында жақсы іске асқан немесе қиындық туғызған мәселелерді анықтайды |
|
11- ҚМЖ
|
Бөлім 11.2С Өсу және даму |
Мектеп: |
||||||||||||||||||
|
Күні: |
Мұғалімнің аты-жөні: |
||||||||||||||||||
|
Сыныбы:11 |
Қатысушылар саны: |
Қатыспағандар: |
|||||||||||||||||
|
Сабақ тақырыбы |
Бағаналы жасушалар ұғымы және олардың қасиеттері (қайта жаңаруы, жіктелуі). |
||||||||||||||||||
|
Осысабақтақолжеткізілетіноқумақсаттары (оқубағдарламасынасілтеме) |
11.2.3.1 - бағаналы жасушалардың мамандану үдерісін және олардың практикалық қолданылуын түсіндіру |
||||||||||||||||||
|
Сабақ мақсаты |
Оқушылар: Сабақ барысында бағаналы жасушалар ұғымы мен олардың жаңаруы мен жіктеліуін танып біледі. |
||||||||||||||||||
|
Бағалау критерийлері |
|
||||||||||||||||||
|
Сабақ барысы |
|||||||||||||||||||
|
Сабақтың жоспарланған кезеңдері |
Сабақтағы жоспарланған іс-әрекет
|
Ресурстар |
|||||||||||||||||
|
Сабақтың басы 5минут |
Ой-қозғау: Адам денесінде эритроциттер шамамен 100—120 күн аралығында өмір сүреді, кейін тіршіліктері макрофагтарды арқасында жойылады. Бірақ, адамның қанында үнемі жаңа эритроциттер үнемі пайда болады.
Оқушылармен бірлесе ой қозғау арқылы, бүгінгі сабақтың тақырыбы, оқыту мақсаты және сабақ мақсаттары талқыланады. |
Презентация Слайд 3 |
|||||||||||||||||
|
Сабақтың ортасы |
I. Жеке жұмысТапсырма 1. «Ақылды түсіндірме»
Нұсқау:
Формат: 5–6 сөйлем, тірек сөздермен Дескриптор:
|
Ақпарат парақшасы |
|||||||||||||||||
|
|
I. Жұптық жұмыс Тапсырма 2. «Сәйкестендіру + мысал»
Дескриптор:
|
|
|||||||||||||||||
|
|
Тапсырма 3. «Диалогтық түсіндіру»
Нұсқау: «Неге плюрипотентті жасушалар барлық ұлпаны түзбейді?» Дескриптор:
I. Топтық жұмыс (күрделі, ойлау дағдысы жоғары) Тапсырма 4. «Видео + Талдау» Нұсқау:
Презентация құрылымы (5 слайд):
Дескриптор:
Тапсырма 5. «Проблемалық жағдай»
Жағдай: Қандай типті бағаналы жасуша тиімді? Неліктен? Дескриптор:
Тест тапсырмалары
|
«Сornel» әдісі негізіндегі жұмыс парағы 1,2
YouTube «Stem cell differentiation» |
|||||||||||||||||
|
Сабақтың соңы
|
Рефлексиямұғалімнің сұрақ қоюы негізінде жүзеге асады:
Үй тапсырмасы: рефератдайындау |
|
|||||||||||||||||
13 сабақ ҚМЖ
|
11.2С Өсу және даму |
|
||||||||||||||||||||||||||||||||||
|
Күні: |
Мұғалім: |
||||||||||||||||||||||||||||||||||
|
Сыныбы |
қатысушылар саны: |
қатыспаушылар саны: |
|||||||||||||||||||||||||||||||||
|
Сабақ тақырыбы |
Бағаналы жасушалардың түрлері: эмбрионалды және соматикалық |
||||||||||||||||||||||||||||||||||
|
Сабақтажүзеге асырылатын оқу мақсаты |
11.2.3.1 бағаналы жасушалардың мамандану үдерісін және олардың практикалық қолданылуын түсіндіру |
||||||||||||||||||||||||||||||||||
|
Сабақ мақсаттары |
* бағаналы жасушалардың түрлерінсипаттау; * бағаналы жасушалардың түрлерінсалыстыру. |
||||||||||||||||||||||||||||||||||
|
Бағалау критерийлері |
- бағаналы жасушалардың сипаттамаларын көрсетеді; - бағаналы жасушалардың ұқсастығы мен айырмашылықтарын сипаттайды. |
||||||||||||||||||||||||||||||||||
|
Адал азамат» біртұтас тәрбие бағдарламасы құндылықтарын енгізу |
Академиялық шыншылдық, нақтылық, өзін өзі реттей білу , ойды реттей білу, сенімділік, дәлелдерді қолдана білу ,өзіне деген сенімділік, өзін-өзі көрсету болу құндылықтары дамытылады. |
||||||||||||||||||||||||||||||||||
|
Сабақ жоспары |
|||||||||||||||||||||||||||||||||||
|
Сабақтың кезеңдері |
Сабақта орындалуы тиіс іс -әрекеттер |
Оқыту ресурстары |
|||||||||||||||||||||||||||||||||
|
0-10 |
1. Топтық жұмыс (жоғары деңгей – талдау, синтез) ? Тапсырма: «AI + Видео + Талдау»
Мұғалім ЖИ көмегімен
дайындалған 2–3 минуттық ғылыми
видеоны көрсетеді
Топтарға бөліну:
Орындау:
Дескриптор:
2. Жұптық жұмыс (салыстыру, логикалық ойлау) Тапсырма: «Салыстырмалы кесте + AI» Жұпта AI көмегімен төмендегі кестені толтырыңдар:
Дескриптор:
3. Жеке жұмыс (ойлау дағдысы – бағалау) Тапсырма: «Ғылыми пікір» Сұрақ: Неліктен соматикалық бағаналы жасушалар медицинада этикалық тұрғыдан жиі қолданылады? Жауапты AI-мен тексеріп, жетілдіреді. Дескриптор:
Шығармашылық тапсырма (жоғары деңгей) Тапсырма: «AI-инфографика / презентация»
AI (Canva, Gamma) көмегімен 5 слайдтық презентация жаса:
Дескриптор:
10 ТЕСТ ТАПСЫРМАСЫ
|
презентация Stem cells: types and differentiation видео ғылыми
ChatGPT / Copilot – ақпаратты талдау, салыстыру, сұрақ құрастыру AI video generator (Pictory, Canva AI) – ғылымибейнероликқарау AI презентация (Gamma, Canva) – инфографикаменжұмыс
|
|||||||||||||||||||||||||||||||||
|
35 - 40 |
Рефлексия «551» |
|
|||||||||||||||||||||||||||||||||
14-15 сабақ ҚМЖ
|
Тұқым қуалаушылық және өзгергіштік заңдылықтары |
|
|||
|
Тақырыбы: |
ДНҚ-ның кездейсоқ мутациясы ,генетикалық үдеріс қателіктері,репликация.ДНҚ-ның кездейсоқ мутациясы,репарация,репкомбинация |
|||
|
Күні: |
Мұғалімнің аты-жөні: |
|||
|
Сынып: 11 |
Қатысушылар саны: |
Қатыспағандар: |
||
|
Осы сабақ арқылы жүзеге асырылатын оқу мақсаттары |
Мутацияның ДНҚ репарациясымен, ДНҚ рекомбинациясымен, сонымен қатар ДНҚ репликациясымен байланысын табу |
|||
|
Бағалау критерийлері |
Оқушы оқу мақсатына жетеді, егер; Мутациия, ДНК репарациясын, ДНК рекомбинациясын, ДНК репликациясын біледі және түсінеді. Мутацииямен кем дегенде бір ДНК репарациясын, ДНК рекомбинациясын, ДНК репликациясы арасындағы байланысты сипаттайды. |
|||
|
Адал азамат» біртұтас тәрбие бағдарламасы құндылықтарын енгізу |
Академиялық шыншылдық, нақтылық, өзін өзі реттей білу , ойды реттей білу, сенімділік, дәлелдерді қолдана білу ,өзіне деген сенімділік, өзін-өзі көрсету болу құндылықтары дамытылады. |
|||
|
Сабақ барысы |
||||
|
Сабақ қезеңдері |
Жоспарланғаніс-әрекеттер |
Оқыту көздері мен ресурстар |
||
|
0-7 минут |
Ұйымдастыру кезеңі. Қызығушылықты ояту (10 минут) Проблемалық сұрақ: «Егер жасушада қателіктерді түзететін механизмдер болмаса, тірі ағзалар қандай күйге түсер еді?»
Күрделібейне (5 мин):
ЖИқолдану:
«Бұлбейнедемутацияныңқайкезеңдепайдаболуқаупіжоғары?» Топқа бөлу: |
Презентация
DNA replication errors and repair mechanisms» (молекулалықдеңгейдеанимация) |
||
|
Сабақтың Басы Сабақтың ортасы
|
Жаңабілімдімеңгеру (20 минут) Мұғалімніңтүсіндірмесі + презентация
Негізгібайланыс: Егеррепликациякезіндеқатекетіп, репарацияонытүзетпесе → мутациясақталады Топтықжұмыс (20 минут) Тапсырма: «Генетикалықбайланыскартасы» Бұл топ оқушылары мейлінше интернет көзімен жұмыс жасап,берілген тапсырма бойынша ақпаратттар жинақтап, слайд жасайды. Оқушыларға ұсынылатын материалдар:
ДНҚ репарациясының негізгі қасиеттері Әр топ:
Дескриптор:
Жұптық жұмыс (15 минут) Тапсырма: «Себеп–салдар» Берілген жағдаятты талдау: «Репликация кезінде тиминнің орнына гуанин жалғанды. Репарация жүйесі істен шықты. Қандай нәтиже болады?» Жауапты:
Дескриптор:
VI. Жеке жұмыс (10 минут) «3–2–1» әдісі
Тест тапсырмалары
|
https://www.youtube.com/watch?v=vNXFk_d6y80
https://www.youtube.com/watch?v=-jjCjdvJTSw
https://www.youtube.com/watch?v=vNXFk_d6y80 Қосымша 1 Кестелер, суреттер, сызбанұсқалар
|
||
|
|
||||
|
87-90 минут |
Кері байланыс. «Пирамида» Үйге тапсырма беру:Мутацияның ДНҚ репарациясымен, ДНҚ рекомбинациясымен, сонымен қатар ДНҚ репликациясымен өзара байланысын өз сөздерімен баяндама дайындау |
|
||
16 сабақ ҚМЖ
|
|
Мектеп: |
|||||||||||||
|
Күні: |
Мұғалімніңаты-жөні: |
|||||||||||||
|
Сынып: 11 |
Қатысқандарсаны:Қатыспағандарсаны: |
|||||||||||||
|
Сабақтақырыбы:Адам геномдық ДНК- ын секвенерлеу |
||||||||||||||
|
Осы сабақта қол жеткізілетін оқу мақсаттары |
11.2.4.3- «Адам геномы» жобасының маңызын талдау |
|||||||||||||
|
Сабақмақсаттары |
«Адам геномы» жобасы аясында жүргізілген зерттеулердің маңызы |
|||||||||||||
|
Жетістік критерийлері |
|
|||||||||||||
|
Адал азамат» біртұтас тәрбие бағдарламасы құндылықтарын енгізу |
Академиялық шыншылдық, нақтылық, өзін өзі реттей білу , ойды реттей білу, сенімділік, дәлелдерді қолдана білу ,өзіне деген сенімділік, өзін-өзі көрсету болу құндылықтары дамытылады. |
|||||||||||||
|
Сабақбарысы |
||||||||||||||
|
Сабақтың Жоспарлан-ған кезеңдері |
Сабақтағыжоспарланғаніс-әрекет |
Ресурстар |
||||||||||||
|
Сабақтыңбасы 3 мин. |
І. Ұйымдастыру кезеңі. Қызығушылықты ояту – проблемалық видео Видео:Human Genome Project Explained (3–4 мин) Проблемалық сұрақтар:
Жеке ойлану – 1 мин, жұпта талқылау – 3 мин, ортақ жауап – 3 мин
|
Видео:Human Genome Project Explained |
||||||||||||
|
Сабақтың ортасы |
ІІ. Жаңа тақырып. Мұғалім түсіндірмесі: Таратпа материал
Мұғалімнің қысқаша түсіндірмесі + презентация Негізгі мазмұн:
Бейнебаян. DNA sequencing – 3D III. Топка бірігу. Оқушыларды 3 топқа бөлу: 1-топ: Секвенерлеу технологиялары 2-топ: «Адам геномы» жобасының кезеңдері 3-топ: Геномдық зерттеулердің қолданылуы |
Презентация https://present5.com/dnk-sekvenirleu-disi%D3%99-dnk-sekvenirleu-%D3%99disi/ |
||||||||||||
|
|
-Тапсырма. Топтық жұмыс
Тапсырма: Бағыттар:
Дескриптор:
2-Тапсырма. Жұптық аналитикалық тапсырма (10 мин)
Тапсырма:
Дескриптор:
3-Тапсырма. Жеке жұмыс – ЖИ қолдану
Тапсырма: Дескриптор:
4-Тапсырма. Сыни ойлау (Think–Why–Future) (5 мин)Сұрақ:
қысқа аргумент (3–4 сөйлем) Тест (бірдұрысжауап)
|
ЖИ құралымен – ChatGPT, Canva, Gamma)
|
||||||||||||
|
Рефлексия
1мин |
Рефлексия «3–2–1» әдісі
Үй тапсырмасы
«Геномды секвенерлеудің этикалық мәселелері» тақырыбында мини-эссе (200 сөз) немесе 1 слайдтық презентация (инфографика)
|
|
||||||||||||
17 сабақ Қмж
Микробиологиялық зерттеудің кезеңдері
|
Ұзақ мерзімді жоспар бөлімі:
|
Мектеп: |
|||||||||||||||||
|
Күні: |
Мұғалім: |
|||||||||||||||||
|
Сынып: 11 |
Қатысушылар саны: |
Қатыспағаны: |
||||||||||||||||
|
Сабақ тақырыбы |
Микробиологиялық зерттеудің кезеңдері |
|||||||||||||||||
|
Осы сабақ арқылы жүзеге асырылатын оқу мақсаттары |
микробиологиялық зерттеу кезеңдерін сипаттау және түсіндіру |
|||||||||||||||||
|
Сабақтың мақсаттары |
Оқушылар: -микробиологиялық зерттеулерде қолданылатын қоректік ортаның түрлі түрлерін анықтайды -оларды дайындай алады |
|||||||||||||||||
|
Бағалау критерийі |
Оқушылар: қоректік ортаның әр түрлерін жасай біледі |
|||||||||||||||||
|
Адал азамат» біртұтас тәрбие бағдарламасы құндылықтарын енгізу |
Академиялық шыншылдық, нақтылық, өзін өзі реттей білу , ойды реттей білу, сенімділік, дәлелдерді қолдана білу ,өзіне деген сенімділік, өзін-өзі көрсету болу құндылықтары дамытылады. |
|||||||||||||||||
|
Сабақ барысы |
||||||||||||||||||
|
Сабақтың жоспарланған кезеңдері |
Жоспарланған іс-әрекеттер |
Ресурстар |
||||||||||||||||
|
Сабақтың басы 0-5 мин |
Ұйымдастырукезеңі (2 мин) Қызығушылықтыояту (5 мин) – ЖИ + бейне
Жаңабілімдімеңгеру (10 мин)Мұғалімніңқысқашатүсіндірмесі + презентацияМикробиологиялық зерттеу кезеңдері:
Қоректік орталардың түрлері:
Микробиологиялық зерттеу қалай жүргізіледі?» (2–3 мин) Талқылау сұрақтары (Think–Pair–Share):
|
кесте |
||||||||||||||||
|
Сабақтың ортасы 6-11 мин 12-30 мин 31-35 мин |
Топтық жұмыс (10 мин) – ЖИ қолданысымен 1-тапсырма (4 топ) кезекті ресурстар таратылады оқушыларға қоректік орта түрлері және олардың тағайындалуы туралы біледі деп сұрайды Содан кейін кейбір негізгі ақпаратты енгізеді: * қоректік орта: микроорганизмдердің өсуі үшін дайындалған қоректік заттар * стерильді: тірі микробтар жоқ * инокулят: микробтарды ортаға енгізу. * Мәдениет: Мәдени ортада өсетін микробтар * синтетикалық тасушылар * синтетикалық тасушы анықталған * күрделі орта Агар: * Кешенді полисахарид * Петри тостағандарында, көлбеу және тереңдете қоректік орта үшін қатайтқыш ретінде қолданылады • * Әдетте микробтармен метаболизденбейді * 100 ° C кезінде ыдырайды • 40 ° C Қатайтады
Тапсырма:
Дескриптор:
Барлығы: 4 балл
Жұптық жұмыс (8 мин) 2-тапсырма: «Салыстыр»
Тапсырма:
Дескриптор:
Жеке жұмыс (5 мин) 3-тапсырма: «Ойлан, жаз»
Сұрақ: Дескриптор:
ЖИ қолдану – күрделі тапсырма
Тапсырма: Бағалау:
ТЕСТ тапсырмасы
|
https://microbeonline.com/types-of-bacteriological-culture-medium/
https://www.slideshare.net/HiwrHastear/types-of-culture-media
|
||||||||||||||||
|
Сабақ соңы 36-40 мин |
Рефлексия Менің ойымша… Өйткені … Мен оны мысалда дәлелдеуге болады... Осыған орай, Мен бұл ...
ЖИ көмегімен «Қазіргі медицинадағы микробиологиялық зерттеулер» тақырыбында 5 слайдтық мини-презентация жасау |
|
||||||||||||||||
18 сабақ ҚМЖ
|
Ұзақ мерзімді жоспар бөлімі:: 11.3D Биотехнология |
Мектеп: |
||||
|
Мерзімі: |
Мұғалім: |
||||
|
Сынып: 11 |
Қатысқандар саны:
|
Қатыспағандар саны: |
|||
|
Сабақ тақырыбы: |
Зертханалық жұмыс: "Әртүрлі қоректік ортада қышқыл сүт өнімдерінің микрофлорасын зерттеу". |
||||
|
Осысабақтақолжеткізілетіноқумақсаттары (оқубағдарламасынасілтеме) |
11.4.3.1 микробиологиялық зерттеудің кезеңдерін сипаттау және түсіндіру |
||||
|
Сабақ мақсаттары |
|
||||
|
Бағалау критерийлері |
Оқушылар оқу мақсатына жетеді,егер олар:
|
||||
|
Адал азамат» біртұтас тәрбие бағдарламасы құндылықтарын енгізу |
Академиялық шыншылдық, нақтылық, өзін өзі реттей білу , ойды реттей білу, сенімділік, дәлелдерді қолдана білу ,өзіне деген сенімділік, өзін-өзі көрсету болу құндылықтары дамытылады. |
||||
|
Сабақ барысы |
|||||
|
Сабақтың жоспарланған кезеңдері |
Сабақтағы жоспарланған іс-әрекет
|
Ресурстар |
|||
|
Сабақтың басталуы 2 мин 4 мин |
Ұйымдастыру Интерактивтісұрақ (Mentimeter / Kahoot): «Қышқылсүтөнімдерінегеұзақсақталады?» II. Қызығушылықтыояту – Видео (5 мин)
Қысқағылымивидео:
ЖИқолдану:
Қоректік орталар туралы қысқаша теория
Сұйық қоректік орта
Қатты қоректік орта
Микробиологиялық зерттеудің негізгі кезеңдері Зерттеу объектісін таңдау (айран, йогурт, қымыз) Қоректік ортаны дайындау (сұйық/қатты) Стерильдеу Үлгіні егу Инкубациялау Бақылау, микроскопия Нәтижені тіркеу және талдау |
PPT ЗЖ парақтары
«Lactic acid bacteria – how they
work?» |
|||
|
Сабақтың ортасы 10 мин 3 мин |
Жаңа білімді меңгеру (10 мин) – Топтық жұмыс 1-топ: Сұйық қоректік орта 2-топ: Қатты қоректік орта 3-топ: Қышқыл сүт өнімдерінің микрофлорасы Тапсырма:
Дескриптор:
Зертханалық жұмыс (15 мин) – Жұптық жұмыс
Зертханалық тапсырма
Жұмыс парағы
Дескриптор:
Талдау және ойлау дағдысы (Жеке жұмыс – 8 мин) ЖИ көмегімен тапсырма «Егер қышқыл сүт өнімінде бөгде бактерия көбейсе, не болады?» Дескриптор:
тест тапсырмасы
|
Canva, PowerPoint, ЖИ сурет генераторы |
|||
|
Сабақтың соңы 2 мин |
Рефлексия 1. Бүгін сабақта неге үйрендім? 2. Мен ең жақсы не істедім? 3. Едім жақсартты өз жұмысында келесі жолы? Үй тапсырмасы: ЗЖ оқыңыз + жұмыс парақтарының сұрақтарына жауап береңіз |
Стикерлер |
|||
19 –сабақ ҚМЖ
|
Бөлім: |
11.3 Биотехнология |
|
Педагогтің аты-жөні: |
|
|
Күні: |
|
|
Сыныбы:11а |
Қатысушылар саны: Қатыспағандар саны: |
|
Сабақтың тақырыбы: |
Грамм оң және грамм теріс бактериялар және олардың құрылысерекшеліктері. |
|
Оқу бағдарламасына сәйкес оқу мақсаты |
11.4.3.2 -грамм оң және грамм теріс бактерияларды зерттеу |
|
Сабақтың мақсаты: |
грамм оң және грамм теріс бактерияларды зерттей алады |
|
Адал азамат» біртұтас тәрбие бағдарламасы құндылықтарын енгізу |
Академиялық шыншылдық, нақтылық, өзін өзі реттей білу , ойды реттей білу, сенімділік, дәлелдерді қолдана білу ,өзіне деген сенімділік, өзін-өзі көрсету болу құндылықтары дамытылады. |
Сабақтың барысы:
|
Сабақ кезеңі/Уақыты |
Сабақтағыіс-әрекет Бағалау |
Ресурстар |
||||||
|
Сабақтың басы Қызығушылықты ояту |
(Ұ). Ұйымдастыру кезеңі: 1.Оқушылармен амандасу, түгендеу. Сынып реттілігін қадағалау. |
|||||||
|
Жаңа сабаққа кіріспе |
(Ұ) «Миға шабуыл» Бейнематериал (3–4 мин)
Тақырып: (YouTube: 3D анимация, микроскопиялық салыстыру)
«Қай бактерия қабырғасы қалың, қайсысы жұқа? Неліктен |
Gram-positive vs Gram-negative Bacteria (cell wall structure animation) (YouTube: 3D анимация, микроскопиялық салыстыру |
||||||
|
Сабақтың ортасы Мағынаны ашу. |
Мағынаны ашу Топтық жұмыс (Structure Mapping)
Тапсырма:
Дескриптор:
|
презентация |
||||||
|
|
Жұптықжұмыс – Салыстыру (Higher Order Thinking) Венн диаграммасы
Дескриптор:
|
ДК экраны 11-сынып оқулығы. Жұмыс дәптерлері. |
||||||
|
|
||||||||
|
|
Тапсырмалар айдарындағы -тапсырманы орындатады, бақылайды, мысал, үлгі көрсетеді. Жеке жұмыс– ЖИ көмегімен талдау
AI Prompt
(оқушыға): «Грамтеріс бактериялардың антибиотикке төзімді болу себебін түсіндір» Дескриптор:
Бекіту – Презентация + ойлау тапсырмаларыПрезентация слайдтары:
Ойлау дағдысы (Себеп–салдар):Сұрақ: Егер грамтеріс бактерияда сыртқы мембра Тест тапсырмалары
|
ДК экраны 11-сынып оқулығы. Жұмыс дәптерлері. |
||||||
|
Сабақтың соңы Ой толғаныс. Рефлексия
|
«3–2–1» әдісі:
|
|
||||||
20-сабақ ҚМЖ
|
САБАҚ: |
|
||||||||||||
|
Күні: |
Мұғалімнің аты-жөні: |
||||||||||||
|
Сыныбы:11 |
Қатысушылар саны: |
Қатыспағандар: |
|||||||||||
|
Сабақ тақырыбы |
Рекомбинатты ДНҚ алу тәсілдері |
||||||||||||
|
Осысабақтақолжеткізілетіноқумақсаттары (оқубағдарламасынасілтеме) |
Оқушыларорындайалады: 11.4.3.2- рекомбинанттыДНҚалутәсілдерінтүсіндіру |
||||||||||||
|
Сабақ мақсаты |
Оқушылар: Рекомбинатты ДНҚ ұғымымен танысады Рекомбинантты ДНҚ –ын алу тәсілін біледі Сызбалармен жұмыс жасай алады Рекомбинатты ДНҚ –ны алу тәсілдерін түсіндіре алады |
||||||||||||
|
Адал азамат» біртұтас тәрбие бағдарламасы құндылықтарын енгізу |
Академиялық шыншылдық, нақтылық, өзін өзі реттей білу , ойды реттей білу, сенімділік, дәлелдерді қолдана білу ,өзіне деген сенімділік, өзін-өзі көрсету болу құндылықтары дамытылады. |
||||||||||||
|
Сабақ барысы |
|||||||||||||
|
Сабақтың жоспарланған кезеңдері |
Сабақтағы жоспарланған іс-әрекет
|
Ресурстар |
|||||||||||
|
Сабақтың басы 0-5 минут 5-10 мин |
Ой-қозғау: Қызығушылықты ояту (5 мин) Проблемалық сұрақ (сыни ойлау): «Адам инсулині бактерия арқылы қалай өндіріледі деп ойлайсың?» ЖИ қолдану:
ДНҚ ға тән қандай қасиеттер бар? ДНҚ ның екі еселенуі қалай жүзеге асатын еді? Мұғалімнің түсіндірмесі: Слайд № 3 Тақтаға Рекамбинантты ДНҚ алу жолы туралы сызба көрсетіледі.
Гендердің көптеген бірдей көшірмелерін алу клондау деп аталады. Көшірмеге негіз болатын генді векторлы ген деп атайды және оларды плазмидалардан немесе бактериофагтардан алады. Плазмидалар – прокариоттарға тән сақина тәрізді ДНҚ бөлігі және ол ДНҚ-дан тыс репликацияланады. Бактериофагтар (немесе фагтар) – бұлар бактерия жасушасына өз ДНҚ-ын енгізіп репликациялайтын вирустар. Клондауға арналған ДНҚ фрагменттерін фаг немесе плазмида денесіне енгізеді. Алынған «қоспаны» рекомбинантты ДНҚ деп айтады. .
|
Мұғалімнің түсіндірмесі толығымен Қосымша №1 Дарынды оқушылар үшін қосымша ақпарат Қосымша №2 Анимация https://www.dnalc.org/content/c15/15929/insulin_yeast.swf http://www.glynwalton.co.uk/SWFs_files/biotech_medicines_1-4.swf http://highered.mheducation.com/sites/dl/free/0072421975/196644/cloning_gene.swf видео: |
|||||||||||
|
Сабақтың ортасы 10-30 мин 30-35 мин 35-38 мин |
Мағынаны тану: Оқушыларды шағын 3 топқа бөлу. «Мозайка» әдісі арқылы топтарға бөлінеді Топтарға тапсырма: Әр топ рекомбинантты ДНҚ –ның бір тәсіліне зерттеу жүргізеді Бағалау критерийі:
1 топ – жабысқақ ұштар әдісі 2 топ – гомополимерлі ұштар әдісі 3 топ – доғал ұштарды жалғау(тігу) әдісі Мақсатты тұжырымдау: Түрлі терминдер мен суреттер берілген карточкалар беріледі. Оқушылар толық рекомбинантты ДНҚ ның жасалу тәсілінің стандартты сызбасын құрастырады. Әр кезеңге қажетті терминдер мен суреттер бір топ болады. Топтар жасалу реттілігі бойынша орналасады. Әр топ келесі топқа осы тақырып бойынша негізгі деп тапқан екі термин сөздің анықтамасын және оның қызметін немесе қасиетін айтуларын сұрайды. Бекіту тапсырмасы: «Мұғалімнен 3 минуттық 3 сұрақ» Оқушыларға жеке жұмыс беріледі Мұғалім ауызша жауабын айтады, «Карусель» әдісі арқылы оқушылар өздерін тексереді. Жұптық жұмыс
Тапсырма:
Дескриптор:
Жеке жұмыс (сыни ойлау) Тапсырма: «Рекомбинантты ДНҚ қолданудың медицинадағы маңызын түсіндір» Дескриптор:
V. ЖИ қолдану
AI
тапсырмасы: «Рекомбинантты ДНҚ алу процесін 5 қадаммен қысқаша сипатта» (талқылау, салыстыру)
|
Интернет ресурстар, тапсырмалармен карточкалар
Топтық жұмыс үшін оқу материалы Қосымша №1,2
Қажетті сызбалар мен суреттер
Қосымша №3 |
|||||||||||
|
Сабақтың соңы
38-40 мин |
Рефлексиямұғалімнің сұрақ қоюы негізінде жүзеге асады:
|
|
|||||||||||
21-сабақ ҚМЖ
|
Ұзақ мерзімді жоспар бөлімі: Биотехнология |
Биотехнология |
|||||||
|
Күні: |
Мұғалімнің аты-жөні: |
|||||||
|
Сынып: |
Қатысқандар саны: Қатыспағандар саны: |
|
||||||
|
Сабақ тақырыбы |
Плазмиданың қасиеті және оларды гентикалық клондауда қолданылуы |
|||||||
|
Осы сабақта қол жеткізілетін оқу мақсаттары (оқу бағдарламасына сілтеме) |
|
|||||||
|
Сабақ мақсаттары |
Рекомбинатты ДНҚ алу тәсілдерін толыққанды түсінеді |
|||||||
|
Адал азамат» біртұтас тәрбие бағдарламасы құндылықтарын енгізу |
Академиялық шыншылдық, нақтылық, өзін өзі реттей білу , ойды реттей білу, сенімділік, дәлелдерді қолдана білу ,өзіне деген сенімділік, өзін-өзі көрсету болу құндылықтары дамытылады. |
|||||||
|
Сабақ барысы |
||||||||
|
Сабақтың жоспарланған кезеңдері |
Сабақтағы жоспарланған іс-әрекет |
Ресурстар |
||||||
|
Сабақтың басы 0-5 |
Ұйымдастыру кезеңі (2 мин)
Қызығушылықты ояту – Видео + ЖИ (5 мин)
Видео: RecombinantDNAtechnology (3–4 мин, анимация) «Рекомбинантты ДНҚ қалай алынады? Қарапайым тілмен түсіндір |
сурет Презентация видео |
||||||
|
Сабақтың ортасы |
Мұғалім түсіндірмесі Гендердің көптеген бірдей көшірмелерін алу клондау деп аталады. Көшірмеге негіз болатын генді векторлы ген деп атайды және оларды плазмидалардан немесе бактериофагтардан алады. Плазмидалар – ДНҚ-ның сақина тәрізді фрагменттері, олар кейбір бактерияларда кездеседі және ДНҚ-дан тыс репликацияланады. Бактериофагтар (немесе фагтар) – бұлар бактерия жасушасына өз ДНҚ-ын енгізіп репликациялайтын вирустар. Клондауға арналған ДНҚ фрагменттерін фаг немесе плазмида денесіне енгізеді. Алынған «қоспаны» рекомбинантты ДНҚ деп айтады. . Топтық жұмыс (10 мин) 1-тапсырма. «Сызбаны сөйлет» (Топтық) Берілген сызба бойынша рекомбинантты ДНҚ алу кезеңдерін түсіндіріңіз:
Дескриптор:
Рекомбинанттық ДНҚ-ның осылай қолданылуын түсіндіретін модель дайындауларын сұрау. (8 логикалық қадам + 3 сызбалық көрсету) I. 8 ЛОГИКАЛЫҚ ҚАДАМ (модель мазмұны) 1-қадам. Қажетті генді таңдау Мысалы: адам инсулині гені 2-қадам. Генді бөліп алу Рестриктаза ферменті адам ДНҚ-сынан генді кесіп алады 3-қадам. Плазмиданы алу Бактериядан плазмида (сақиналы ДНҚ) бөлінеді 4-қадам. Плазмиданы кесу Сол рестриктаза плазмиданы да кеседі 5-қадам. Генді плазмидаға енгізу Лигаза
ферменті ген мен плазмиданы
біріктіреді 6-қадам. Бактерияға енгізу Рекомбинанттық плазмида
бактерия жасушасына енгізіледі 7-қадам. Клондау (көбею) Бактериялар көбейеді → ген де көбейеді 8-қадам. Дайын өнім алу Бактерия инсулин / фермент / вакцина өндіреді II. 3 СЫЗБАЛЫҚ КӨРСЕТУ 1-СЫЗБА. Генді алу Адам ДНҚ ──✂ (рестриктаза)──► Қажетті ген 2-СЫЗБА. Рекомбинанттық плазмида Плазмида ──✂──► + Қажетті ген ↓ (лигаза) Рекомбинанттық плазмида 3-СЫЗБА. Қолданылуы Рекомбинанттық плазмида ↓ Бактерия ↓ Дайын өнім (инсулин) V. Жұптық жұмыс 2-тапсырма. «Салыстыр» Плазмида мен хромосомалық ДНҚ-ны салыстырыңыз
Дескриптор:
Жеке жұмыс 3-тапсырма. Жоғары деңгейлі ойлау Сұрақ: Егер плазмида болмаса, генетикалық клондау қалай өзгерер еді? Дескриптор: 1.себеп-салдар байланысын көрсетеді – 1 б 2.ғылыми негіз келтіреді – 1 б Бекіту – Тест тапсырмалары
|
Microsoft PowerPoint презентациясы
Анимация https://www.dnalc.org/content/c15/15929/insulin_yeast.swf
http://www.glynwalton.co.uk/SWFs_files/biotech_medicines_1-4.swf
http://highered.mheducation.com/sites/dl/free/0072421975/196644/cloning_gene.swf
|
||||||
|
Сабақтың соңы 35-40 |
Рефлексия (3 мин) «3–2–1» әдісі:
|
Стикер |
||||||
22-сабақ ҚМЖ
|
Ұзақ мерзімді жоспар бөлімі: |
Биомедицина және биоинформатика |
|||||||||||||||||||||||||
|
Күні: |
Мұғалім: |
|||||||||||||||||||||||||
|
Сынып: 11 (Жаратылыстану-математика бағытында) |
Қатысқандар: |
Қатыспағандар: |
||||||||||||||||||||||||
|
Сабақ тақырыбы: |
Электромагниттік және дыбыс толқындарының адам ағзасына әсері |
|||||||||||||||||||||||||
|
Осы сабақта қол жеткізілетін оқу мақсаттары (оқу бағдарламасына сілтеме) |
12.4.5.3 - электромагниттік және дыбыс толқындарының адам ағзасына әсерін түсіндіру |
|||||||||||||||||||||||||
|
Сабақ мақсаттары |
|
|||||||||||||||||||||||||
|
|
|
|||||||||||||||||||||||||
|
Сабақ барысы |
||||||||||||||||||||||||||
|
Сабақтың жоспарланған кезеңдері |
Сабақтағы жоспарланған іс-әрекет |
Ақпарат көзі |
||||||||||||||||||||||||
|
Сабақтың басы 0-2 3-5 |
. Ұйымдастыру кезеңі
ІІ. Қызығушылықты ояту Кіріспе видео (2–3 мин):
|
Power Point presentation Slide пайдалысілтеме сергіту сәтіне арналған https://www.youtube.com/watch?v=kOkv8ynpppk |
||||||||||||||||||||||||
|
Сабақтың ортасы 6-15 |
Мағынаны ашу
1Дыбыс
толқындарының адам ағзасына әсері Сурет/слайд: Құлақ құрылысы Өту жолы:
Әсері:
2️⃣ Электромагниттік толқындардың әсері
Кесте/слайд:
3 Адам жүйелеріне әсері Жүйке жүйесі:
Гуморалды жүйе:
Иммунды жүйе:
Қанайналым жүйесі:
IV. Тапсырмалар (15 мин) 1-тапсырма. Жұптық жұмыс
Тапсырма: Дескриптор:
2-тапсырма. Топтық жұмыс (Зерттеу)
Тақырыптар: ЖИ қолдану: ChatGPT – ғылыми түсіндірме, инфографика жасау Дескриптор:
3-тапсырма. Жеке жұмыс (Сыни ойлау)
Сұрақ: Дескриптор:
V. Бекіту. Тест тапсырмалары
|
Қосымша 2
Қосымша 3
|
||||||||||||||||||||||||
|
Сабақтың соңы 39-40
|
Бізге айтыныз. Активити Оқушылар сабақтың негізгі идеясын түсіндіретін дыбыс (jingle) жазады
Үй жұмысы: Оқушыларға «ЭМ толқындарының пайда болуы және оның зияны» тақырыбында қысқаша эссе жазу тапсырмасын беріңіз. |
|
||||||||||||||||||||||||
24-сабақ ҚМЖ
|
Тарау; 1.3Биомедицина және биоинформатика |
Мектеп: |
||||
|
Күні: |
Мұғалімнің аты-жөні: |
||||
|
Сыныбы: 11 |
Қатысушылар саны: |
Қатыспағандар: |
|||
|
Сабақ тақырыбы |
«Биоинформатика» ұғымы. Биоинформатикақұралдарын зерттеулерге қолдану |
||||
|
Осысабақтақолжеткізілетіноқумақсаттары (оқубағдарламасынасілтеме) |
11.4.4.3 – биоинформатика ролін түсіндіру |
||||
|
Сабақ мақсаты |
|
||||
|
Бағалау критерийлері |
|
||||
|
Алдыңғы білімдер: |
Биотехнология маңызы, бөлімдері |
||||
|
Сабақ барысы |
|||||
|
Сабақтың жоспарланған кезеңдері |
Сабақтағы жоспарланған іс-әрекет
|
Ресурстар
|
|||
|
Сабақтың басы 3минут 20минут Сабақтың ортасы 17 минут |
. Ұйымдастыру кезеңі (2 мин)Психологиялық ахуал «Геном – бұл ақпарат. Ақпаратты кім талдайды?» – сұрағы арқылы тақырыпқа жетелеу II. Қызығушылықты ояту (5 мин) – ЖҰПТЫҚ ЖҰМЫС Видео 1
Тақырыбы:What
is Bioinformatics? Тапсырма:
Дескриптор:
III. Жаңа білімді меңгеру (15 мин)Мұғалім түсіндірмесіБиоинформатика –
биологиялық деректерді (ДНҚ, РНҚ, ақуыз, геном)
СУРЕТ
1
|
Биоинформатика как дисциплина https://www.youtube.com/watch?v=IE8PRZrU7XI&list=PLh6dVTO7f4FazIQHrdOT1W0N1yMPRlzwEhttps://www.youtube.com/watch?v=IE8PRZrU7XI&list=PLh6dVTO7f4FazIQHrdOT1W0N1yMPRlzwE Презентация Қосымша 1, 2 ) / видеоролик Структурная биоинформатика https://www.youtube.com/watch?v=PlYov5sXNKw&list=PLh6dVTO7f4FazIQHrdOT1W0N1yMPRlzwE&index=7 Ноутбук, қағаз А3, маркерлер, түсті қарындаштар Қосымша 3 Қағаз А2, маркерлер, түсті қарындаштар, клей |
|||
|
Сабақ соңы 3 минут |
V. Рефлексия«3–2–1» әдісі
Үй тапсырмасы: «Биоинформатиканың қазіргі заманғы мүмкіншіліктері»атты тақырыпқа постер дайындау |
Стикерлер |
|||
25 сабақ-ҚМЖ
|
Ұзақ мерзімді жоспар бөлімі: Көбею |
Көбею |
|||||||||||||
|
Күні |
Мұғалімніңаты-жөні: |
|||||||||||||
|
Сынып:11 |
Қатысқандарсаны: |
Қатыспағандар саны: |
||||||||||||
|
Сабақтақырыбы |
Экстракорпоралды ұрықтандыру әдісі және оның маңызы |
|||||||||||||
|
Осысабақтақолжеткізілетіноқумақсаттары (оқубағдарламасынасілтеме) |
11.4.4.4-Экстракорпоралдық ұрықтандыру әдісінің мәнін түсіндіру |
|||||||||||||
|
Сабақ мақсаттары |
ЭКҰқолданылуыменмаңызынтүсіндіру |
|||||||||||||
|
Бағалау критерийлері |
ЭКҰ әдісінің мәнісін сипаттап, түсіндіреді. Экстракорпоралды ұрықтандырудың маңызын сипаттайды
|
|||||||||||||
|
Адал азамат» біртұтас тәрбие бағдарламасы құндылықтарын енгізу |
Академиялық шыншылдық, нақтылық, өзін өзі реттей білу , ойды реттей білу, сенімділік, дәлелдерді қолдана білу ,өзіне деген сенімділік, өзін-өзі көрсету болу құндылықтары дамытылады. |
|||||||||||||
|
Сабақ барысы |
||||||||||||||
|
Сабақтың жоспарланған кезеңдері |
Сабақтағы жоспарланған іс-әрекет |
Ресурстар |
||||||||||||
|
Сабақтың басы
|
Ұйымдастыру кезеңі (2 мин)
II. Қызығушылықты ояту (5 мин) Видео қарау Тақырып:» Сұрақтар (жеке жұмыс):
➡ЖИ
қолдану: |
Презентация видео "Процедура IVF" |
||||||||||||
|
Сабақтың ортасы 11-36 минут
|
Экстракорпоралды ұрықтандыру (ЭКҰ) дегеніміз: Аналық жасуша мен сперматозоидтың ағзадан тыс (in vitro) жағдайда ұрықтандырылып, кейін эмбрионның жатыр қуысына енгізілуі. ЭКҰ негізгі кезеңдері презентация
Топтық жұмыс 1-топ: «ЭКҰ қолданылу себептері»
2-топ: «ЭКҰ маңызы»
3-топ: «ЭКҰ-ның артықшылықтары мен шектеулері» 4-топ: «ЭКҰ және биоэтика»
Дескрипторлар:
Жұптық жұмыс «Салыстыр» әдісі Табиғи ұрықтану vs ЭКҰ
➡ЖауаптыЖИарқылытексеру (қателерінанықтау)
VI. Жекежұмыс «Ойлан – жауапбер»
Сұрақ: Дескриптор:
Тест тапсырмалары
|
видео "Процедура IVF" https://www.youtube.com/watch?v=KSrTfxhLb8o https://www.youtube.com/watch?v=uXsCngh89fI
|
||||||||||||
|
Сабақтың соңы 37-40 |
Рефлексия мұғалімнің сұрақтарына негізделеді: 1. Сіз қай кезеңде қиындық көрдіңіз? 2. Келесі сабақта мұғалімнен сізге қандай көмек қажет болуы мүмкін? Немесе Синквейн түрінде өткізуге болады |
|
||||||||||||
Сабақ 26 ҚМЖ
|
Бөлім 11.4 А Биомедицина және биоинформатика |
Мектеп: |
|||||
|
Күні: |
Мұғалімнің аты-жөні: |
|||||
|
Сыныбы:11 |
Қатысушылар саны: |
Қатыспағандар: |
||||
|
Сабақ тақырыбы |
Экстракорпоральды ұрықтандырудың этикалық аспектілері. |
|||||
|
Осысабақтақолжеткізілетіноқумақсаттары (оқубағдарламасынасілтеме) |
Оқушыларорындайалады: 11.4.4.3 - экстракорпоральдыұрықтандыру (ЭКҰ) әдісініңмаңызынтүсіндіру |
|||||
|
Сабақ мақсаты |
Оқушылар сабақта: ЭКҰ маңыздылығын және этикалық аспектілерін анықтауды үйренеді. |
|||||
|
Бағалау критерийлері |
Бағалау критерийлері:
|
|||||
|
Адал азамат» біртұтас тәрбие бағдарламасы құндылықтарын енгізу |
Академиялық шыншылдық, нақтылық, өзін өзі реттей білу , ойды реттей білу, сенімділік, дәлелдерді қолдана білу ,өзіне деген сенімділік, өзін-өзі көрсету болу құндылықтары дамытылады. |
|||||
|
Сабақ барысы |
||||||
|
Сабақтың жоспарланған кезеңдері |
Сабақтағы жоспарланған іс-әрекет |
Ресурстар |
||||
|
Сабақтың басы 5 минут |
Ұйымдастыру кезеңі (2 мин)
Қызығушылықты ояту (Жеке жұмыс, 5 мин) Видео көру Тапсырма: бейнені көріп, сұрақтарға жауап беру
Дескриптор:
|
|
||||
|
Сабақтың ортасы |
Жаңа білімді меңгеруМұғалім түсіндірмесі:
эмбрион тағдыры донорлық генетикалық іріктеу дін мен қоғам көзқарасы IV. Топтық жұмыс (10 мин) 1-топ: ЭКҰ-ның маңыздылығы 2-топ: ЭКҰ-ны қолдайтын этикалық дәлелдер 3-топ: ЭКҰ-ға қарсы этикалық көзқарастар Тапсырма: постер дайындау (Canva / қағаз)
Дескриптор:
V. Жұптық жұмыс (Сыни ойлау, 7 мин)
«Иә / Қарсы» дебат кестесі
Дескриптор:
VI. Жеке жұмыс (ЖИ қолдану, 5 мин) AI тапсырма
Тапсырма: Дескриптор:
Тест тапсырмалары
|
ЭҰҚныңэтикалықа спектісі |
||||
|
Сабақтың соңы 3 минут |
К «Нысана» әдісі бойынша. |
|
||||
27 сабақ ҚМЖ
|
Бөлім:11.3D Биотехнология |
Мектеп:Әл-Фарабиатындағыбейіндікмектеп |
||||
|
Күні: |
Мұғалім:МанаеваБ.Б. |
||||
|
Сынып: |
Қатысқандарсаны: |
Қатыспағандарсаны: |
|||
|
Сабақтақырыбы |
Моноклоналдыантиденелердіқолдануарқылыаурулардыдиагностикалау және емдеу |
||||
|
Осы сабақта қол жеткізілетін оқу мақсаттары |
11.4.4.4аурулардыдиагностикалауменемдеудемоноклоналды антиденелердің қолданылуын түсіндіру |
||||
|
Сабақ мақсаттары |
|
||||
|
|
|
||||
|
Сабақтыңбарысы |
|||||
|
Сабақтыңжоспарлан ған кезеңдері |
Сабақтағыжоспарланғаніс-әрекет |
Ресурстар |
|||
|
Сабақтыңбасы 0-5мин.
Сабақтың ортасы
Сабақтың соңы
|
Қызығушылықты ояту– Жұптық жұмыс Видео көруСұрақтар
?Дескриптор:
Моноклоналды антиденелер қалай түзіледі? Гибридома әдісі:
Нәтиже: бір ғана антигенге дәл әсер ететін антидене
Диагностикадағы рөлі
3️ Емдеудегі рөлі
Топтық жұмыс 1-топ: «Құрылу механизмі»
Сурет бойынша кезеңдерді реттеп, түсіндіру 2-топ: «Диагностика» Нақты ауру + қандай тест + антидене рөлі 3-топ: «Емдеу» Белгілі препарат (мыс: Трастузумаб) – әсері
4-топ: «ЖИ және болашақ»
ЖИ моноклоналды антиденелерді жасауда қалай көмектеседі? Дескриптор:
ғылыми термин қолданады Жеке жұмыс Сыни ойлау Эссе (5–6 сөйлем): «Моноклоналды антиденелер – болашақ медицинасының негізі ме?» Дескриптор:
ТЕСТ
«3–2–1» әдісі:
Үйге тапсырма «Моноклоналды
антиденелер және онкология» тақырыбына
инфографика |
Power Point таныстырылымы
1 қосымша (сәйкестендіру тапсырмасы)
https://www.youtube.com/watch?v=uuT08OT3wTc– “How to produce monoclonal antibody” анимация
ноутбук 4 қосымша (A-levelпрактикалық сұрақтары)
Стикер Қосымша сілтеме https://www.youtube.com/
|
|||
|
|
|
|
|||
28 сабақ ҚМЖ
|
САБАҚ: |
|
|||
|
Күні: |
Мұғалімнің аты-жөні: |
|||
|
Сыныбы:11 |
Қатысушылар саны: |
Қатыспағандар: |
||
|
Сабақ тақырыбы |
Харди-Вайнберг генетикалық тепе-теңдік заңы.Сирек кездесетін және жойылып бара жатқан өсімдіктер мен жануарлардың түрлерін қорғау |
|||
|
Осысабақтақолжеткізілетіноқумақсаттары (оқубағдарламасынасілтеме) |
Оқушыларорындайалады: Экожүйенің алуан түрлілігі мен тұрақтылығы арасындағы өзара байланысты орнату |
|||
|
Сабақ мақсаты |
экожүйенің алуан түрлілігі мен тұрақтылығы арасындағы өзара байланысты орнату |
|||
|
Бағалау критерийлері |
Оқушылар орындай алады:
|
|||
|
Адал азамат» біртұтас тәрбие бағдарламасы құндылықтарын енгізу |
Академиялық шыншылдық, нақтылық, өзін өзі реттей білу , ойды реттей білу, сенімділік, дәлелдерді қолдана білу ,өзіне деген сенімділік, өзін-өзі көрсету болу құндылықтары дамытылады. |
|||
|
Сабақ барысы |
||||
|
Сабақтың жоспарланған кезеңдері |
Сабақтағы жоспарланған іс-әрекет |
Ресурстар |
||
|
Сабақтың басы |
Оқушылармен сәлемдесу Қызығушылықты ояту
Видео (2–3
мин): Ой қозғау сұрақтары (жұптық жұмыс):
Жаңа білімді меңгеру (10 мин) Презентация мазмұны:
p2+2pq+q2=1p^2 + 2pq + q^2 = 1p2+2pq+q2=1
Топтық жұмыс
Тапсырма: 1-топ – Қар барысы
2-топ – Қызғалдақтың сирек түрі
3-топ – Ақбөкен
Сұрақтар:
Дескрипторлар:
Жұптық жұмыс
Есеп
шығару:
Дескрипторлар:
Жекежұмыс Сыни ойлау тапсырмасы: «Неліктен сирек түрлерді қорғауда тек санын көбейту жеткіліксіз?» Дескрипторлар:
Есептер шығару
q2=98/200 =0,49q=0,49=0,7p=1−q=1−0,7=0,3 2pq=2⋅0,3⋅0,7=0,42Жауабы:Гетерозиготалар жиілігі: 42%2. Тышқандарда сұр аң терісіне қарағанда қоңыр түсі басымдылық көрсетеді. Егер сізде 200 тышқанның 168 қоңыр тышқандар болса Гомозиготалы доминанттардың,гетерозиготалары және гомозиготалы рецессивтіліктің болжамды жиілігі қандай? Гомозиготалы доминантты (p²): q2=200/32=0,16q=0,4p=0,6 Гетерозиготалы (2pq): p2=0,36⇒36%2pq=2⋅0,6⋅0,4=0,48⇒48% Гомозиготалы рецессивті (q²): 0,16⇒16%
10 ТЕСТ ТАПСЫРМАСЫ
|
Презентация, Суреттер |
||
|
39-40 минут |
Үйге тапсырма: Презентацияны оқу және Харди-Вайнберг заңына тапсырмалар жинақтау РЕФЛЕКСИЯ: 1. Жұмыстың қай кезеңінде сіз қиындықтарға тап болдыңыз? 2. Келесі сабақта мұғалімнен сізге қандай көмек қажет болуы мүмкін? |
|||
29 сабақ ҚМЖ
|
Ұзақ мерзімді жоспар бөлімі: |
11.4АБиосфера, экожүйе, популяция |
||||||||||||||||||||||||||||||||||||||||||||
|
Күні: |
Мұғалімнің аты-жөні: |
||||||||||||||||||||||||||||||||||||||||||||
|
Сынып: |
Қатысқандар саны: |
Қатыспағандар саны: |
|||||||||||||||||||||||||||||||||||||||||||
|
Сабақ тақырыбы |
Экологиялық жағдайлар мен экологиялық есептер шешу |
||||||||||||||||||||||||||||||||||||||||||||
|
Осы сабақта қол жеткізілетін оқу мақсаттары (оқу бағдарламасына сілтеме) |
11.3.1.2 - экожүйелердегі трофикалық деңгейлердің сызбасын құрастыру |
||||||||||||||||||||||||||||||||||||||||||||
|
Сабақ мақсаттары |
Оқушылар:
|
||||||||||||||||||||||||||||||||||||||||||||
|
Жетістік критерийлері |
|
||||||||||||||||||||||||||||||||||||||||||||
|
Адал азамат» біртұтас тәрбие бағдарламасы құндылықтарын енгізу |
Академиялық шыншылдық, нақтылық, өзін өзі реттей білу , ойды реттей білу, сенімділік, дәлелдерді қолдана білу ,өзіне деген сенімділік, өзін-өзі көрсету болу құндылықтары дамытылады. |
||||||||||||||||||||||||||||||||||||||||||||
|
Сабақ барысы |
|||||||||||||||||||||||||||||||||||||||||||||
|
Сабақтың жоспарланған кезеңдері |
Сабақтағы жоспарланған іс-әрекет |
Ресурстар |
|||||||||||||||||||||||||||||||||||||||||||
|
Сабақтың басы |
.Қызығушылықтыояту – ВИДЕОВидеоұсыныс:
“Energyflowinecosystems” Мұғалім сұрақтары:
Ойлау дағдысы: Талдау, себеп-салдар |
Презентация MS PowerPoint Слайд 1 Қосымша 1 (диктовкалық белсенділікті айқайлауға арналған бос орындары бар мәтін) Слайд 2-4 |
|||||||||||||||||||||||||||||||||||||||||||
|
Сабақтың ортасы |
Жұптық жұмыс – Энергия берілу сызбасы Әдіс: Think–Pair–Share Тапсырма: Берілген мәлімет: Продуцент – 15 000 кДж Жұппен:
Формула:Тиімділік=Алдыңғы деңгей/Келесі деңгей×100 Дескриптор:
Жеке жұмыс – Экологиялық есептер Есеп 1 Жыртқышта 80 кДж энергия бар. Жауабы: Есеп 2 Егер I консумент жойылса, экожүйеде қандай өзгеріс болады? Жауабы:
Дескриптор:
ЖИ қолдану (5 мин) Тапсырма: ChatGPT немесе басқа ЖИ арқылы: «Орман экожүйесінің трофикалық деңгейлерінің сандық моделін құрастыр» Нәтиже: Сандық дерек Энергия пирамидасы ➡ XXI ғасыр дағдысы: цифрлық сауаттылық ЗЕРТТЕУЖҰМЫСТАРЫ Жұптық тапсырма: Қоректік желі диаграммасын талдау Мақсаты: Оқушылар қоректік желінің құрылымын түсінеді, байланыстарды анықтайды. Орындау:
Дескриптор:
2 Жұптық тапсырма: Қоректік желі бойынша мәлімдемелер жасау Мақсаты: Оқушылар қоректік желі бойынша логикалық қорытындылар жасайды Орындау:
Дескриптор:
3️ Өзара бағалау Мақсаты: Көршінің жұмысын талдау, сыни ойлау дағдысын дамыту Орындау:
Дескриптор:
4. Жеке тапсырма: Жұмыс парағын толтыру Мақсаты: Экологиялық есептер мен өткен Кембридж емтихан тапсырмаларын шешу Орындау:
Дескриптор:
5️ Мұғаліммен кері байланыс Мақсаты: Тақырып бойынша негізгі идеялар мен қорытындыларды талдау Орындау:
Дескриптор:
ТЕСТ 1. Продуценттерге жатады:
A) Қасқыр 2. Энергияның негізгі көзі:
A) Су 3. 10% ережесі нені білдіреді?
A) Энергия толық өтеді 4. Қоректік тізбектің соңында:
A) Продуцент 5. 1 000 кДж → келесі деңгейде:
A) 1 000 6. II реттік консумент:
A) Шөп 7. Қайсысы энергия пирамидасына тән?
A) Кеңейеді 8. Экожүйе тұрақтылығы тәуелді:
A) Бір түрге 9. Энергия жоғалуы себебі:
A) Фотосинтез 10. Қоректік желі дегеніміз:
A) Бір тізбек
|
Презентация MS PowerPoint Слайд 5 Қосымша 2 (қоректік желілер суреттері бар үлестірме материал) Слайд 6 Қосымша 3 және 4 (студенттің жұмыс парағы, жауаптар)
Ұсынылған бейне фильм: 1)https://www.youtube.com/watch?v=VfhgthqiGgY(ағылшын тілін)
2)https://www.youtube.com/watch?v=9R5nMvkZrC8 (ағылшын тілін)
3)https://www.youtube.com/watch?v=wx9Ku_R-Zqo(ағылшын тілін)
|
|||||||||||||||||||||||||||||||||||||||||||
|
Сабақтың соңы 39-40 мин |
Үй жұмысы. Эссежазу 250сөз - Рефлексия. Ең қызығы не болды? Ең тиімдісі не болды? Мен әлі түсінбеймін ... |
|
|||||||||||||||||||||||||||||||||||||||||||
30 сабақ ҚМЖ
|
Ұзақ мерзімді жоспар бөлімі: Бөлім 11.4А Биосфера, экожүйе, популяция |
11.4А Биосфера, экожүйе, популяция |
||||||||||||||||||||||||||||
|
Күні: |
Мұғалімнің аты-жөні: |
||||||||||||||||||||||||||||
|
Сынып: |
Қатысқандар саны: Қатыспағандар саны: |
|
|||||||||||||||||||||||||||
|
Сабақтақырыбы:Жергілікті экожүйенің биоәртүрлілігін анықтауда кездейсоқ іріктеудің мәні. |
|||||||||||||||||||||||||||||
|
Осысабақтақолжеткізілетіноқумақсаттары (оқубағдарламасынасілтеме) |
өз аймақтың экожүйесін статистикалық талдау әдістерін (Стьюденттің t-критерийі, χ2-критерий) мысал келтіре отырып, есептерді қадам бойынша шығарады |
||||||||||||||||||||||||||||
|
Сабақ мақсаттары |
• Экологиялық зерттеулердегі статистиканы салыстырып, мысал ретінде есептер шығарады |
||||||||||||||||||||||||||||
|
Бағалау критерийлері |
Оқушы оқу мақсатына қол жеткізді, егер ол: • t - тестстатистикалық әдісіне мысал келтіріп, гипотезалар қойып, қадам бойынша есеп шығарады • хи квадраты статистикалық әдісіне мысал келтіріп, гипотезалар қойып, қадам бойынша есеп шығарады |
||||||||||||||||||||||||||||
|
Бастапқы білім |
Жергілікті экожүйенің организмдерінің саны мен таралуын анықтауда әртүрлі статистикалық әдістерді қолдану – Бірінші және екінші сабақтар |
||||||||||||||||||||||||||||
|
Сабақ барысы |
|||||||||||||||||||||||||||||
|
Сабақтың жоспарланған кезеңдері |
Сабақтағы жоспарланған іс-әрекет |
Ресурстар |
|||||||||||||||||||||||||||
|
Сабақтың басы 3 мин 5 мин |
Сабақ тақырыбы мен мақсаттарын хабарлау
Оқушыларды 3 топқа
бөлу: 2-топ – χ², 3-топ – Аналитиктер (ЖИ) II. ҚЫЗЫҒУШЫЛЫҚТЫ ОЯТУВидео көру (3 минут)Тақырып: Видео мазмұны: ЖИ арқылы жануарларды санау Кездейсоқ іріктеу не үшін қажет? |
Презентация Өткен сабақта берілген Венн диаграмасын қолдануға болады |
|||||||||||||||||||||||||||
|
Сабақтың ортасы 15 мин |
Жұптық талқылау Сұрақтар:
Жұп 1 ойы:
Жұп 2 ойы:
Жұп 3 ойы:
Жұп 4 ойы: 2-сұрақ: Кездейсоқ іріктеу нәтижеге қалай әсер етеді?
Жұп 1 ойы:
Жұп 2 ойы:
Жұп 3 ойы:
Жұп 4 ойы: ЖАҢА ТАҚЫРЫПТЫ МЕҢГЕРУ Презентация мазмұны
Суреттер:
1-топ – t-тест есебі
Мысал
есеп: Жергілікті өзеннің екі бөлігіндегі балық саны:
Гипотезалар:
Қорытынды: Дескриптор:
2-топ – χ²-критерийі
=20/4+30/16+50/4=0.2+0.53+0.08=0.81 df = 2, χ²крит = 5.99
Қорытынды: Дескриптор:
3-топ – ЖИ қолдану
Кездейсоқ іріктеудің артықшылықтары
Қате іріктеудің салдары
ТЕСТ
|
Бірінші Презентация Жұмыс парағы Екінші презентация Жұмыс парағы |
|||||||||||||||||||||||||||
|
Сабақтың соңы 2мин |
Рефлексия. Ең қызығы не болды? Ең тиімдісі не болды? Мен әлі түсінбеймін ... |
|
|||||||||||||||||||||||||||
31 Сабақ ҚМЖ
|
Ұзақ мерзімді жоспар бөлімі: 11.4АБиосфера, экожүйе, популяция |
Экологияжәнеадаміс-әрекетінің қоршаған ортаға әсері |
|||||||||||||||||||
|
Күні: |
Мұғалімнің аты-жөні: |
|||||||||||||||||||
|
Сынып: |
Қатысқандар саны: |
Қатыспағандар саны: |
||||||||||||||||||
|
Сабақ тақырыбы |
Климаттың экологиядлық проблемалары және оны шешу жолдары дебат сабақ |
|||||||||||||||||||
|
Осы сабақта қол жеткізілетін оқу мақсаттары (оқу бағдарламасына сілтеме) |
11.3.2.2 Қазақстанның экологиялық проблемаларын оқып білу және шешу жолдарынұсыну |
|||||||||||||||||||
|
Сабақ мақсаттары |
11.3.2.2 Қазақстанның экологиялық проблемаларын оқып білу және шешу жолдарын ұсынады |
|||||||||||||||||||
|
Адал азамат» біртұтас тәрбие бағдарламасы құндылықтарын енгізу |
Академиялық шыншылдық, нақтылық, өзін өзі реттей білу , ойды реттей білу, сенімділік, дәлелдерді қолдана білу ,өзіне деген сенімділік, өзін-өзі көрсету болу құндылықтары дамытылады. |
|||||||||||||||||||
|
Сабақ барысы |
||||||||||||||||||||
|
Сабақтың жоспарланған кезеңдері |
Сабақтағы жоспарланған іс-әрекет |
Ресурстар |
||||||||||||||||||
|
Сабақтың басы 0-2 САБАҚТЫҢ ОРТАСЫ |
II. ҚЫЗЫҒУШЫЛЫҚТЫОЯТУ (5 мин) AI Видео Тақырып:“Climate Change: Ecological Consequences” Жеке ойлану: 1 экологиялық проблемаНегізгі мәселе: Атырау қаласының атмосфералық ауасының жоғары ластануыАтырау – Қазақстандағы ірі мұнай–газ өнеркәсібі орналасқан қала. Ол жерде мұнай өңдеу зауыты, мұнай және газ объектілері, құбыр желілері, сүзу жүйесі сияқты өндірістер бар, сондықтан ауаның химиялық заттармен, соның ішінде күкіртсутегі (құрымсыз жұмыртқа иісі) сияқты уытты газбен ластануы байқалады. Бұл мәселе тұрғындар арасында ұзақ уақыттан бері байқалып келеді: тұрғындар қаланың кей аудандарында ауа ластанған кезде тыныс алу қиындықтары, бас аурулары және шаршағыштық туралы шағымдануда. Нақты дерекетер Экологиядепартаментініңзерттеулерінесәйкес, Атырауқаласыныңатмосферасыкөптегенкүндеріластанғанжәнеоныңқұрамындауыттыгаздарбар. en.orda.kz Жергілікті тұрғындар Атырау мұнай өңдеу зауыты жұмыс істеген кезде ауада құрамында зиянды заттар пайда болатынын растайды. en.orda.kz Қазақстанның Экологиялық реттеу және бақылау комитеті Атырау қаласын атмосфералық ауа ластанған 10 қала қатарына енгізген Экологиялық проблеманың себептері Себептер:
Табиғи және адамға әсері Адам денсаулығына әсері:
? Табиғи ортаға әсері:
1 шешу жолы Проблеманы шешу жолдары (жалпы ұсыныстар) 1) Құрылған «Жол картасы» бойынша шаралар Атырау облысы Экология департаментінің «Жол картасына» сәйкес:
2) Ғылыми және технологиялық тәсілдер
Қоғамдық бақылау және заңнама
III. ДЕБАТҚАДАЙЫНДЫҚ (10 мин)Дебатрезолюциясы:«Климаттық дағдарысты шешуде технологиялық шешімдер табиғи экожүйені қорғаудан тиімді» Дебатқа арналған нақты аргументтер Үкімет технологиялық шешімдер қолдайды Аргумент 1. Технологиялық жүйелер ауа сапасын жақсартуға әсер етеді
Аргумент 2. Қалдық тазарту және сүзу технологиялары
Аргумент 3. Инновация және ЖИ шешімдері
Аргумент 4. ҚР-да «Жол картасы» жобасы бар
Оппозиция– табиғатты қорғауды қолдайды Аргумент 1. Тек технология жеткіліксіз
Аргумент 2. Табиғи ортаны қорғау түзету шараларын қажет етеді
Аргумент 3. Жергілікті тұрғындардың денсаулығы мен өмір сапасына назар аудару
Аргумент 4. Заң мен қоғамдық бақылауды күшейту керек
|
Презентация MS PowerPoint Слайд 1 Қосымша 1 (диктовкалық белсенділікті айқайлауға арналған бос орындары бар мәтін) Слайд 2-4
Презентация
(PowerPoint) |
||||||||||||||||||
|
|
Сарапшылардың бағалауы
|
|
||||||||||||||||||
|
Сабақтың соңы 39-40 мин |
|
Слайд 8
|
||||||||||||||||||
32 Сабақ ҚМЖ
|
Ұзақ мерзімді жоспар бөлімі:. |
Экология және адам іс-әрекетінің қоршаған ортаға әсері. |
|||
|
Күні: |
Мұғалімнің аты-жөні: |
|||
|
Сынып: 11 |
Қатысқандар саны:
|
Қатыспағандар саны: |
||
|
Сабақ тақырыбы |
Ғаламдық жылыну: себептері, салдарлары және шешу жолдары. |
|||
|
Осы сабақта қол жеткізілетін оқу мақсаттары (оқу бағдарламасына сілтеме) |
11.3.2.1 - мүмкін болатын климаттың жаһандық жылыну салдарын болжау. |
|||
|
Сабақ мақсаттары |
|
|||
|
Бағалау критерийлері |
|
|||
|
Адал азамат» біртұтас тәрбие бағдарламасы құндылықтарын енгізу |
Академиялық шыншылдық, нақтылық, өзін өзі реттей білу , ойды реттей білу, сенімділік, дәлелдерді қолдана білу ,өзіне деген сенімділік, өзін-өзі көрсету болу құндылықтары дамытылады. |
|||
|
Сабақ барысы |
||||
|
Сабақтың жоспарланған кезеңдері |
Сабақтағы жоспарланған іс-әрекет
|
Ресурстар |
||
|
Сабақтың басы 0-4 мин |
1 Ұйымдастыру кезеңі (3 мин)
II. Қызығушылықты ояту– Видео + ЖИ
Күрделі заманауи
видео «Егер ғаламдық температура 2°C-қа артса, Қазақстанға әсері қандай болады?» Жеке жұмыс Егер ғаламдық температура 2°C-қа артса, Қазақстанға әсері қандай болады?» Ғылыми негізделген болжам
пікір (қорытынды): Егер адамзат әрекетін өзгертпесе, 2050 жылға қарай ғаламдық жылыну экологиялық дағдарыстан гуманитарлық апатқа айналады.
Дескриптор:
|
ИТ, презентация 1-3 слайдтар ИТ, презентация 4-5 слайдтар |
||
|
Сабақтың ортасы 4-36 мин |
Мағынаны ашу 1-тапсырма – Топтық жұмыс (Jigsaw әдісі)
1-топ: Ғаламдық жылыну
себептері Презентация + инфографика + суреттер Аргументтер:
Мысал: Қарсы пікірлер:
Мысал:
Қорытынды (Топтық шешім)
Ғаламдық
жылынуды толық тоқтату
қиын, бірақ
баяулатуға және салдарын
азайтуға адамзаттың мүмкіндігі
бар. Дескриптор:
2-тапсырма – Жұптық жұмыс (Суретпен талдау)
Суреттер:
Мұздықтардың еруі Құрғақшылық Орман өрті Су тасқыны Тапсырма:
1-сурет: Мұздықтардың еруі
2-сурет: Құрғақшылық
3-сурет: Орман өрті
4-сурет: Су тасқыны
Дескриптор:
тест тапсырмасы
1. Ғаламдық жылынудың
негізгі себебі:
2. Парниктік газға
жатады:
3. Ғаламдық жылынудың
салдары емес:
4. Мұздықтардың еруі нені
арттырады?
5. Қазақстанда ғаламдық
жылынудың басты салдары:
6. Климаттың өзгеруі
экожүйеге әсері:
7. Ғаламдық жылынуды
азайтудың бір жолы:
8. Жаңартылатын энергия
көзі:
9. Ғаламдық жылыну қандай
масштабта?
10. Ғаламдық жылыну
мәселесін шешуде маңыздысы: |
ИТ, презентация 6-19 слайдтар Теориялық материал. Бейнебаяндар. |
||
|
Сабақтың соңы 37-40 мин |
3–2–1» әдісі
|
ИТ, презентация 20 слайд |
||
33 –сабақ дебат сабақ ҚМЖ
Сабақтың тақырыбы:: «Табиғат – ортақ үйіміз» (Атырау қаласы мысалында)
Сабақтың мақсаты: Оқушылардың болашақ мамандығы экология, инженерия, су ресурстары сияқты бағыттар болғандықтан, олардың сөздері ғылыми негізге сүйеніп, экологиялық сауаттылық пен талдау дағдысын дамытуға бағытталады
Бұл бөлімде 11сынып оқушыларына арналған дебаттың аргументтерді дайындау кезеңі толық сипатталған. Оқушылар 5 минут ішінде өз ұстанымдарын нақты деректер мен ғылыми дәлелдер арқылы қорғайды. Дебат екі топқа бөлінеді: Топ A – Өнеркәсіп дамуын жақтаушылар, Топ B – Табиғатты қорғаушылар.
Аргументтерді дайындау уақыты – 5 минут
Әр топ өз көзқарасын дәлелдейтін 3–4 аргумент дайындайды. Мақсат – ғылыми негізге сүйену, экологиялық деректерді қолдану және нақты ұсыныстар айту.
Бұл дебат 11-сынып оқушыларына арналған.
Тақырып Атырау қаласының экологиялық жағдайына, өнеркәсіптің (АНПЗ, химия зауыты) және Жайық өзені маңының ластануына негізделеді. Оқушылардың болашақ мамандығы экология, инженерия, су ресурстары сияқты бағыттар болғандықтан, олардың сөздері ғылыми негізге сүйеніп, экологиялық сауаттылық пен талдау дағдысын дамытуға бағытталады.
I. Кіріспе
Мақсаты: оқушылардың
экологиялық сауаттылығын арттыру, ғылыми деректерді қолдана отырып
экологиялық мәселелерді талдау және шешу жолдарын ұсыну.
Форматы: пікірталас-дебат (екі жақты).
Тақырып: «Табиғат – ортақ үйіміз». Атырау қаласы
мысалында.
II. Рөлдер мен құрам
-
1. Модератор Ойынды жүргізеді, сұрақтар мен тәртіпті бақылайды.
-
2. 1-топ – Өнеркәсіпті жақтаушылар (инженерлер, технология мамандары).
-
3. 2-топ – Табиғатты қорғаушылар (экологтар, су ресурстары мамандары).
-
4. Сарапшылар тобы – Бағалау, қорытынды шығару.
V. Қамылатын сұрақтар
-
1. Атырау қаласында ауа сапасының нашарлауына негізгі себеп қандай?
-
2. Өндіріс пен экология арасындағы тепе-теңдікті қалай сақтауға болады?
-
3. Инженерлік тұрғыдан шығарындыларды азайту үшін қандай технологияларды қолдануға болады?
-
4. Экологиялық мониторинг пен деректерді ашық жүргізу не үшін маңызды?
-
5. Жайық өзенін қорғауға қандай шаралар қажет?
-
6. Қалалық тұрғындардың экологиялық мәдениетін арттыру жолдары қандай?
VI. Аргументтер кестесі
|
Тарап |
Аргумент |
Ғылыми негіз / дерек |
|
Өнеркәсіпті жақтаушылар |
Өндіріс аймақ экономикасын дамытады |
Технологиялық жаңғырту шығарындыларды 40%-ға азайтады |
|
Табиғатты қорғаушылар |
Ауаның ластануы халық денсаулығына зиян |
Зияндызаттар менH₂S көрсеткіштері нормадан 4–8 есе жоғары |
|
Экологтар |
Жайық өзені суының сапасы төмендеген |
Суда ауыр металдар мен мұнай өнімдері анықталған |
VII. Бағалау парағы
Әр критерий 1–5 балл аралығында бағаланады.
|
Критерий |
Сипаттама |
Баға (1–5) |
|
Ғылыми дәлдік |
Оқушының айтқан деректері нақты және ғылымға негізделген |
|
|
Логикалық құрылым |
Ойы жүйелі, аргументі дәйекті |
|
|
Коммуникативтік дағды |
Өз ойын анық жеткізе білу, дәлел келтіру |
|
|
Сын тұрғысынан ойлау |
Қарсы тараптың пікірін талдай алу |
|
|
Шешім ұсыну |
Нақты экологиялық шешім ұсыну және қорғау |
|
Сарапшылар дебат соңында әр топтың нәтижесін бағалайды. Ең жоғары ұпай жинаған топ «Экологиялық ойлауы жоғары команда» деп танылады.
Аргументтерді дайындау кезеңінде екі топ өз көзқарасын ғылыми дәлелдермен нығайтады. Топ A – инженерлер – экологиялық қауіпсіз технологияларды ұсыну арқылы өндіріс пен табиғатты тең ұстауға тырысады. Топ B – экологтар мен су мамандары – адам денсаулығы мен табиғи тепе-теңдікті басты орынға қояды. Мақсат – экологиялық және экономикалық тұрақтылықтың үйлесімді шешімін табу.
Топ A: Өнеркәсіп дамуын жақтаушылар (инженерлердің ұстанымы)
Бұл топтың негізгі идеясы – өндіріс қаланың экономикалық дамуының өзегі, бірақ экологиялық қауіпсіздік технологиялық жаңғырту арқылы қамтамасыз етілуі мүмкін.
Аргумент 1. Экономикалық даму мен жұмыспен қамту**
Атырау қаласы Қазақстан экономикасының маңызды мұнай орталығы. Атырау мұнай өңдеу зауыты (АНПЗ) мен Теңізшевройл сияқты кәсіпорындар мыңдаған адамды жұмыспен қамтып отыр. 2023 жылғы мәлімет бойынша, тек АНПЗ-де 2000-нан астам адам тұрақты жұмыс істейді. Бұл өңірдің ЖІӨ-нің 40%-ы мұнай өнеркәсібінен түседі. Мұнай өңдеу зауытының маңызы.Мұнай өңдеу зауыттары – шикі мұнайды түрлі пайдалы өнімдерге айналдыратын кәсіпорындар. Маңызы: Энергия көзі – бензин, дизель отыны, мазут сияқты жанармай түрлерін өндіреді. Өнеркәсіптің басқа салаларына шикізат береді – пластмасса, синтетикалық талшық, резеңке, химиялық заттар жасауға пайдаланылады. Экономикалық пайда – экспорт арқылы ел қазынасына үлкен кіріс түсіреді. Жұмыс орындары – аймақтық экономиканы дамытуға, инфрақұрылымды жақсартуға ықпал етеді.
Газ өндіру өнеркәсібінің маңызыГаз – таза әрі тиімді энергия көзі. Маңызы:
Энергетикада қолданылады – электр энергиясын өндіруде, тұрмыстық жылыту жүйелерінде пайдаланылады. Экологиялық тұрғыдан тиімді – көмір мен мазутқа қарағанда атмосфераны аз ластайды.
Химия және өнеркәсіп салаларына шикізат береді – тыңайтқыш, пластмасса, резеңке өндірісінде қолданылады. Экспорт әлеуеті жоғары – Қазақстан сияқты елдер үшін шетелге сатылатын маңызды табиғи ресурс.
Мұнай және газ кендерін игеру.Мұнай мен газ кен орындарын барлау және игеру – елдің стратегиялық маңызы бар саласы. Маңызы: Мемлекеттің энергетикалық қауіпсіздігін қамтамасыз етеді. Аймақтық дамуға ықпал етеді – жол, тұрғын үй, әлеуметтік нысандар салынады. Инвестиция тартады – шетелдік және отандық компаниялар экономиканың дамуына үлес қосады.
Химия өнеркәсібінің маңызы.Химия зауыттары – мұнай мен газ өнімдерін өңдеп, түрлі өндірістік және тұрмыстық заттарды шығарады. Маңызы: Шикізатты терең өңдеу арқылы қосымша құн жасайды. Ауыл шаруашылығына тыңайтқыш, өсімдікті қорғау құралдарын өндіреді. Жеңіл өнеркәсіпке – бояу, пластмасса, талшық, сабын, парфюмерия сияқты өнімдер береді. Экономиканы әртараптандырады, яғни ел тек шикізат экспорттаумен шектелмей, дайын өнім шығара бастайды.
Қорытынды: Мұнай өңдеу, газ өндіру және химия зауыттары – елдің индустриялық дамуының тірегі. Бұл салалар:, ұлттық табысты арттырады, жаңа технологияларды енгізеді, халықтың өмір сапасын жақсартады
Аргумент 2. Экологиялық технологиялар енгізілуде**
Соңғы жылдары зауыттарда экологиялық жаңғырту жұмыстары жүргізілуде. Мысалы, 2022 жылы АНПЗ-де күкірт қалдықтарын өңдейтін жаңа кешен іске қосылды. Бұл атмосфераға тарайтын зиянды шығарындыларды 38%-ға дейін азайтуға мүмкіндік берді. (Дерек көзі: KMG Engineering, 2023 ж.) Инженерлік тұрғыдан, катализдік риформинг және газ тазалау жүйелері (Gas Treatment Units) арқылы NO₂ және SO₂ бөлінуін 50%-ға азайтуға болады. Болашақ инженерлер ретінде біз табиғатты қорғау мен өндірісті қатар дамыту мүмкін екенін дәлелдей аламыз. Өнеркәсіптегі экологиялық жаңғырту жұмыстары
Соңғы жылдары елімізде өнеркәсіп саласында экологиялық жаңғырту жұмыстары кеңінен жүргізілуде. Бұл шаралардың басты мақсаты – табиғатты қорғау, ауа мен судың ластануын азайту және өндірістің тұрақты дамуын қамтамасыз ету.
Мұнай өңдеу зауыттарында экологиялық жаңғырту нәтижесінде жаңа технологиялар енгізілуде. Зауыттарда мұнайды терең өңдеу деңгейі арттырылып, зиянды қалдықтар мен газдар шығарындылары азайтылуда. Арнайы тазарту қондырғылары орнатылып, ағын сулар биологиялық және механикалық әдіспен тазартылады. Бұл атмосфера мен өзен-көлдердің ластануын едәуір төмендетеді.
Химия зауыттарында экологиялық қауіпсіз өндіріс процестері енгізілуде. Зиянды реагенттердің орнына экологиялық таза материалдар қолданылып, қалдықсыз немесе аз қалдықты технологиялар пайдаланылуда. Сондай-ақ, зауыттарда қалдықтарды қайта өңдеу және қайта пайдалану жүйесі дамып келеді.
Мұнай және газ кен орындарында да экологиялық шаралар қолға алынған. Ұңғымалардан бөлінетін газдарды өртеу орнына, оларды жинап қайта пайдалану жүйесі енгізілуде. Топырақ пен жер асты суларының ластануын болдырмау үшін экологиялық бақылау күшейтіліп, жерді рекультивациялау (яғни бұрынғы табиғи қалпына келтіру) жұмыстары жүргізілуде
Аргумент 3. Технологиялық шешім – басты бағыт**
Қазіргі кезде зауыттар мен кен орындарында технологиялық жаңару мен цифрландыру – басты шешімге айналды. Заманауи технологиялар өндірістің тиімділігін арттырып қана қоймай, экологиялық қауіпсіздікті қамтамасыз етеді.
Жаңа автоматтандырылған жүйелер мен цифрлық бақылау құралдары арқылы өндіріс процестері нақты және жылдам басқарылады. Бұл энергияны үнемдеуге, шикізатты тиімді пайдалануға және қалдықтарды азайтуға мүмкіндік береді.
Мұнай, газ және химия салаларында жаңа буын қондырғылар енгізіліп, «жасыл технологиялар» қолданыла бастады. Мысалы, шығарындыларды азайтатын сүзгі жүйелері, суды қайта пайдалану станциялары және интеллектуалды ұңғымалар кеңінен таралуда.
Осылайша, технологиялық бағыт – қазіргі өнеркәсіптің бәсекеге қабілеттілігі мен экологиялық тұрақтылығын қамтамасыз ететін негізгі фактор болып отыр.
Мысалы:Инженерлік тұрғыдан, катализдік риформинг және газ тазалау жүйелері (Gas Treatment Units) арқылы NO₂ және SO₂ бөлінуін 50%-ға азайтуға болады. Болашақ инженерлер ретінде біз табиғатты қорғау мен өндірісті қатар дамыту мүмкін екенін дәлелдей аламыз. Өнеркәсіптегі экологиялық жаңғырту жұмыстары
Қорыта айтқанда, экологиялық жаңғырту – бүгінгі өнеркәсіптің маңызды бағыты. Табиғатты қорғау мен ресурстарды үнемдеу арқылы өндіріс пен экология арасындағы тепе-теңдікті сақтау – еліміздің тұрақты дамуының кепілі.
Аргумент 4. Қалдықсыз өндіріс қағидаты**
Қалдықсыз өндіріс – табиғи ресурстарды тиімді пайдаланып, өндіріс барысында пайда болатын қалдықтарды барынша азайту немесе толық қайта өңдеу жүйесі. Бұл бағытта зауыттар мен кен орындарында бірқатар маңызды жұмыстар жүргізілуде:
1. Қалдықтарды қайта өңдеу және қайта пайдалану – өндірістен шыққан шикізат қалдықтары мен суларды қайта өңдеп, екінші рет өндіріс процесіне енгізу.
Мысалы: мұнай өңдеу зауыттарында қалдық газдар мен суларды тазалап, қайта қолдану.
2. Қалдықсыз технологиялар енгізу – өнім өндіру кезінде артық қалдық қалдырмайтын жаңа технологиялар мен жабдықтар пайдалану.
Мысалы: химия зауыттарында реакцияны толық өтетіндей етіп жасау, қосымша өнімдерді жаңа материалдарға айналдыру.
3. Энергия мен ресурстарды үнемдеу – энергия үнемдейтін жабдықтар мен автоматтандырылған басқару жүйелерін қолдану.
Мысалы: газ кен орындарында ілеспе газды өртеу орнына, оны қайта пайдалану арқылы энергия өндіру.*
4. Экологиялық бақылау және мониторинг жүйесі – өндіріс кезінде ауа, су, топырақ сапасын тұрақты бақылау, ластану деңгейін азайту.
5. Жасыл экономикаға көшу – жаңартылатын энергия көздерін (күн, жел энергиясы) пайдалану және экологиялық таза өнім өндіру.
Қазақстанның «Жасыл экономика» тұжырымдамасы бойынша 2030 жылға қарай қалдықсыз өндіріс үлесін 15%-ға жеткізу көзделген. Бұл бағытта инженерлердің басты рөлі – ресурстарды үнемдеп, қайта өңдеуді арттыру.
Топ B: Табиғатты қорғаушылар (экологтар мен су мамандарының ұстанымы)
Бұл топ табиғат пен адамның денсаулығын бірінші орынға қояды. Олар экологиялық тепе-теңдік бұзылса, экономикалық пайда мағынасыз деп санайды.
Аргумент 1. Ауаның ластану деңгейі өте жоғары**
Атырау қаласы – Қазақстандағы ауасы ең лас қалалардың бірі. ‘Қазгидромет’ деректері бойынша, 2023 жылы атмосфералық ауа сапасының индексі (AQI) – 178 (қауіпті деңгей). H₂S (күкіртсутегі) мөлшері кей аудандарда шекті нормадан 6–8 есе жоғары тіркелген. Бұл өкпе және бронх ауруларының, аллергиялық реакциялардың артуына әкеледі. егізгі себептері және деректер
1. Көмірсутекті өндірістен шығатын шығарындылар — өртеу (flaring), желдету және төгілу (venting, fugitive emissions).
Теңіз және басқа кен орындарындағы факелдар мен ұңғыма операцияларының шығарындылары — SO₂, NOx, күкірт қосылыстары, VOC (летучие органикалық заттар) және бөлшекшелердің (PM) көзі. Бұған қатысты сараптамалық зерттеулер факелдан шығатын заттардың көлемін талдайды және олардың аймақтық әсерін көрсетеді.
2. Өнеркәсіптік өндіріс көлемінің үлкендігі (Теңіз, Атырау мұнай өңдеу зауыты, химия кәсіпорындары).
Теңізшевройл (TCO) — аймақтағы ірі өндірушілердің бірі; компания өз есептерінде 2000 жылдан бері өртеуді (flaring) және шығарындыларды едәуір қысқартқанын жазады, бірақ өндіріс көлемі жоғары болғандықтан абсолюттік әсер аймаққа сезіледі. (TCO: «record low emissions intensity»; flaring көлемі 2000 жылдан бері 93% төмендегені туралы деректер).
3. Мұнай өңдеу зауытының және ескі қондырғылардың әсері — күкірт және бөлшекшелер.
Атырау мұнай өңдеу зауытында жаңғырту жұмыстары жүргізіліп жатқаны туралы ақпарат бар, бірақ үлкен көлемді өңдеу (миллиондаған тонна шикізат) атмосфераға әсерін сақтайды; өңдеу өнімі жоғары болған сайын эмиссия басқаруы маңызды. Мысалы, зауыт энергетикасы мен отын сапасын жақсарту болжамдары бар.
4. Метеорологиялық және географиялық факторлар — жағдайды ушықтыра алады.
Қысқы ауа инверсиялары, желдің әлсіздігі, аймақтың түздығымен (Caspian аймағы) байланысты шаң-тозаң (dust) және Каспийдің тартылуы (сезондық шаңды дауылдар) да ауа сапасын нашарлатуы мүмкін. Бұл факторлар өнеркәсіптік эмиссияларды қалаға жинақтап, тұрғындарға зиян келтіреді. (Аймақтық экология мәселелері мен Каспий деңгейінің өзгеруі туралы мақалалар).
5. Мониторинг және қоғамдық алаңдаушылық — бақылау жүйелерінің шектеулері.
Қалалық және тәуелсіз станциялар арасына айырмашылықтар бар; онлайн-карталар (IQAir, AQICN, AirKaz) нақты уақыттағы PM2.5/PM10 мәндерін көрсетеді — кей күндері AQI «орташа» және «қанағаттанарлық» болса да, қауіпті «жоғары» межені басып өтеді. Жергілікті БАҚ пен белсенділер өнеркәсіптің әсеріне жиі шағымданады.
Аргумент 2. Денсаулыққа тікелей әсері бар**
Нақты деректер (мысал ретінде)
Tengiz/TШO: компания есептерінде 2023 жылы «шығындылық/эмиссия интенсивтігі» 2000 жылдан бергі ең төменгі деңгейге түскені және фларинг көлемі соңғы 5 жылда 57% азайғаны айтылады; сонымен бірге өндіріс көлемі жоғары. (TШO корпоративтік есептері).
Ауа сапасының көрсеткіші (реал-тайм): IQAir және AQICN сайттарында Атырау бойынша PM2.5 және AQI деректері қолжетімді; мысалы, белгілі уақыттарда AQI ~50–60 (орташа деңгей) тіркеледі, ал жоғары ластану күндерінде бірнеше есе көтеріледі. (IQAir, AQICN нақты уақыттық станциялар).
Ғылыми талдаулар: факелдардан шығатын заттар мен олардың көлемін талдаған жарияланымдар бар — факелдық шығарындылардың аймақтық ластаушы рөлін көрсетеді.
Неліктен «зауыттар/кен орындар ауа сапасын сақтамай отыр» деген пікір қалыптасады?
Өндірістің көлемі мен техникалық күрделілігі — тіпті техникалық шаралар жасалғанымен, абсолютті шығарындылар байқалады. (TCO деректері жақсаруға бағытталса да, тұрғындар әсерін сезінуі мүмкін).
Факелдау мен төгілудің (venting) кешенді әсері — жылдам және көрінетін ластану көздері.
Мониторинг желісінің шектеулері мен қоғамдық сенімнің төмен болуы — кейде ресми есептер мен жергілікті тәжірибе арасында сәйкессіздік көрінеді.
Атырау облыстық денсаулық сақтау басқармасының дерегі бойынша, соңғы 5 жылда тыныс алу органдары аурулары 27%-ға артқан. Балалар арасында астма мен бронхит жиілеген. Қала тұрғындары арасында қатерлі ісік ауруларының көрсеткіші де республика бойынша ең жоғары үштікке кіреді.
Аргумент 3. Жайық өзенінің экологиялық жағдайы нашарлап барады**Ғылыми зерттеу мәліметтері бойынша Жайық өзенінің төменгі ағысында (Қазақстандағы бөлігінде) нитриттер, бор (boron) және мұнай өнімдері рұқсат етілген шектен жоғары деңгейде анықталған. Бұрынғы жылдармен салыстырғанда су көлемі едәуір төмендеген: соңғы 20 жылда өзеннің су мөлшері шамамен 12 км³-тен 5 км³-ке дейін азайғаны айтылған.
Жайық басқаратын бассейн бойынша ұзақ мерзімді мониторинг нәтижелері: төмен су деңгейі, су аймағының тарылуы, балығы мен табиғи жаға аймақтарының жойылуы байқалған.
Судың сапасы жағынан: «Поли-хлорланған дифенилдер» (PCBs) сияқты жоғары токсикалы заттардың концентрациясы да өзенде анықталған — мысалы 0.93-1.29 µg/L деңгейінде.
Негізгі мәселелер: Судың азаюы → су аймағы тарылып, жағалау экожүйелері бұзылуда. Қалдықтар мен өнеркәсіптік эмиссиялар (мұнай өнімдері, химиялық заттар) өзен экологиясына зиян келтіруде.
Трансшекаралық өзен болғандықтан (Россия және Қазақстан арқылы) су бөлу, реттеу, су алаптарының дамуы мәселелері маңызды.
Каспий теңізі деңгейінің төмендеуі
Деректер:
Каспий теңізінің суы соңғы жылдары өзінше төмендеуде: мысалы, 1979-2015 жылдар аралығында орташа су бетінің деңгейі төмендегені айтылған.
Қазақстанның экология министрлігі мәліметтері бойынша Каспий жағалауында 22 000 шаршы километрден астам аумақ су деңгейінің төмендеуінен құрғақтанған.
Әсіресе солтүстік бөлігі (Қазақстан жағалауы) қатты зардап шегіп отыр — мысалы, жағалау сызығы 20-30 км-ге шегінген.
Себептері: Су кірісінің азаюы: Теңізге ағатын үлкен өзендердің (мысалы, Волга өзені және Жайық өзені) ағысы тұрақты азайған.
Климаттық өзгерістер: жауын-шашынның азаюы, температураның көтерілуі, буланудың жоғарылауы.
Суға арналған инженерлік құрылымдар: су қоймалары, бөгеттер, трансшекаралық су басқару — өзендердің Каспийге ағып кіруін төмендетуде.
Қауіпті салдары: Экожүйелер зардап шегуде: жағалаудың тарылуы, балық пен маңызы бар түрлердің бағасы төмендеуде.
Суармалы жерлер мен тұрғын аймақтар үшін қауіп: су көзінің азаюы мен тұщы-тұзды теңгерімнің бұзылуы.
Қаржы және инфрақұрылым мәселелері: порттар, теңіз көлігі, мұнай-газ платформалары төмен су деңгейімен күресуде.
Жайық өзенінің су сапасы ‘орташа ластанған’ санатында. Суда мұнай өнімдерінің және ауыр металдардың (мыс, қорғасын, мырыш) мөлшері нормадан 2–5 есе жоғары. Бұл биожүйеге, балық шаруашылығына және ауызсу сапасына зиян келтіреді.
Аргумент 4.1. Халықтың өмір сүру сапасына әсеріне тоқталсам
1.Ауаның ластануы — нақты оқиғалар мен артық көрсеткіштергетоқталсақ (H₂S) — қауіпті және жиі тіркелетін ұшымаған газ: 2023 жылы Атырауда H₂S деңгейінің 20 есе артық тіркелгені туралы ақпарат жарияланған. Кейбір оқиғаларда түнгі уақытта 32 есе артық мөлшер анықталғаны хабарланды. Бұл көрсеткіштер тұрғындардың қатты улануы мен тыныс алудың қиындауына тікелей себеп болады.
2025 жылдың маусымында да жергілікті хабарлар мен мониторинг нәтижелері H₂S деңгейінің қауіпті деңгейден 11 есе жоғары болғанын жариялады (өршіп жатқан шөп-шалдық пен өнеркәсіптен шыққан түтін әсері). Мұндай шоғырланулар тұрғындардың тері, көз күйдіруі, бас айналу, жүрек-тамыр және тыныс алу проблемаларын тудырады.
Не маңызды: H₂S-тің жоғары дозалары өлімге дейін әкелуі мүмкін; төмен деңгейдегі ұзақ мерзімді әсерлері — бас ауруы, жөтел, тыныс алу жолдарының созылмалы аурулары, репродуктивті және жүйелік әсерлер. (экологиялық-медициналық зерттеулер көрсеткен).
2) Денсаулық статистикасы — нақты көрсеткіштер мен тенденциялар
Туберкулез (мысал): Атырау облысы бойынша 2022 жылдың 8 айында жаңадан 271 науқас тіркелген; бұл 2021 жылғы осы кезеңмен салыстырғанда 9.8% кемігенімен аймақ туберкулез бойынша әлі де «қауіпті» топқа жатады — тұрғындардың жалпы жұқпалы ауру жүктемесіне әсері бар. (Ресми облыстық хабарлама).
Жалпы аурушаңдық құрылымы: жергілікті медициналық зерттеулер мен есептер бойынша Атырауда тұрғындардың медициналық мекемелерге жүгінуінің негізгі себептерінің бірі — тыныс алу мүшелерінің аурулары (жоғары орындардың бірі). Бұл зерттеулер өнеркәсіптік шығарындылар мен ауаның нашарлауын себебі ретінде көрсетеді.
3) Халықтың күнделікті өміріне әсері — нақты мысалдар
Кезекші шағымдар: тұрғындар H₂S ұрықтайтын жағымсыз иістен, жөтел мен көз күйдіруінен шағымданады; кей күндері мектептер мен балабақшаларда ауа сапасының нашарлауына байланысты сыртқа шығуға шектеу қойылған немесе адамдар терезелерін ашпаған жағдайлар тіркелген. (жергілікті БАҚ хабарламалары мен тұрғын шағымдары).
Экономикалық әсері: балық шаруашылығының және жағалау инфрақұрылымдарының зардап шегуі — бұл жергілікті халықтың табыс көзіне әсер етеді (порттар, балық өңдеу). Каспий жағалауының тартылуы және өзендердің ағысының азаюы ауыл шаруашылығына да кері әсер етеді. (қоршаған орта сараптамалары).
4) Ғылыми және өңірлік мониторинг нәтижелерінен қорытындылар
Бүгінгі мониторинг пен зерттеулер ауыр және уытты газдардың, сондай-ақ мұнай өнімдері мен химиялық заттардың (органика, бор, т.б.) жиналатынын көрсетеді. Бұл — созылмалы аурулардың өсуіне, әсіресе тыныс алу және жүрек-қантамыр жүйесінің сырқаттарына әкеліп соғуда.
5) Қолдан келетін нақты деректер
H₂S артықшылығы: 11× (маусым 2025), 20× (апрель 2023), 32× (26 қазан, жыл белгіленген оқиға) — әрқайсысы жергілікті мониторинг пен БАҚ-та жарияланған оқиғалар.
Туберкулез — 271 жаңа жағдай (8 ай, 2022) — ресми облыстық дерек.
Ғылыми мақалалар мен жергілікті зерттеулер Атырауда тыныс алу ауруларының (мыс., бронхит, созылмалы бронхит, астма симптомдары) негізгі себептердің бірі екенін растайды.
6) Қорытынды және ұсыныстар (қысқа)
Қорытынды: Атырау өңіріндегі өнеркәсіптік ластану — H₂S-тің бірнеше есе асып кетуі, мұнай және химиялық қалдықтардың су мен топыраққа түсуі, және Каспий деңгейінің төмендеуі — барлығы халықтың денсаулығы мен күнделікті тұрмыс сапасына тікелей әсер етуде: тыныс алу аурулары, экономикалық жоғалту (табыстың төмендеуі), өмір сапасының нашарлауы.
Ұсыныстар (жедел):
1. Тәуелсіз және ашық ауа мониторинг станцияларын көбейту (онлайн және қол жетімді деректер).
2. Халықтың денсаулығын бақылау — медициналық скринингтер (тыныс алу, жүрек-қантамыр) және өкпе функциясын тексеру.
3. Өнеркәсіптік шығарындыларды қысқарту: фларингті азайту, H₂S жинау және тазарту жүйелерін енгізу.
4. Қоғамдық хабардарлық: қауіпті күндерде тұрғындарға алдын ала ескерту және қауіпсіздік нұсқаулары.
БҰҰ деректері бойынша, экологиялық факторлар өмір сүру ұзақтығын 3–5 жылға қысқартады. Атыраудағы ластану деңгейі халықтың денсаулығына және әлеуметтік әл-ауқатына қауіп төндіреді.
Қорытынды
Аргументтерді дайындау кезеңінде екі топ өз көзқарасын ғылыми дәлелдермен нығайтады. Топ A – инженерлер – экологиялық қауіпсіз технологияларды ұсыну арқылы өндіріс пен табиғатты тең ұстауға тырысады. Топ B – экологтар мен су мамандары – адам денсаулығы мен табиғи тепе-теңдікті басты орынға қояды. Мақсат – экологиялық және экономикалық тұрақтылықтың үйлесімді шешімін табу.
34 сабақ ҚМЖ
Сабақтың тақырыбы : Жобалық жұмыс: «Жасыл желек – ауыл экожүйесінің тынысы»
Сабақтың мақсаты : ауылдық аймақтағы экологиялық мәдениетті арттыруға, көгалдандырудың экологиялық әсерін зерттеуге және оқушылардың зерттеушілік қабілеттерін дамытуға бағытталған.
1. Кіріспе
Қазіргі уақытта ауылдық аймақтарда жасыл желектерді көбейту мен экожүйені жақсарту маңызды міндеттердің бірі болып отыр. Ауыл тұрғындарының белсенді қатысуымен көшелер бойына ағаш отырғызу, мектеп ауласын көгалдандыру және демалыс орындарын жасау – экологиялық сана мен ынтымақтастықтың нақты көрінісі болып табылады.
Бұл жобада оқушылар өз ауылындағы көгалдандыру шараларының нәтижесін зерттеп, ғылыми тұрғыда талдау жасайды.
2. Жобаның мақсаты
Ауыл аумағындағы көгалдандыру шараларының тиімділігін анықтау және өсімдіктердің ауыл экожүйесін жақсартудағы рөлін зерттеу.
3. Міндеттері
-
1. Ауылдағы отырғызылған ағаш түрлерін (тал, терек және т.б.) анықтау.
-
2. Жасыл желектің экологиялық маңызын түсіндіру.
-
3. Мектеп ауласы мен көшелер бойындағы ағаштардың өсу динамикасын бақылау.
-
4. Ауыл тұрғындарының экологиялық мәдениеті мен қатысу деңгейін зерттеу.
-
5. Көгалдандыру жұмыстарының тиімділігін арттыру бойынша ұсыныстар жасау.
4. Зерттеу нысаны мен пәні
Зерттеу нысаны: ауыл көшелері мен мектеп ауласындағы отырғызылған ағаштар (тал, терек).
Зерттеу пәні: жасыл желектің экологиялық және әлеуметтік әсері.
Зерттеу аймағы: Атырау облысы, ауылдық елді мекен.
5. Зерттеу әдістері
• Бақылау әдісі – ағаштардың өсу биіктігі, жапырақ көлемі, түсі және жағдайын бақылау.
• Өлшеу және салыстыру әдісі – жылдар арасындағы өсім динамикасын салыстыру.
• Сауалнама және сұхбат – ауыл тұрғындары мен оқушылардың көзқарасын білу.
• Фотофиксация – көгалдандыру процесін фото және бейне материалдармен тіркеу.
• Математикалық талдау – отырғызылған және тірі қалған ағаштардың пайыздық үлесін есептеу.
6. Күтілетін нәтижелер
• Ауыл экожүйесінің сапасы жақсарады (ауа, ылғал, көлеңке).
• Оқушылардың зерттеушілік қабілеті мен экологиялық мәдениеті артады.
• Мектеп пен ауыл тұрғындары арасында экологиялық ынтымақтастық қалыптасады.
• «Жасыл белдеу» картасы жасалады (ағаш түрлері мен орналасқан жерлері).
• Болашақта жобаны кеңейту үшін нақты ұсыныстар әзірленеді.
7. Жобаны орындау кезеңдері
|
Кезең |
Уақыты |
Іс-шара мазмұны |
|
I кезең |
1 апта |
Ағаш түрлері мен отырғызылған орындарды анықтау. |
|
II кезең |
2 апта |
Ағаштардың өсуін бақылау және өлшеу. |
|
III кезең |
3 апта |
Ауыл тұрғындары арасында сауалнама жүргізу. |
|
IV кезең |
4 апта |
Нәтижелерді талдау және диаграмма жасау. |
|
V кезең |
5 апта |
Қорытынды баяндама және ұсыныстар әзірлеу. |
8. Нәтижелерді ұсыну форматы
• Презентация (PowerPoint
форматында);
• Фотоесеп және инфографика;
• «Жасыл белдеу» картасы;
• Ғылыми баяндама (мектеп немесе аудандық
конференцияға).
9. Ұсыныстар
• Әр сынып өз көшесіне жауапты
болсын.
• Әр ағашқа тақтайша немесе QR-код орнатып, «экологиялық паспорт»
жасау.
• Мектеп жанынан «Жасыл зертхана» клубын құру.
• Тамшылатып суару жүйесін енгізу және маусымдық күтім
ұйымдастыру.
10. Қорытынды
«Жасыл желек» жобасы ауылдық экожүйені сақтау мен көркейтуге бағытталған. Жоба барысында оқушылар нақты зерттеу дағдыларын меңгереді, экологиялық сана қалыптастырады және туған жер табиғатына жауапкершілікпен қарауды үйренеді.
Пайдаланылған әдебиеттер:
-
Бейсенова, Ә. С., Шілдебаев, Ж. Б., Сүлейменова, Э. Н. (2019). Жалпы биология. Алматы: Мектеп.
-
Мырзагалиева, А. Т. (2020). Молекулалық биология және генетика. Алматы: Қазақ университетi.
-
Тұрлыбекова, А. С. (2021). Информатика және жасанды интеллект негіздері. Астана: Фолиант.
-
Ахметова, А. Б. (2022). Биоинформатика: оқу құралы. Алматы: Қазақ университеті.
-
Сейтқазина, Г. К. (2023). Биологияны оқыту әдістемесі. Алматы: Рауан.
-
Қазақстан Республикасы Білім және ғылым министрлігі. (2020). Жаратылыстану-математикалық бағыттағы пәндерді оқыту тұжырымдамасы.
-
UNESCO (2021). Ethics of Artificial Intelligence: Global Frameworksand Recommendations. Paris: UNESCO Publishing.
-
Гудфеллоу, И., Бенжио, Й., Курвиль, А. (2020). Глубокое обучение. М.: Диалектика.
-
Норвиг, П., Рассел, С. (2021). Искусственный интеллект: современный подход (4-е изд.). М.: Вильямс.
-
Тарновский, Д. В. (2020). Искусственный интеллект и анализ данных в биомедицине. СПб.: Питер
-
Балди, П., Брунак, С. (2004). Биоинформатика: методы машинного обучения. М.: Мир.
-
Лешев, А. В. (2021). Программирование на Python для анализа биологических данных. М.: ДМК Пресс.
-
Колесников, А. А. (2020). Биоинформатика: анализ последовательностей и геномов. М.: Лань.
-
Лившиц, Б. Л. (2019). Методика преподавания биологии в средней школе. М.: Академия.
-
Орлова, Н. А. (2018). Информационные технологии в биологии и экологии. М.: Инфра-М.
-
Садовничий, В. А., Чубарьян, А. О. (ред.) (2022). Цифровая трансформация науки и образования: сборник статей. М.: Наука.
-
Биология жалпы білім беретін мектептің жаратылыстану –математика бағытындағы
11 сынып оқулығы: Н.Абылайханова, А.Қалыбаева, А.Пәрімбекова, Б.Үсіпбек
Е.Шевцова
жүктеу мүмкіндігіне ие боласыз
Бұл материал сайт қолданушысы жариялаған. Материалдың ішінде жазылған барлық ақпаратқа жауапкершілікті жариялаған қолданушы жауап береді. Ұстаз тілегі тек ақпаратты таратуға қолдау көрсетеді. Егер материал сіздің авторлық құқығыңызды бұзған болса немесе басқа да себептермен сайттан өшіру керек деп ойласаңыз осында жазыңыз
«Жасанды интеллект және биологияның болашақ зерттеулері» авторлық бағдарлама
«Жасанды интеллект және биологияның болашақ зерттеулері» авторлық бағдарлама
Фазылова Жибек Убеновна
«Жасанды интеллект және биологияның болашақ зерттеулері» авторлық бағдарлама
Атырау – 2025
УДК 371.214
ББК 74.202
Ф 16
Рецензент:
Калиманова Данагул Жаскайратовна - Х.Досмұхамедов атындағы Атырау университеті КеАҚ
“Химия және химиялық технология” кафедрасының қауымдастырылған профессоры, биология ғылымдарының кандидаты
Фазылова Ж.У.
«Жасанды интеллект және биологияның болашақ зерттеулері» авторлық бағдарлама. Атырау. Ақжайық баспасы. 70 бет.
ISBN 978-601-12-4135-9
Бағдарлама негізінен жоғары сынып оқушыларына, жаңа технологияларға қызығушылығы бар жас зерттеушілерге арналған. Негізгі мақсат – биология мен жасанды интеллект салаларының өзара байланысын ғылыми тұрғыда түсіндіру және болашақтағы қолданбалы зерттеулерге жол ашу.Бұл бағдарлама – ғылымға қызығатын жастар үшін болашақтағы инновациялық жетістіктерге алғашқы қадам. ЖИ мен биологияны үйлестіре отырып, оқушылар шынайы өмірге бағытталған мәселелерді ғылыми тұрғыда шешуді үйренеді, өз зерттеуін жүргізуге ынталанады.
УДК 371.214
ББК 74.202
Ф 16
Фазылова Ж.У.., 2025
Түсінік хат
Бүгінгі таңда ғылым мен техниканың жедел дамуы жасанды интеллект (ЖИ) технологияларын әртүрлі салада, соның ішінде биологияда да кеңінен қолдануға мүмкіндік беріп отыр. ЖИ құралдарының көмегімен күрделі биологиялық жүйелерді модельдеу, генетикалық деректерді талдау, ауруларды ерте диагностикалау және емдеу стратегияларын оңтайландыру сияқты міндеттерді тиімді шешуге болады. Осыған орай, биология мен ЖИ-дің тоғысқан тұсында орналасқан пәнаралық бағыттар – қазіргі ғылымның басым бағыттарының бірі ретінде айқындалып отыр.
Ұсынылып отырған авторлық бағдарлама білім алушылардың биология және жасанды интеллект салалары бойынша іргелі және қолданбалы білімін тереңдетуге, сондай-ақ зерттеушілік құзыреттерін дамытуға бағытталған. Бағдарлама мазмұны биологиялық деректерді сандық түрде өңдеу, оларды талдауда заманауи алгоритмдер мен модельдерді қолдану, сондай-ақ деректер ғылымы мен биоинформатика негіздеріне сүйену арқылы құрылымдалған.
Курс аясында білім алушылар жасанды интеллекттің теориялық негіздерімен танысып қана қоймай, нақты биологиялық міндеттерді шешуге арналған практикалық дағдыларды меңгереді. Атап айтқанда, геномдық мәліметтерді машиналық оқыту әдістері арқылы өңдеу, жасушалық процестерді модельдеу, ақуыз құрылымын болжау, экологиялық мониторинг жүйелерін автоматтандыру және медициналық диагнозды қолдау сияқты нақты жобалар қарастырылады.
Сонымен қатар, бағдарлама ғылыми ізденіске ынталандыру, ақпараттық технологияларды биологиялық зерттеулерге интеграциялау және оқушылардың болашақ кәсіби бағдарын айқындауға жәрдемдесу мақсатын көздейді. Оқыту процесі жобалық және зертханалық жұмыстармен, дербес зерттеулермен, цифрлық ресурстармен жұмыс істеумен толықтырылады.
Осы арқылы курс білім алушыларды XXI ғасыр ғылымына қажетті пәнаралық біліммен және заманауи зерттеу дағдыларымен қаруландыруға бағытталған инновациялық білім беру өнімі ретінде қызмет етеді.
Кіріспе
XXI ғасырдың басынан бастап ғылым мен технология қарқынды дамып, жаратылыстану және ақпараттық технологиялар салаларының түйіскен тұсында жаңа пәнаралық бағыттар пайда болуда. Солардың бірі – биология мен жасанды интеллекттің (ЖИ) интеграциясына негізделген биоинформатика мен деректер ғылымы бағытындағы зерттеулер. ЖИ технологиялары биологиялық деректерді өңдеу мен талдауда, күрделі жүйелерді модельдеуде, және медициналық-биологиялық міндеттерді шешуде тиімді құрал ретінде қалыптасып келеді.
Осы авторлық курс биология мен жасанды интеллект салаларының өзара байланысын, олардың болашақтағы ғылыми зерттеулердегі әлеуетін зерттеуге бағытталған. Бағдарлама аясында білім алушылар ЖИ-дің теориялық негіздерін меңгеріп қана қоймай, оларды биологиялық мәселелерді шешу үшін қолдануды тәжірибе жүзінде үйренеді. Сонымен қатар, курс оқушылардың зерттеушілік құзыреттерін дамытуға, пәнаралық ойлау қабілетін қалыптастыруға, заманауи ғылыми әдістермен жұмыс істеуге бейімдеуге мүмкіндік береді.
Бағдарлама мазмұны қазіргі ғылыми-практикалық талаптарға сай құрылып, оқушылардың болашақта биомедицина, биоинформатика, экология, биотехнология сияқты салаларда кәсіби бағдар алуына негіз болады.
Мақсаты:
Биологиялық ғылымдар мен жасанды интеллекттің тоғысқан тұсындағы өзекті ғылыми бағыттарды меңгерту арқылы білім алушылардың пәнаралық танымын кеңейту, биологиялық деректерді талдау және модельдеу үшін ЖИ әдістерін қолдануға машықтандыру, сондай-ақ зерттеушілік және жобалық қызметке бейімдеу.
Міндеттері:
-
Жасанды интеллекттің теориялық негіздерін (машиналық оқыту, нейрондық желілер, алгоритмдер) жүйелі түрде меңгерту.
-
Биологиядағы күрделі деректерді өңдеу мен талдауда ЖИ құралдарын қолданудың мүмкіндіктерін көрсету.
-
Биоинформатика, геномика, экология, молекулалық биология салаларында қолданылатын нақты ЖИ-бағытталған жобалармен таныстыру.
-
Python тілі және биоинформатикалық кітапханалар негізінде биологиялық мәліметтермен жұмыс істеу дағдыларын қалыптастыру.
-
Оқушылардың сыни ойлауын, ғылыми зерттеу жүргізу дағдыларын және пәнаралық құзыреттіліктерін дамыту.
-
Цифрлық сауаттылықты, ақпаратпен жұмыс істеу мәдениетін және деректерге негізделген шешім қабылдау қабілетін жетілдіру.
-
Оқушылардың болашақ кәсіби бағдарын (биотехнология, биомедицина, деректер ғылымы, т.б.) айқындауға ықпал ету.
Бағдарламаның тәжірибелік құндылығы:
«Жасанды интеллект және биологияның болашақ зерттеулері» бағдарламасының тәжірибелік құндылығы – білім алушылардың теориялық білімін нақты тәжірибелік әрекетпен ұштастыра отырып, оларды пәнаралық ғылыми-зерттеу дағдыларына баулуға бағытталғанында. Бағдарлама мазмұны биологиялық мәліметтерді талдау мен модельдеуде қолданылатын заманауи жасанды интеллект технологияларын меңгеруге мүмкіндік береді, бұл өз кезегінде оқушылардың болашақта кәсіби қызметке бейімделуіне негіз болады.
Курс барысында білім алушылар нақты деректермен жұмыс істей отырып, Python бағдарламалау тілі арқылы биоинформатикалық есептерді шешуді, мәліметтерді сандық өңдеуді, визуализация жасауды және қарапайым алгоритмдер құруды үйренеді. Мұндай дағдылар биология, медицина, экология, биотехнология және ақпараттық технологиялар салаларындағы қолданбалы зерттеулер мен практикалық жобаларда кеңінен қолданылады.
Бағдарламада ұсынылған практикалық тапсырмалар мен жобалық жұмыстар оқушыларды дербес ойлауға, ғылыми проблемаларды пәнаралық тәсілмен шешуге және өз жобаларын жоспарлап, нәтижесін негіздеп ұсынуға үйретеді. Сонымен қатар, оқушылар биологиялық және медициналық деректер қорларымен (мысалы, NCBI, EMBL, PubMed) жұмыс істеу дағдыларын меңгеріп, цифрлық сауаттылық пен ақпараттық мәдениетті дамытады.Осылайша, бағдарлама білім алушыларға болашақ ғылыми-зерттеу және инженерлік жобаларға қатысуға дайындық беріп, жоғары оқу орындары мен ғылыми орталықтардағы пәнаралық білім беру және ғылыми ортаға бейімделуіне мүмкіндік жасайды. Бағдарламаның тәжірибелік бағыттылығы – оны жаратылыстану және техникалық білім беру саласында қолдануға ыңғайлы, өмірлік маңызы бар дағдыларды қалыптастыратын заманауи білім беру құралы ретінде қарастыруға мүмкіндік береді.
Бағдарламаны оқытудан күтілетін нәтижелер:
Бағдарламаны меңгеру нәтижесінде білім алушылар жасанды интеллект пен биологияның тоғысқан тұсындағы пәнаралық мәселелерді түсініп, оларды ғылыми негізде талдай алуға қабілетті болады. Оқушылар жасанды интеллекттің теориялық негіздерін, оның ішінде машиналық оқыту, нейрондық желілер және деректерді өңдеу алгоритмдерін меңгеріп, оларды нақты биологиялық міндеттерді шешуде тиімді қолдануды үйренеді.
Биологиялық деректермен (геномдық, протеомдық, физиологиялық және экологиялық) жұмыс істеу дағдыларын игере отырып, білім алушылар Python бағдарламалау тілі және заманауи биоинформатикалық құралдар арқылы деректерді өңдеу, талдау және визуализациялау әдістерін практикада қолдана алады. Сонымен қатар, олар қарапайым жасанды интеллект модельдерін құру, оларды нақты биологиялық кейстерге бейімдеу және нәтижелерін ғылыми тұрғыдан интерпретациялау қабілеттерін қалыптастырады.
Оқушылардың зерттеушілік дағдылары да дамиды: олар ғылыми гипотеза құру, деректер жинау мен талдау, қорытынды жасау және нәтижені ғылыми тілде ұсыну іскерліктерін меңгереді. Бағдарлама қатысушылардың пәнаралық ойлау қабілетін, сыни көзқарасын, жобалық және командалық жұмыс дағдыларын жетілдіреді. Сонымен қатар, оқушылар биология, биотехнология, биомедицина, деректер ғылымы және жасанды интеллект салаларында болашақ кәсіби бағдарын саналы түрде айқындай алады.
Жалпы алғанда, бағдарлама оқушыларға ХХІ ғасырдың ғылымына тән пәнаралық құзыреттіліктерді игеруге, ғылыми-зерттеу жұмыстарына дайындық деңгейін арттыруға және заманауи технологияларды саналы қолдануға мүмкіндік береді.
Нормативтік бөлім
«Жасанды интеллект және биологияның болашақ зерттеулері» авторлық бағдарламасының күнтізбелік – тақырыптық жоспары:
|
Р/с |
Тақырыптар |
Сағат |
|
1 |
Жасанды интеллект және қазіргі биология |
1 |
|
2 |
Ферментативті катализде белсенді орталықтың ролі. Ферменттердің иммобилизациясы. Зертханалық жұмыс "Иммобилизациялаудың ферменттердің белсенділігіне әсерін зерттеу" |
1 |
|
3 |
Трансляция кезеңдері,нәруыз биосинтезі |
1 |
|
4 |
Генетикалық кодтың қасиеттері: үшөрімділігі,көптігі, әмбебаптығы, бірін-бірі жаппайтындығы |
1 |
|
5 |
Хлоропластың құрылымдық компоненттері және олардыңқызметтері |
1 |
|
6 |
Фотосинтездің жарық кезеңі |
1 |
|
7 |
Заттар тасымалының симпластық,апопластық,вакуолярлық жолдары мен олардың маңызы |
1 |
|
8 |
Биологиядағы басқару жүйесі |
1 |
|
9 |
Гормондардың әсер ету механизмі.Инсулин мысалында гормондардың нысана жасушаларға әсер ету механизмі |
1 |
|
10 |
Өсіргіш заттар .Өсіргіш заттардың өсімдіктерге әсер ету механизмі |
1 |
|
11 |
Гаметогенез.Адам гаметогенезінің сатылары |
1 |
|
12 |
Бағаналы жасушалар ұғымы және олардың қасиеттері |
1 |
|
13 |
Бағаналы жасушалардың түрлері :эмбриональды және соматикалық.Практикада қолданылуы |
1 |
|
14-15 |
ДНҚ-ның кездейсоқ мутациясы ,генетикалық үдеріс қателіктері,репликация.ДНҚ-ның кездейсоқ мутациясы,репарация,репкомбинация |
2 |
|
16 |
«Адам геномы» жобасы.Адамның геномдықДНҚ-сын секвенирлеу |
1 |
|
17 |
Микробиологиялық зерттеудің кезеңдері |
1 |
|
18 |
Зертханалық жұмыс: Сүт қышқылды өнімдердің әртүрлікоректікортадағы микрофлорасын зерттеу |
1 |
|
19 |
Грамм оң грамм теріс бактериялар және олардың құрылыс ерекшеліктері |
1 |
|
20 |
«Рекомбинативті ДНҚ » ұғымы,алутәсілдері,қолданылуы |
1 |
|
21 |
Плазмиданың қасиеттері және олардың генетикалық клондауда қолданылуы |
1 |
|
22 |
Электромагниттік дыбыс толқындарының адам ағзасына әсерету ерекшеліктері |
1 |
|
23 |
Эпигенетиканың молекулярлық негіздері негіздері,оның адамдағы салдарлары |
1 |
|
24 |
«Биоинформатика» ұғымы. Биоинформатикақұралдарын зерттеулерге қолдану |
1 |
|
25 |
Экстракорпоралды ұрықтандыру әдісі және оның маңызы |
1 |
|
26 |
Экстракорпоральды ұрықтандырудың этикалық аспектілері |
1 |
|
27 |
Моноклоналды антиденелер көмегімен ауруларды диагностикалау және емдеу |
1 |
|
28 |
Харди-Вайнберг генетикалық тепе-теңдік заңы.Сирек кездесетін және жойылып бара жатқан өсімдіктер мен жануарлардың түрлерін қорғау |
1 |
|
29 |
Экологиялық жағдайлар менэкологиялық есептерді шешу жолдары |
|
|
30 |
Жергілікті экожүйенің биоалуантүрлілігн анықтауда кездейсоқ іріктеу әдісінің маңызы |
1 |
|
31 |
Климаттың экологиядлық проблемалары және оны шешу жолдары дебат сабақ |
1 |
|
32 |
Ғаламдық жылыну оның себептерімен салдарлары ,шешу жолдары |
1 |
|
33 |
«Дебат: «Табиғат – ортақ үйіміз» (Атырау қаласы мысалында) |
1 |
|
34 |
«Жасыл желек -ауыл тынысы» жоба қорғау |
1 |
1 сабақ ҚМЖ
|
Ұзақ мерзімді жоспар бөлімі: |
Кіріспе бөлім |
||||||||||||||||||||
|
Күні: |
Мұғалімнің аты-жөні: |
||||||||||||||||||||
|
Сынып: 11 |
Қатысқандар саны: |
Қатыспағандар саны: |
|||||||||||||||||||
|
Сабақ тақырыбы |
Жасанды интеллект және қазіргі биология |
||||||||||||||||||||
|
Осы сабақта қол жеткізілетін оқу мақсаттары (оқу бағдарламасына сілтеме) |
ЖИ ұғымын және оның биологиядағы қолданылу бағыттарын түсіндіру, биологиядағы нақты мысалдар арқылы ЖИ қолданудың маңызын дәлелдеу.
|
||||||||||||||||||||
|
Сабақ мақсаттары |
ЖИ ұғымын және оның биологиядағы қолданылу бағыттарын түсінеді биологиядағы нақты мысалдар арқылы ЖИ қолданудың маңызын дәлелдейді
|
||||||||||||||||||||
|
Адал азамат» біртұтас тәрбие бағдарламасы құндылықтарын енгізу |
Академиялық шыншылдық, нақтылық, өзін өзі реттей білу , ойды реттей білу, сенімділік, дәлелдерді қолдана білу ,өзіне деген сенімділік, өзін-өзі көрсету болу құндылықтары дамытылады. |
||||||||||||||||||||
|
Сабақ барысы |
|||||||||||||||||||||
|
Сабақтың жоспарланған кезеңдері |
Сабақтағы жоспарланған іс-әрекет |
Ресурстар |
|||||||||||||||||||
|
Сабақтың басы 0-2 САБАҚТЫҢ ОРТАСЫ |
Қызығушылықты ояту – Жеке жұмыс (5 минут)Тапсырма 1. «ЖИ менің өмірімде» (жеке) Оқушы күнделікті өмірде кездесетін ЖИ мысалдарын жазады ЖИ қолданылатын биологиялық салалар (қысқаша шолу)
Қортынды ойларын айтады
ЖИ – биологияны жылдам, дәл және болашаққа бағытталған ғылымға айналдырады деп ойлаймыз
Жаңа білім – Мұғалім түсіндірмесіҒылыми негізде түсіндіру: презентациямен виожазбамен түсінік беру
ЖИ – бұл деректерді талдап, үйрену арқылы шешім қабылдайтын компьютерлік жүйе; Биологияда ЖИ үлкен деректермен (геном, ДНҚ, медициналық суреттер) жұмыс істейді;
ЖИ биоинформатика, медицина, экология, генетика салаларында қолданылады.
Нақты ғылыми мысалдар: ЖИ рентген және МРТ арқылы қатерлі ісікті анықтайды; Геномды талдау арқылы тұқым қуалайтын ауруларды болжайды; Ақуыз құрылымын болжау (AlphaFold Жұптық жұмысТапсырма 2. «Күнделікті өмір Ғылыми биология» (жұптық) Кестені толтыр:
Оқушы жауабтары ЖИ – бұл деректерді талдап, үйрену арқылы шешім қабылдайтын компьютерлік жүйе. Күнделікті өмірден:Face ID – бет-әлпетті таниды; YouTube – қызығушылығыңа сай видео ұсынады; Google Translate – мәтінді аударады. Биологиядағы дәл сол принцип:ЖИ мыңдаған медициналық суретті көріп үйренеді; Қалыпты мен ауру жасушаны ажыратуды үйренеді; Кейін жаңа дерекке өз бетінше шешім шығарады.
Айырмашылығы: Топтық жұмыс (12 минут)Тапсырма 3. «ЖИ биологияны қалай өзгертеді?» Әр топқа бір бағыт беріледі:
1-топ – Медицинадағы ЖИ Топтық жауаптардың нақты мазмұны: Медицина: ауруды ерте анықтау, дәрі таңдауды оңтайландыру; Генетика: ДНҚ тізбектерін салыстыру, мутацияны табу; Экология: жануарлар санын есептеу, климат өзгерісін болжау. Дескриптор: ЖИ қолданылатын саланы дұрыс сипаттайды – 1 балл Нақты ғылыми мысал келтіреді – 1 балл Топта бірлесіп постер/ауызша қорғау жасайды – 1 балл 1топ Медицинадағы ЖИАуруды ерте анықтау, дәрі таңдауды оңтайландыру Нақты мысалдар мен деректерҚатерлі ісікті ерте анықтау Google Health жасаған ЖИ маммография суреттері арқылы сүт безі обырын дәрігерлерге қарағанда 5–10% дәл анықтайды. ЖИ рентген, КТ, МРТ суреттеріндегі көзге көрінбейтін өзгерістерді табады. COVID-19 кезінде ЖИ өкпе КТ-сын талдап, аурудың ауырлығын алдын ала болжады. Кейбір елдерде диагноз қою уақыты 2–3 есе қысқарды. Дәрі таңдауды оңтайландыру (personalized medicine) ЖИ науқастың: жасы, генетикалық ерекшелігі,
бұрынғы аурулары Онкологияда бұл әдіс жанама әсерді азайтады. Қызықты дерекКейбір ЖИ жүйелері ауруды адам белгілерін сезбей тұрып анықтай алады. 2 топ Генетикадағы ЖИДНҚ тізбектерін салыстыру, мутацияны табу Нақты мысалдар мен деректер
ЖИ: BRCA1/BRCA2 мутацияларын анықтап, сүт безі обырының қаупін болжайды. Сирек генетикалық ауруларды (мысалы, муковисцидоз) анықтауда қолданылады. AlphaFold (DeepMind) Ақуыздардың 3D құрылымын болжады. Бұл жаңалық биологиядағы 50 жылдық мәселені шешті. Қызықты дерек2021 жылы AlphaFold 200 миллионнан астам ақуыз құрылымын болжады – бұл бүкіл тірі ағзалардың көп бөлігі. Экологиядағы ЖИЖануарлар санын есептеу, климат өзгерісін болжау Нақты мысалдар мен деректерЖануарларды санау Дрон + ЖИ арқылы: піл, кит, киік сияқты жануарлар автоматты саналады. Бұл әдіс адамға қарағанда 10 есе жылдам және қауіпсіз. Қызыл кітап түрлерін қорғау Камера-тұзақтағы миллиондаған суреттерді ЖИ сұрыптайды. Сирек жануарлар қозғалысы бақыланады. Климат өзгерісін болжау ЖИ: температура, жауын-шашын,
мұздықтардың еруі Қызықты дерекКейбір ЖИ модельдері орман өртін бірнеше күн бұрын болжай алады |
Презентация PowerPoint Слайд 1 Слайд 2-4
Презентация
(PowerPoint) Видео |
|||||||||||||||||||
|
Сабақтың соңы 39-40 мин |
Қорытынды және рефлексия«3–2–1» әдісі:
Үйге тапсырма «ЖИ болашақта биологияны қалай өзгертеді?» тақырыбына 5–6 сөйлемдік шағын эссе.
|
Слайд 8
|
|||||||||||||||||||
2 сабақ Қысқа мерзімді жоспар
|
Ұзақ мерзімді жоспар |
|
|
|
Күні: |
Мұғалімнің аты-жөні: |
|
|
|
Қатысқандар саны: |
Қатыспағандар саны: |
|
Сабақ тақырыбы |
Ферментативті катализде белсенді орталықтың ролі. Ферменттердің иммобилизациясы. Зертханалық жұмыс "Иммобилизациялаудың ферменттердің белсенділігіне әсерін зерттеу" |
|||||||||||
|
Осы сабақта қол жеткізілетін оқумақсаттары (оқу бағдарламасына сілтеме) |
11.4.1.2 - фермент-субстраткомплексініңтүзілумеханизмінтүсіндіру |
|||||||||||
|
Сабақ мақсаттары |
Оқушыларғафермент-субстраткомплексініңтүзілумеханизмінтүсіндіру |
|||||||||||
|
Бағалау критерийлері |
ОқушыларФермент пен субстраттың өзара әрекеттесуін түсінеді; Иммобилизациялаудың ферменттердің белсенділігіне әсерін зерттей алады; |
|||||||||||
|
Адал азамат» біртұтас тәрбие бағдарламасы құндылықтарын енгізу |
Академиялық шыншылдық, нақтылық, өзін өзі реттей білу , ойды реттей білу, сенімділік, дәлелдерді қолдана білу ,өзіне деген сенімділік, өзін-өзі көрсету болу құндылықтары дамытылады. |
|||||||||||
|
Сабақ барысы |
||||||||||||
|
Сабақтың жоспарланған кезеңдері |
Сабақтағы іс-әрекет
|
Ресурстар |
||||||||||
|
Сабақтың басы |
Сабақбасында: - оқушылардыңзейініншоғырландыруүшіналдыңғыбілімдерінтексерусұрақтары:
Жұппен жұмыс Тапсырма 1. Теориялық сұрақтар 1) Фермент дегеніміз не? 2) Белсенді орталық деген ұғымды түсіндіріңіз. 3) «Кілт–құлып» және «индукцияланған сәйкестік» модельдерін салыстырыңыз. 4) Иммобилденген ферменттер дегеніміз не? Дескриптор: – Фермент анықтамасын дұрыс береді;1б – Белсенді орталықтың қызметін сипаттайды;2б – Екі модельдің айырмашылығын көрсетеді; 2б – Иммобилизация ұғымын түсіндіреді. 1б Жеке жұмыс
Тапсырма 2. Сәйкестендіру тапсырмасы Ферменттер Субстраттар 1. Амилаза а) Крахмал 2. Интерфаза б) Сахароза Дұрыс жауабы: 1–а, 2–б Дескриптор: – Фермент пен субстрат арасындағы сәйкестікті дұрыс табады.2б - оқушылармен бірге бүгінгі зерттханалық сабақ мақсаттарын талдау, бағалау критерийлерімен таныстыру. |
Презентация
|
||||||||||
|
Сабақтың ортасы |
Зертханалықжұмыс "Иммобилизациялаудыңферменттердіңбелсенділігінеәсерінзерттеу" Мақсаты: Ферменттік -субстрат кешенінің түзілу механизмі түсіндіру Құрал-жабдықтар: 2%-дық крахмал және сахароза қоспасы, амилаза және интерфаза ферменттері. Болжам (болжамды жазу үшін сұраққа толық жауап беріңіз): Ферменттік-субстрат кешенінің түзудің жолы Қауіп-қатер:__________________________________________ ______________________________________________________ Нұсқаулық: Ферменттік реакция былай жүреді:
E + Е – фермент, S - субстрат ES – фермент-субстраттық кешен EP –фермент –өнім А, В – реакцияның соңғы өнімдері Фермент-субстрат кешенінің түзілуі ферменттің белгілі бір қасиеттеріне байланысты.Ферменттің белсенділігі стандартты жағдайларда ферменттің салмағына бір минутта өзгеріске ұшырайтын субстраттың мольдік санымен көрсетілетін молекулалық белсенділіктің шамасымен бағаланады. Жұмыстың барысы: 4 пробирка алып, 1-ші және 2-ші пробиркаларға 2мл 2%-тік крахмал қоспасын, ал 3-ші және 4-ші пробиркаларға 2мл сахароза қоспасын құямыз. Содан соң 1-ші және 3-ші пробиркаларға 0,5мл амилаза ферментін, ал 2-ші және 4-ші пробиркаларға 0,5мл интерфаза ферментін қосамыз. Пробиркалардағы қоспаларды жақсылап араластырып, 40º С-тық су буында 15 минут ұстаймыз. Одан кейін пробирканы суытып, йодпен және Троммер реакциясын жүргіземіз. Троммер реакциясы үшін 1мл ерітінді алынады, ал қалған ерітінділерге 2-3 тамшы йод ерітіндісін қосады. Тәжірибе қорытындысын 1-ші кестеге жазамыз
Ферменттердің белсенділігі биохимиялық қосылыстардың жылдамдығы әсерінен қарапайым түрде былай сипатталады: фермент субстрат өнім Бұл жерде амилаза Фермент, Крахмал субстрат, кейін өнім алынады Амилазаны крахмал қоспасы бар пробиркаға құйып жаймен шайқау керек
Қорытынды: Ферменттік субстрат кешенінің түзілу қалай жүзеге асады , жұмысты қорытындылау
.......................................................................................... Дескриптор: – Тәжірибені нұсқаулыққа сай жүргізеді;1б – Нәтижені кестеге дұрыс жазады;2б – Реакция нәтижесін түсіндіреді 1б
Тест тапсырмаларын орындайды
1. Ферменттің белсенді орталығы дегеніміз не?
A) Ферменттің барлық молекуласы Дұрыс жауап: B
2. Белсенді орталықтың субстратқа сәйкестігін түсіндіретін модель:
A) Энергетикалық модель Дұрыс жауап: B
3. Белсенді орталықтағы аминқышқылдарының негізгі ролі:
A) Ферменттің еруін арттыру Дұрыс жауап: B
4. Индуцирленген сәйкестік моделінің мәні неде?
A) Белсенді орталық өзгермейді Дұрыс жауап: C
5. Ферментативті катализ кезінде белсенді орталықта қандай байланыстар түзіледі?
A) Тек ковалентті Дұрыс жауап: C
6. Ферменттердің иммобилизациясы дегеніміз:
A) Ферменттің бұзылуы Дұрыс жауап: C
7. Иммобилизацияланған ферменттердің артықшылығы:
A) Белсенділігі әрдайым төмен Дұрыс жауап: C
8. Ферменттерді иммобилизациялаудың бір әдісі:
A) Қыздыру Дұрыс жауап: C
9. Иммобилизацияланған ферменттер көбіне қай салада қолданылады?
A) Астрономияда Дұрыс жауап: B
10. Иммобилизацияның кемшілігі болып табылады:
A) Ферменттің толық жойылуы Дұрыс жауап: B
|
https://youtu.be/ISf6ClTbg78
|
||||||||||
|
Сабақтың соңы |
Сабақсоңындаоқушыларбағалау критерийлеріне оралу арқылы рефлексияжүргізеді: ОқушыларФерментпенсубстраттыңөзараәрекеттесуін түсінеді; Иммобилизациялаудың ферменттердің белсенділігіне әсерін зерттей алады; - нені білдім, нені үйрендім - нені толық түсінбедім - немен жұмысты жалғастыру қажет
Оқушылар өздерінің жұмысы мен сыныптастарының жұмысын белгілі бір критерийлер бойынша бағалай алады |
|
||||||||||
3 сабақ Қысқа мерзімді жоспар
|
|
|
|||||||||||||||||||||||||||||||||||||||||||||||||||||||||||||||||
|
Күні: |
Мұғалімнің аты-жөні: |
|||||||||||||||||||||||||||||||||||||||||||||||||||||||||||||||||
|
|
Қатысқандар саны: |
Қатыспағандар саны: |
||||||||||||||||||||||||||||||||||||||||||||||||||||||||||||||||
|
Сабақ тақырыбы |
Трансляция кезеңдері,нәруыз биосинтезі |
|||||||||||||||||||||||||||||||||||||||||||||||||||||||||||||||||
|
Осысабақтақолжеткізілетіноқумақсаттары |
ДНҚ молекулаларындағы ақуыздардың құрылымдық ақпараттардың кодтауын көрсету нәруыз синтезі процесін сипаттау |
|||||||||||||||||||||||||||||||||||||||||||||||||||||||||||||||||
|
Сабақ мақсаттары |
11.4.1.3 - Нәруыз биосинтез кезеңдерін сипаттайды |
|||||||||||||||||||||||||||||||||||||||||||||||||||||||||||||||||
|
Бағалау критерийлері |
Транскрипция және трансляция үрдістерін кемінде сегіз сөзді пайдаланып сипаттайды Ақуыз синтезі процесін түсіндіреді |
|||||||||||||||||||||||||||||||||||||||||||||||||||||||||||||||||
|
Адал азамат» біртұтас тәрбие бағдарламасы құндылықтарын енгізу |
Академиялық шыншылдық, нақтылық, өзін өзі реттей білу , ойды реттей білу, сенімділік, дәлелдерді қолдана білу ,өзіне деген сенімділік, өзін-өзі көрсету болу құндылықтары дамытылады. |
|||||||||||||||||||||||||||||||||||||||||||||||||||||||||||||||||
|
Сабақ барысы |
||||||||||||||||||||||||||||||||||||||||||||||||||||||||||||||||||
|
Сабақтың жоспарланған кезеңдері |
Сабақтағы жоспарланған іс-әрекет |
Ресурстар |
||||||||||||||||||||||||||||||||||||||||||||||||||||||||||||||||
|
Сабақтың басы
|
(W) Алдыңғы өтілген ақуыз синтезінің кезеңдерін топтардың естеріне түсіру үшін сұрақтар қойылады |
ноутбукте түрлі –түрлі сызбаларды қарау, қажетті қосымша ақпараттарды іздеп тауып ала білу дағдылары |
||||||||||||||||||||||||||||||||||||||||||||||||||||||||||||||||
|
Сабақтың ортасы
Сабақтың ортасы |
(Р) оқушылар жұбына жеке тапсырмалар беріліп, оқушылар әр кезеңді сызбалап түсіндіреді. 1жұп-трансляция кезеңдерін жалпы сипаттау 2жұп-генетикалық ақпараттың ДНҚ дан кодталуы 3жұп- тРНҚ құрылысы 4жұп-инициация 5жұп-элонгация 6жұп-терминация Нәруыз синтезі туралы видеолар көрсетіледі
(G) (f) Жұптарға трансляция кезеңдері бейнелген суреттері мен түсініктемелері жазылған карточкалар жиынтығын беріледі. Оқушылар карточкаларды логикалық тәртіпте орналастырады. Оқушылар жұбы басқа жұптарға сұрақтар қояды.
|
https://www.youtube.com/watch?v=eik96kz5Kn4
|
||||||||||||||||||||||||||||||||||||||||||||||||||||||||||||||||
|
|
|
|||||||||||||||||||||||||||||||||||||||||||||||||||||||||||||||||
|
Сабақтың ортасы
|
Оқушылар транскрипциядан бастап, нәруыз синтезінің кезеңдерін жалпылама түрде модельдейді. Ең маңызды кезеңдеріне, яғни маңызды процесстеріне тоқталулары тиіс.
Карточкалар жиынтығын дайындаңыз. Әр карточкада нәруыз синтезінің бір кезеңінің қысқаша сипаттамасы болуы керек. Топтардағы оқушыларға кезеңдердің ретін (тәртібін) - егер олар әлі өтілмеген болса да логиканы пайдаланып табу керек. 2-бөлім. Карточкалар жиынтығы
3-бөлім. Қорытынды тест тапсырмалары
Карточкалардың көшірмелері жасалғасын, кезекті (тәртібін) тексергеннен кейін, оқушылар оларды өз кітаптарында қалдыра алады. Олардан бүкіл процесті – генетикалық кодтан бастап, гемоглобин түзілгенге дейін толық пысықтау талап етіледі. Бұл оларға нәруыздар ұйымдасуының 4 кезеңін көруге мүмкіндік береді. Түрлі топтарға түрлі ақуыздарды беруге болады. Оқушылар модельде түсіндіреді1-МОДЕЛЬ: «ТАҒАМ → ҚАН → СҮЙЕК КӨМІГІ → ГЕМОГЛОБИН Кеңейтілген жұмыс: гемоглобинде темірдің қалай пайда болатындығы сұралады 1 модель
1-кезең. Темірдің тағамнан түсуі Темір адам ағзасына тағам арқылы түседі: • ет, бауыр (гемдік темір) • бұршақ, жасыл өсімдіктер (гемдік емес темір) ? Бұл кезеңде темір Fe³⁺күйіндеболады. Дескриптор: • темірдің тағамнан түсетінін біледі • темірдің бастапқы күйін атай 2модель
2-кезең. Ішекте темірдің сіңірілуі Аш ішекте темір Fe³⁺ → Fe²⁺ түріне айналып, қанға өтеді.
Қанда темір арнайы
тасымалдаушы ақуыз – Дескриптор:
3 модель
3-кезең. Темірдің қоры Артық темір бауырда жинақталады. Ол жерде темірді сақтайтын ақуыз – ферритин. Дескриптор: • темірдің қор ретінде сақталатынын біледі • ферритиннің қызметін түсіндіреді
4 модель
Сүйек кемігінде гем түзілуі Қызыл сүйек кемігінде темір гем молекуласының ортасына орналасады. Гем – гемоглобиннің негізгі бөлігі, оның ортасында Fe²⁺ионыболады. Дескриптор: • гемнің құрылымдық рөлін түсіндіреді • темірдің гемге кіретінін көрсетеді СҰРАҚ (КЕҢЕЙТІЛГЕН ОЙЛАУҒА) Неліктен гемоглобиндегі темір Fe²⁺ күйінде болуы керек? Себебі Fe²⁺ ғана оттекті қайтымды түрде байланыстыра алады.
Бағалау үшін қысқа дескриптор (қорытынды)
тест тапсырмасы 1. Трансляция дегеніміз не?A) ДНҚ-ның
екі еселенуі Дұрыс жауап: B
2. Трансляция қай жасушалық құрылымда жүреді?A) Ядро Дұрыс жауап: C
3. Трансляцияның бірінші кезеңі:A) Элонгация Дұрыс жауап: C
4. Инициация кезінде бірінші болып қандай кодон танылады?A) UAA Дұрыс жауап: C
5. AUG кодоны қандай аминқышқылын кодтайды?A) Глицин Дұрыс жауап: C
6. Трансляция кезінде аминқышқылдарын рибосомаға жеткізетін РНҚ:A) мРНҚ Дұрыс жауап: B
7. Элонгация кезеңінде не жүреді?A) Рибосома мРНҚ-дан ажырайды Дұрыс жауап: B
8. Трансляцияның аяқталуы (терминация) қашан жүреді?A) Старт-кодонға жеткенде Дұрыс жауап: B
9. Стоп-кодондарға қайсысы жатады?A) AUG Дұрыс жауап: C
10. Нәруыз биосинтезінің соңғы нәтижесі:A)
РНҚ молекуласы Дұрыс жауап: C
|
|
||||||||||||||||||||||||||||||||||||||||||||||||||||||||||||||||
|
Сабақтың соңы |
Рефлексия - ненібілдім, неніүйрендім - ненітолықтүсінбедім - немен жұмыстыжалғастыруқажет |
|
||||||||||||||||||||||||||||||||||||||||||||||||||||||||||||||||
4 сабақ ҚМЖ
|
Ұзақ мерзімді жоспар бөлімі: Молекулярлықбиология жәнебиохимия
|
Мектеп: |
||||||||||||||
|
Күні: |
Мұғалімнің аты-жөні: |
||||||||||||||
|
Сынып:11 |
Қатысқандар саны: Қатыспағандар саны: |
||||||||||||||
|
Сабақ тақырыбы |
Генетикалықкодтың қасиеттері: үшөрімділігі,көптігі, әмбебаптығы, бірін-бірі жаппайтындығы |
||||||||||||||
|
Осы сабақта қол жеткізілетін оқу мақсаттары (оқу бағдарламасына сілтеме) |
11.4.1.5 - генетикалық кодтың қасиеттерін түсіндіру |
||||||||||||||
|
Сабақ мақсаттары |
Генетикалық кодтың қасиеттерін түсінеді |
||||||||||||||
|
Бағалау критерийлері |
|
||||||||||||||
|
Адал азамат» біртұтас тәрбие бағдарламасы құндылықтарын енгізу |
Академиялық шыншылдық, нақтылық, өзін өзі реттей білу , ойды реттей білу, сенімділік, дәлелдерді қолдана білу ,өзіне деген сенімділік, өзін-өзі көрсету болу құндылықтары дамытылады. |
||||||||||||||
|
Сабақ барысы |
|||||||||||||||
|
Сабақтың жоспарланған кезеңдері |
Сабақтағы жоспарланған іс-әрекет
|
Ресурстар |
|||||||||||||
|
Сабақтың басы |
Оқушылармен амандасу. Оқушылардың зейінін сабаққа аударту. Мұғалім сабақ тақырыбымен таныстырады. - оқушылармен бірге сабақ мақсаттарын/ОМ анықтап алу, сабақ соңында күтілетін нәтижелерді анықтау |
|
|||||||||||||
|
Сабақтың ортасы Сабақтың ортасы Сабақтың ортасы |
Оқушылардың
алдыңғы білімін тексеруге арналған
сұрақтар
Миға шабуыл: Гендеген не? Ген қайда орналасады? Генетикалық код не үшін керек? Топтық жұмыс Оқушыларды екі топқа бөлу. Әрбір топқа дидактикалық материалдар беріледі, сол бойынша кластер құрастыру 1 топ: Генетикалықкодтың қасиеттері: үшөрімділігі,көптігі 2 топ: Генетикалықкодтың қасиеттері: әмбебаптығы, бірін-бірі жаппайтындығы Критерий:
1-тапсырма. КЛАСТЕР ҚҰРАСТЫРУ (В деңгей) Тапсырма: «Генетикалық кодтың қасиеттері» тақырыбына кластер құрастырыңыз. Кластерде төмендегі қасиеттер міндетті түрде қамтылсын: Үшөрімділігі Көптігі Кластер мазмұнына қойылатын талаптар: Анықтамасы Мысал Маңызы Бағалау критерийі Генетикалық код қасиеттерін дұрыс анықтайды Кластерді логикалық байланыстырады Дескриптор Үшөрімділікке анықтама береді Көптік қасиетін түсіндіреді Әр қасиетке мысал келтіреді
Бұл схема: мРНҚ кодондары аминқышқылдардың кодталуы трансляция үдерісін көрсетеді Дұрыс жауап Үшөрімділігі – бір аминқышқылды 3 нуклеотид (кодон) кодтайды Көптігі – бір аминқышқылды бірнеше кодон кодтай алады (мысалы: лейцин – 6 кодон)
Әрбір топ жұмыстарын қорғайды және келесі топ бағалау жүргізеді Мұғалім кері байланыс беріп өтеді Тақырып: Генетикалық кодтың қасиеттері: әмбебаптығы, бірін-бірі жаппайтындығы 1. Генетикалық кодтың жалпы схемасы
Бұл схема кодон →
аминқышқыл принципін
көрсетеді. 2. Үшөрімділік қасиетінің схемасыНуклеотидтер: A U G | C C U Кодондар: AUG | CCU
Мағынасы: 1 кодон =
3 нуклеотид 3. Көптік (дегенерация) қасиетінің схемасыЛейцин аминқышқылы:
UUA, UUG, CUU, CUC,
CUA, CUG 4. Әмбебаптық қасиетінің схемасы
AUG
→ метионин (адам,
өсімдік,
бактерия) 5. Бірін-бірі жаппайтындығыAUG | GCU | UAC
Кодондар қабаттаспайды,
әр нуклеотид бір рет қолданылады. 2-тапсырма. САЛЫСТЫРУ (С деңгей)
Тапсырма:
Бағалау критерийі
Дескриптор
Өздік жұмыс: Оқушылар тақырыпқа байланысты тапсырмала орындайды Тақтада марк схема көрсетіледі оқушылар өзін-өзі бағалайды
Бекіту Оқушыларға 2 түрлі деңгейдегі В және С тапсырмалар беріледі (Дифференцация) Тақтада марк схема көрсетіледі жұптар бірін-бірі тексереді
3-тапсырма. ТЕСТ (В деңгей)
1. Генетикалық кодтың үшөрімділігі дегеніміз: A) Бір аминқышқылды бір кодон кодтайды B) Үш нуклеотид бір аминқышқылды кодтайды C) Бір кодон бірнеше аминқышқылды кодтайды D) Кодондар қабаттасады
Дұрыс жауап: B
Тақырып: Генетикалық кодтың қасиеттері: әмбебаптығы, бірін-бірі жаппайтындығы
1-тапсырма. КЛАСТЕР ҚҰРАСТЫРУ (В деңгей)
Тапсырма:
Кластер құрамында болсын:
Бағалау критерийі
Дескриптор
Жауап
2-тапсырма. ТАЛДАУ (С деңгей)
Тапсырма: Бағалау критерийі
Дескриптор
Жауап:
3-тапсырма. ТЕСТ (С деңгей)
1. Генетикалық кодтың бірін-бірі
жаппайтындығы нені білдіреді? Дұрыс жауап:C ҚОРЫТЫНДЫ ДИФФЕРЕНЦИАЦИЯ
Тест тапсырмасы
|
Ppt
https://infourok.ru/sabati-tairibi-genetikali-kod-859005.html
Презентация
Презентация
Презентация
Презентация
Слайд 12
Слайд 14 |
|||||||||||||
|
Сабақтың соңы |
Рефлексия: оқушылар тақырыпқа байланысты:
|
|
|||||||||||||
![]()
5-сабақ ҚМЖ
|
Ұзақ мерзімді жоспар бөлімі: Қоректену |
Мектеп: |
|||||||||||||||||||||||||||||||||||
|
Күні: |
Мұғалімнің аты-жөні: |
|||||||||||||||||||||||||||||||||||
|
Сынып: 11 |
Қатысқандар саны: |
Қатыспағандар саны: |
||||||||||||||||||||||||||||||||||
|
Сабақ тақырыбы |
Хлоропластың құрылымдық компоненттері және олардың қызметтері. Фотосинтездің пигменттері. |
|||||||||||||||||||||||||||||||||||
|
Осы сабақта қол жеткізілетін оқу мақсаттары (оқу бағдарламасына сілтеме) |
хлоропластың құрылымы мен қызметі арасындағы өзара байланысты орнату |
|||||||||||||||||||||||||||||||||||
|
Сабақмақсаттары |
Оқушылар орындай алады: хлоропласттың құрылымын және оның құрамдас бөліктерінің қызметтерімен өзара байланысын сипаттап түсіндіреді. |
|||||||||||||||||||||||||||||||||||
|
Бағалау критерийлері |
|
|||||||||||||||||||||||||||||||||||
|
Адал азамат» біртұтас тәрбие бағдарламасы құндылықтарын енгізу |
Академиялық шыншылдық, нақтылық, өзін өзі реттей білу , ойды реттей білу, сенімділік, дәлелдерді қолдана білу ,өзіне деген сенімділік, өзін-өзі көрсету болу құндылықтары дамытылады. |
|||||||||||||||||||||||||||||||||||
|
Сабақбарысы |
||||||||||||||||||||||||||||||||||||
|
Сабақтыңжоспарланғанкезеңдері |
Сабақтағыжоспарланғаніс-әрекет |
Ресурстар |
||||||||||||||||||||||||||||||||||
|
Сабақтың басы 0-10 мин. |
Ұйымдастыру кезеңі Ынтымақтастық атмосферасын орнату. 1.Хлоропласт құрылымы мен қызметі арасындағы байланысты қалыптстыру мақсатында оқушылардан хлорпласт құрлысы туралы бұрынғы білімдерін қолдана отырып жұпта сипаттама құрасыруды ұсынылады. 2.Өсімдіктегі пигменттер түрлерін атаңыз және олардың құрылыс арасындағы айырмашылықтар қандай? 3.Қандай өсімдіктерде пигмент көбірек кездесуі мүмкін? 4.Каротин, ксантрофилл, хлорофилл а, хлорофилл b, каротиноид пигменттеріне сипаттама беріңіз. Тақырып пен оқыту мақсаты, сабақтың мақсаттары, бағалау критерийлері тұжырымдалады. Жұптық жұмыс тапсырмасы (Алдыңғы білімді қолдану) Тапсырма: Бағыттаушы сұрақтар:
2. Бағалау критерийлері № Критерий Дескриптор 1 Хлорпласт құрылысын сипаттайды Грана, тилакоид, строманы атайды 2 Пигменттерді ажыратады Хлорофилл, каротиноидтарды атайды 3 Салыстырады Айырмашылығын түсіндіреді
3. Кластер (мәтіндік үлгі)ХЛОРПЛАСТ |
РРТ
|
||||||||||||||||||||||||||||||||||
|
11-16 мин.
17-25 мин.
26-37 мин. |
(Ұ) Оқушыларға «хлоропласт» анықтамасына ассоциативті сөздерді тауып, бір-біріне айтады. Сосын оқушыларға бұл органоидтің құрылысы, қызметі мен маңызын өзара байланыстыруы ұсынылады. КБ: мұғалім әр оқушыға көмек көрсетеді. (М)Оқушыларға хлоропласттың электронды суреті көрсетіледі. Мұғалім хлоропластың құрылысы түсіндіреді. Хлоропласттың құрылысы, түрлері оның атқаратын қызметтерімен байланыс жүргізіледі. Фотосинтездің пигменттерімен оқушыларды таныстырылады.
4. Өсімдік пигменттері (кесте)
ҚБ: Келесі, оқушыларға топтық жұмыс ұсынылады (әр топқа тапсырмалар беріледі). Топтық жұмысты бағалау критерийлері (топ атынан бағалау критерийлерді қосуға болады): - нақты ақпарат беру; -қосымша материалдарды пайдалану; -топ мүшелерінің жұмысқа қатысуы; -қорғау уақытын сақтау ... (Т)1 топ оқушылары хлоропластың моделін құрастырады. Ал 2 топ оқушылары хлоропластың суретін салады.
Әр топ бір-бірін бағалау критерийлер арқылы бағалайды. КБ: мұғалім әр топтың жұмысын бағалайды. ҚБ: оқушыларға тапсырмалар таратылады.
Қай өсімдіктерде пигмент көп кездеседі? Пигменттер көп кездеседі:
ТЕСТ ТАПСЫРМАЛАРЫ
III бөлім. Бағалау критерийлері мен дескрипторлар
|
Хлоропласт туралы ақпарат (орыс тілінде) http://biologylib.ru/books/item/f00/s00/z0000009/st189.shtml
Хлоропласттың моделін жасау үшін қажетті құралдары: түсті ермексаз, түсті картон қағаз, қарындаштар, маркерлер. Хлоропласттың моделін жасауы бойынша видео (ағылш.): https://www.youtube.com/watch?v=mwPfTOCxt3w Тапсырмалар |
||||||||||||||||||||||||||||||||||
|
Сабақтың соңы: 38-40 мин. |
Рефлексия Мен сабақта ......................................білдім Бәріненде маған................................ұнады Мен үшін пайдалы ақпарат...........болды Мен ...................................................тілеймін Менің ұсыныстарым........................................ Үйге: хлоропласт туралы ақпарат жасау. |
|
||||||||||||||||||||||||||||||||||
6 -сабақ ҚМЖ
|
Ұзақмерзімдіжоспарбөлімі: |
Қоректену |
||||||||||||||||||||||||||||||||||||||||||||||||||||||
|
Күні |
Мұғалімнің аты-жөні: |
||||||||||||||||||||||||||||||||||||||||||||||||||||||
|
Сынып: 11 |
Қатысқандар саны: |
Қатыспағандар саны: |
|||||||||||||||||||||||||||||||||||||||||||||||||||||
|
Сынып: |
Қатысқандар саны: |
Қатыспағандар саны: |
|||||||||||||||||||||||||||||||||||||||||||||||||||||
|
Сабақ тақырыбы |
Фотосинтездің жарық кезеңі |
||||||||||||||||||||||||||||||||||||||||||||||||||||||
|
Осы сабақта қол жеткізілетін оқу мақсаттары (оқу бағдарламасына сілтеме) |
11.1.2.2 - фотосинтездің жарық кезеңінде өтетін үдерістерді түсіндіру |
||||||||||||||||||||||||||||||||||||||||||||||||||||||
|
Сабақ мақсаттары |
фотосинтездің жарық кезеңінде өтетін үдерістерді түсіндіре алады |
||||||||||||||||||||||||||||||||||||||||||||||||||||||
|
Адал азамат» біртұтас тәрбие бағдарламасы құндылықтарын енгізу |
Академиялық шыншылдық, нақтылық, өзін өзі реттей білу , ойды реттей білу, сенімділік, дәлелдерді қолдана білу ,өзіне деген сенімділік, өзін-өзі көрсету болу құндылықтары дамытылады. |
||||||||||||||||||||||||||||||||||||||||||||||||||||||
|
Сабақ барысы |
|||||||||||||||||||||||||||||||||||||||||||||||||||||||
|
Сабақтың жоспарланған кезеңдері |
Сабақтағы жоспарланған іс-әрекет |
Ресурстар |
|||||||||||||||||||||||||||||||||||||||||||||||||||||
|
Сабақтың басы 0-1 1-3 мин
3-5мин |
1. (К) ұйымдастыру сәті, оқушылардың сабаққа дайындығын тексеру.
«миға шабуылын»жүргізіңіз. Сұрақтар қойыңыз: * Хлоропласт матриксі неден тұрады? * Граннің негізгі функциясын атаңыз? Сабақ тақырыбына оқушылардың жауаптарын берді . |
Үлестірме материал (тест тапсырмалары), MS PowerPoint презентация |
|||||||||||||||||||||||||||||||||||||||||||||||||||||
|
Сабақтың ортасы (пайымдау) 5
|
1.мұғалім оқушылармен келесі сұрақтар бойынша әңгіме өткізеді: 1-тапсырма (ЖЕКЕ ЖҰМЫС) Әдіс: ЖИ көмегімен түсіндіру + ойлау картасы Фотосинтездің жарық фазасында жүретін негізгі үдерістерді түсінуPowerPoint презентация Тапсырма мазмұны: Оқушы ЖИ (ChatGPT, Copilot, Gemini т.б.) көмегімен келесі сұрақтарға жауап алады, содан кейін дәптеріне ойлау картасын (mind map) сызады. «Фотосинтездің жарық фазасында қандай үдерістер жүреді? Оларды ретімен қысқаша түсіндіру Сұрақтар беру * Фотосинтез терминін қалай түсінесіз? * Фотосинтез өнімі не болып табылады? * Фотосинтездеуші ағзалар органикалық заттарды неде түзеді? Сұрақтарды талқылау барысында тақтада мұғалім оқушылардың көмегімен Фотосинтездің жалпы теңдеуін құрайды. Мұғалім слайдта Фотосинтездің жиынтық теңдеуін көрсетеді. Фотосинтездегі үдерістер бір қарағанда неғұрлым күрделі ағымға ие екенін хабарлайды. Дескриптор: фотосинтездің жарық фазасының кемінде 4 үдерісін атайды 1б негізгі терминдерді (фотолиз, АТФ, НАДФН) қолданады2б ақпаратты логикалық байланыспен ұсынады 3б
2-тапсырма (ЖҰПТЫҚ ЖҰМЫС
– Әдіс: Think–Pair–Share + ЖИ-менсалыстыру Циклдікжәнециклдікемесфотофосфорилденудісалыстыру Тапсырма Жұптағыәроқушыәртүрлісұраққояды. 1-оқушы: «Циклдікфотофосфорилденудегенне?» 2-оқушы: «Циклдікемесфотофосфорилденуқалайжүреді?»
Дескриптор:
3-тапсырма (ЖЕКЕ → ЖҰП ) Әдіс: ЖИ көмегімен модельдеу Фотосинтездің жарық фазасын модельдеу Оқушы ЖИ-ге келесі тапсырманы береді: «Фотосинтездің жарық фазасының қарапайым модель сипаттамасын бер»
Содан кейін:
Модельде болуы тиіс:
Жұптық жұмыс: Фотосинтездің жарық фазасының динамикалық моделін құру
Нұсқаулық Келесі реакцияларға назар аударыңыз: • Жарық фазасы: фотолиз, АТФ синтезі. Қосымша НАДФ қалпына келтіру мен тотығуды қарастыруға болады.
Мұғалім оқушыларға екі фотожүйенің жұмыс сызбасын таратады, оқушылар бұл сызбаны бір-біріне түсіндіреді. Талқылау сыныпта. (К) оқушылар Фотосинтездің Жарық фазасы туралы бейнені көреді(5мин 04сек). Талқылау: * АТФ қалай құрылады? * АТФ синтезі, АТФ-синтазаның жұмысы үшін протондар қайдан алынады? Бұл протондар қайда орналасқан? * АТФ қайда босатылады? * НАДФ қалпына келтіру үшін протондар қайдан алынады? * НАДФН қайда босатылады? Оқушылар жұпта бірігіп, қағаз, стикер, стрелкалар арқылы фотосинтездің жарық фазасының динамикалық моделін құрастырады. Төмендегі кесте бойынша модель элементтерін орналастырып, жауаптарын толықтырыңыз.
.Дескриптор:
өз моделін дәлелдеп түсіндіреді Жарық фазалардың негізгі кезеңдерін түсіндіре отырып, анимацияны көрсетіңіз.
мұғалім әр жұпқа
келеді, оқушылардың түсініктерін тыңдайды және кері байланыс
береді. (И,П) оқушылар циклдық және циклдық емес фотофосфорлау туралы материал (оқулықтан үзінділер) алады. Алдымен материалдың бір бөлігімен жеке жұмыс істейді,содан кейін жұпта бұл ақпаратты бір-біріне ауызша түрде береді.
Оқушы ЖИ көмегімен терминдерге анықтама алады, бірақ өз сөзімен жазады.
Дескриптор:
тест тапсырмасы
|
MS PowerPoint презентация MS PowerPoint презентация
MSPowerPoint презентация
Анимацияо фотосинтезе (англ.): https://www.youtube.com/watch?v=prFaSe3s9e0 Бейнежазба 1)https://www.youtube.com/watch?v=pFaBpVoQD4E (на англ яз) 4мин 53сек или 2)https://www.youtube.com/watch?v=GgtflsxIgsg (на рус яз) 4мин 11сек
https://www.youtube.com/watch?v=1-uifqyHm88&list=PLNaLMqSph0LbHyqqZSteoN7a5bpJPjLIH&index=6 (5.04) Циклдық және циклдық емес фотофосфорлау туралы Мәтін, схема. апсырмалар |
|||||||||||||||||||||||||||||||||||||||||||||||||||||
|
Сабақтың соңы (рефлексия) 39-40 мин. |
Үй тапсырмасы Фотосинтездің Жарық фазасы кезінде не болып жатқанын түсіндіре білу.
Мен енді түсіндім
|
|
|||||||||||||||||||||||||||||||||||||||||||||||||||||
7 –сабақ ҚМЖ
|
Ұзақмерзімдіжоспарбөлімі: |
|
|||||||||||||||||||||
|
Күні |
Мұғалімнің аты-жөні: |
|||||||||||||||||||||
|
Сынып: |
Қатысқандар саны: |
Қатыспағандар саны: |
||||||||||||||||||||
|
Сынып: |
Қатысқандар саны: |
Қатыспағандар саны: |
||||||||||||||||||||
|
Сабақ тақырыбы |
Заттар тасымалдануының симпласттық, апопласттық, вакуолярлық жолдары және олардың маңызы |
|||||||||||||||||||||
|
Осы сабақта қол жеткізілетін оқу мақсаттары (оқу бағдарламасына сілтеме) |
11.1.3.2 - заттар тасымалданудың симпласттық, апопласттық, вакуолярлық жолдарының мәнін түсіндіру |
|||||||||||||||||||||
|
Сабақ мақсаттары |
|
|||||||||||||||||||||
|
Адал азамат» біртұтас тәрбие бағдарламасы құндылықтарын енгізу |
Академиялық шыншылдық, нақтылық, өзін өзі реттей білу , ойды реттей білу, сенімділік, дәлелдерді қолдана білу ,өзіне деген сенімділік, өзін-өзі көрсету болу құндылықтары дамытылады. |
|||||||||||||||||||||
|
Сабақ барысы |
||||||||||||||||||||||
|
Сабақтың жоспарланған кезеңдері |
Сабақтағы жоспарланған іс-әрекет |
Ресурстар |
||||||||||||||||||||
|
Сабақтың басы (үндеу)
1-3мин |
Амандасу. I. Ұйымдастыру кезеңі (2 минут)
Әдіс: «Ой
шақыру»
Апопласттық тасымалдау
Әдіс: Түсіндірмелі әңгіме + визуалды
схема
Симпласттық тасымалдау
Әдіс: «Сұрақ–жауап» Мазмұны: Заттар цитоплазма арқылы Плазмодесмалар арқылы бір жасушадан екіншісіне өтеді Мембранадан бір рет өтеді Маңызы: Тасымал реттеледі, таңдамалы вакуолярлық тасымалдау
Әдіс: «Миға
шабуыл» Заттар мембрана → цитоплазма → вакуоль арқылы өтеді
Әр жасушада бірнеше
мембранадан өтеді
Жеке жұмысТапсырма 1. Сәйкестендіру (жеке)
Дұрыс жауап: Дескриптор:Тасымал жолдарын дұрыс сәйкестендіреді – 1 балл Барлық жауап дұрыс – 2 балл
|
MS PowerPoint презентация таратпа материал |
||||||||||||||||||||
|
3-8мин
8-13мин
13-30мин
30-33мин
33-38 мин |
(С) Оқушыларға өсімдік жасушасының суретін дұрыс салуды және құрылысын жазуды тапсырыңыз.
Оқушылар үшін тақтаға өсімдік жасушасының суретін құрылымдық бөліктерімен бірге салыңыз, келесі тақтаға қателіктерін түзете отырып салыңыз. Салған жасуша қабырғасынан Каспари белдемшесін бояп көрсетіңіз және Каспари белдемшесі су жолын бөгейтін өткізбейтін барьер екендігін түсіндіріңіз.
(М) Оқушыларға өсімдік тамырының анатомиялық құрылысын түсіндіріңіз.
Оқушылардан өсімдік жасушалары арқылы қоректік заттардың өтуінің 3 жолын әр түрлі түсті пайдалану арқылы сурет салуды сұраңыз.
(Т)Тасымалдау жолдарының ерекшеліктері туралы кластер құруды ұсыну Бағалау критерийлері: * суретте симпласттық, апопласттық, вакуолярлық су тасымалдау жолдарын белгілейді; * кластерде өсімдіктердегі су тасымалдануының әрбір жолының мәнін көрсету керек. Жұптық жұмыс Тапсырма 2. Салыстырмалы кесте құру
Дұрыс жауап үлгісі Апопласттық – жасуша қабырғасы, мембранадан өтпейді
Дескриптор:
Жұптық жұмыс
Сонымен қоса заттарды тасымалдау жолдарын сіріңке қорапшасына сұйықты қапшықтар салу (вакуольді түсіндіру үшін) арқылы модельдеуге болады.
Бағалау: өзара топтық бағалау Тасымалдау жолдарының атауларын есте сақтау үшін анимация көрсетіледі. Оқушылардан өздеріне берілген жолдарды толық түсіндіруді сұраңыз, мысалы осмос/жеңілдетілген диффузия болса анықтамасын айтуды ұсыныңыз.
Тест тапсырмасы
|
MS PowerPoint презентация Өсімдіктердегі заттардың тасымалы жөнінде теориялық материалдар мен суреттер: 1)http://www.ebio.ru/org12.html 2)http://biologylib.ru/books/item/f00/s00/z0000018/st176.shtml апопласт симпласт вакуолярлық жолдар
Тамырдың құрылысы жөнінде видеоматериал: https://www.youtube.com/watch?v=vbgId5p14EM Судың қозғалысы жөнінде видеоматериал: https://www.youtube.com/watch?v=JFb-CWlz7kE(1мин 20с)
А3, маркерлер Макет үшін (сіріңке қорапшасы, сұйықты қапшықтар)
тасмалдаудың үш жолын да көрсететін интерактивті анимация (өзіңіз қарағыңыз келетінін таңдап алыңыз): http://www.kscience.co.uk/animations/transpiration.htm
|
||||||||||||||||||||
|
Сабақтың соңы (рефлексия) 38-40 мин. |
Үй тапсырмасы Параграф оқу(қажет болған жағдайда презентацияны қайта қарау). Терминдердің анықтамаларын білу. Апопласт, вакуолярлы, симпластты транспорт түрлері.
Рефлексивті экран Әрбір оқушы экрандағы сөздерді бір сөзбен кезегімен жалғастырады. : 1.Мен бүгін білдім… 2.Қызықты болды… 3.Қиын болды… 4.Мен тапсырманы орындадым… 5.Мен түсіндім, келесіні… 6.Енді мен білемін… 7.Мен істейалдым… |
|
||||||||||||||||||||
8 сабақ ҚМЖ
|
Ұзақ мерзімді жоспар бөлімі 11.2 В Басқару және реттеу |
Мектеп : |
||||||||||||||||||||||
|
Күні : |
Мұғалімнің аты-жөні |
||||||||||||||||||||||
|
Сынып: 11 |
Қатысқандар саны: |
Қатыспағаны |
|||||||||||||||||||||
|
Тақырыбы: |
Басқару жүйелері |
||||||||||||||||||||||
|
Осы сабақта орындалатын оқу мақсаттары |
Биологиядағы басқару жүйелері. Биологиядағы «басқару жүйесі» түсінігін қалыптастыру |
|
|||||||||||||||||||||
|
Оқу мақсаты |
Биологиядағы басқару жүйелері |
|
|||||||||||||||||||||
|
Бағалау критерийлері |
1. Гомеостазды анықтайды 2. Биологиядағы басқару жүйесінің негізгі компоненттерін анықтайды; 3. Оң және теріс кері байланыс арасындағы айырмашылықты сипаттайды; 4. Адамдарда глюкоза мен дене температурасының қалай бақыланатынын сипаттайды |
|
|||||||||||||||||||||
|
Адал азамат» біртұтас тәрбие бағдарламасы құндылықтарын енгізу |
Академиялық шыншылдық, нақтылық, өзін өзі реттей білу , ойды реттей білу, сенімділік, дәлелдерді қолдана білу ,өзіне деген сенімділік, өзін-өзі көрсету болу құндылықтары дамытылады. |
|
|||||||||||||||||||||
|
Жоспар |
|
||||||||||||||||||||||
|
Жоспарланған сабақ кезеңдері |
Сабақтағы іс шаралар |
Ресурстар |
|
||||||||||||||||||||
|
Сабақтың басы
Сабақтың ортасы |
Сәлемдесу. "Шаттықшеңбері" коллаборативтіортанықұру» Ой толғау Мұғалім жабық көзімен сурет салуды (кез келген) ұсынады. - Сіздің суретіңіз қаншалықты дәл? Неліктен? Теориялық көпір (мұғалімнің бағыттауы) Негізгі ұғым: Кері байланыс – реттеуіш жүйенің өз қызметінің нәтижесі туралы ақпарат алуы. Мысал: • Қандағы глюкоза ↑ → инсулин бөлінеді → глюкоза ↓ (теріс кері байланыс) Ағзаны тиімді басқару үшін реттеуіштер өз қызметінің нәтижелері туралы үнемі ақпарат алуы тиіс. Мұндай ақпаратты беру кері байланыс деп аталады. "Биологиядағы басқару жүйесі" сабағы. Сабақтың мақсатын бірлесіп анықтау. Білімді өзектендіру – «Миға шабуыл» (3 минут) Сұрақтар: 1. Гомеостаз дегеніміз не? 2. Реттелудің қандай түрлерін білесің? 3. Қандай реттеуші жүйелер бар?
Оқушы жауаптарының үлгісі: • Гомеостаз – ағзаның ішкі ортасының тұрақтылығы • Жүйкелік, гуморальдық (эндокриндік), иммундық реттел Мұғалім оқушыларды 3 топқа біріктіреді (түрлі – түсті жетондар) - материалдың қиындық деңгейі бойынша, ақпарат көзі бойынша дифференциация. Активити 1 Тапсырма: үш реттеуші жүйенің бірінің сызбасын немесе сөздік суретін құрастыру: жүйке, эндокриндік және иммундық. 1 топ – жүйке 2 топ – эндокриндік 3 топ – иммундық (деңгейі жоғары оқушылар, интернет көздерін пайдалана алады).
Топтың тиімді жұмыс істеуі үшін ағзадағы реттелудің негізгі принципі сипатталатын ақпараттық парақтарды үлестіру. Топтарды оқығаннан кейін өз интерпретациясында осы процестің схемасын жасайды. Активити 1. Топтық жұмыс Тапсырма:
1-топ – Жүйкелік реттелу (жауап үлгісі) Тітіркендіргіш → рецептор → сезгіш нейрон → ми/жұлын → қозғалтқыш нейрон → жауап 2-топ – Эндокриндік реттелу (жауап үлгісі) Өзгеріс → эндокриндік без → гормон → қан → нысана-мүше → жауап 3-топ – Иммундық реттелу (жауап үлгісі) Антиген → лейкоциттер → антидене түзілу → бөгде зат жойылады → жады жасушалары Дескрипторлар Жүйке жүйесінің жұмыс схемасы жасалды Эндокриндік жүйенің жұмыс схемасы жасалды Иммундық жүйенің жұмыс схемасы жасалды Проблемалық сұрақ Сұрақ: Дәлелді жауап Бұл жүйелер бір-бірімен тығыз
байланысты.
Қорытынды: ағза – біртұтас басқару жүйе
С. В. Барабановтың реттеу сызбасымен жұмыс
|
|
|
||||||||||||||||||||
|
|
Тапсырма:
Кері байланыс сұрағы:
Жеке тапсырма (үлгі):
«Иммундық реттелудің ағзадағы рөлі» тақырыбында Бағалау дескрипторы:
Жеке тапсырма Реттелу жүйелерін салыстыру, байланысын анықтау. «Үш реттеуші жүйені салыстыратын кестені құрыңдар»
Дескриптор: 1.Салыстыру толық – 2 балл 2.Ұқсастық/айырмашылық көрсетілген – 1 балл 3.Кесте/диаграмма сауатты – 1 балл Жұппен жұмыс Проблемалық сұрақтар Мына проблемалық жағдайды талдаңдар: «Стресс кезінде ағзада қандай реттеуші жүйелер қатар іске қосылады Жауап Жүйке жүйесі – қауіпті сезеді Эндокриндік жүйе – адреналин бөледі Иммундық жүйе – уақытша әлсірейді Бұл жүйелер бір-бірімен келісіп жұмыс істейді
Тест тапсырмасы
|
|
|
|
|||||||||||||||||||
|
|
|
||||||||||||||||||||||
|
38-39 мин |
Рефлексия "2 жұлдыз 1 тілек» |
|
|
||||||||||||||||||||
|
39-40 мин
|
Үй тапсырмасы.
|
|
|
||||||||||||||||||||
|
|
|
||||||||||||||||||||||
9 – сабақ ҚМЖ
|
Бөлім: Координация мен реттеу |
|
|||||||||||||||||||||||||||||||||||||
|
СЫНЫП: 11 |
Қатысушылар саны: |
Келмегендер: |
||||||||||||||||||||||||||||||||||||
|
Сабақтың тақырыбы |
Гормондардың әсер ету
механизмі. |
|||||||||||||||||||||||||||||||||||||
|
Оқыту мақсаттары |
11.1.7.2 - гормондардың әсер ету механизмін түсіндіру |
|||||||||||||||||||||||||||||||||||||
|
Сабақтың мақсаты |
гормондардың әсер ету механизмін түсіндіру |
|||||||||||||||||||||||||||||||||||||
|
Бағалау критерийлері |
- гормондардың қасиеттері мен гормоналды қабылдау түрлерін біледі; - инсулин мен эстрогеннің нысана-жасушаларға әсер ету механизмінің сызбаны жасай алады; - инсулин мен эстрогеннің нысана-жасушаларға әсер ету механизмін (ауызша және жазбаша) сипаттай алады; - инсулин мен эстрогеннің нысана-жасушаларға әсер ету механизмінің ұқсастығы мен айырмашылығын анықтай алады. |
|||||||||||||||||||||||||||||||||||||
|
Сабақ жоспары |
||||||||||||||||||||||||||||||||||||||
|
Сабақта жоспарланған кезеңдер |
Сабақтағы жоспарланған іс-әрекет
|
Ресурстар |
||||||||||||||||||||||||||||||||||||
|
Сабақтың басы
Сабақтың ортасы
|
«AI-сұрақгенераторы» арқылыОй шақыру 0-3 мин
ЖИ көмегімен интерактивті сұрақтар Сұрақтар:
Күтілетін
жауап: 2-кезең. Жаңа білімді меңгеру (интерактивті түсіндіру) 2.1 Гормондардың қасиеттері жеке жұмыс кестені толықтыру
Жеке тапсырма
(ЖИ):
2.2 Гормондардың жасушаға әсер ету механизмдері Жұптық тапсырма
1-жұп: Мембраналық механизм (инсулин) ? 2-жұп: Жасушаішілік механизм (эстроген)
Топтық жұмыс
Зерттеу және түсіндіру Тапсырма: «ЖИ + менталдық карта» Оқушылар инсулин немесе эстроген бойынша менталдық карта жасайды. Міндетті терминдер:
Дескриптор: гормон түрін дұрыс анықтайды әсер ету жолын кезең-кезеңімен көрсетеді терминдерді орынды қолданады топ мүшелерінің барлығы қатысады
Бейнематериалды көріп өзарапікіралмасу Гормонның әрекеті: жасуша сигналы түсіндіріледі
Инсулин және стероидты гормондар механизмі
Жеке жұмыс – Венн диаграммасы Тапсырма: «Инсулин мен эстрогеннің әсер ету механизмдерін салыстыр»
Бағалау дескрипторы:
Жеке жұмыс Тест тапсырмалары
|
Оқу презентациясы 1-15слайд
https://www.youtube.com/watch?v=QoSeNhcAbx4
Слайд 15-17 Қосымша 4 |
||||||||||||||||||||||||||||||||||||
|
Сабақтың соңы Рефлексия 39-40мин
|
Оқушылар бағалау критерийлері бойынша сабақтың мақсатына жетуді талқылайды. Ү/ж: қайталау. |
|
||||||||||||||||||||||||||||||||||||
10-сабақ ҚМЖ
|
Ұзақ мерзімді жоспар бөлімі: 11.2 B Координация және реттелу |
Мектеп: |
|||||||||||||||||||||||||||||
|
Күні: Мұғалім: |
||||||||||||||||||||||||||||||
|
Сынып: 11 |
Қатысқандар саны: Қатыспағандар саны: |
|
||||||||||||||||||||||||||||
|
Сабақ тақырыбы |
Өсіргіш заттар. Өсіргіш заттардың өсімдіктерге әсер ету механизмі. Ауксин әсері. |
|||||||||||||||||||||||||||||
|
Осы сабақта қол жеткізілетін оқу мақсаттары (оқу бағдарламасына сілтеме) |
11.1.7.3 - өсімдіктердің өсуіне стимуляторлардың (өсіргіш заттар) әсер етуін зерттеу |
|||||||||||||||||||||||||||||
|
Сабақ мақсаттары |
Өсімдіктердің өсуіне стимуляторлардың (өсіргіш заттар) әсер етуін зерттеу |
|||||||||||||||||||||||||||||
|
Бағалау критерийлері |
Оқушылар жаңа терминдерге сипаттама береді, өсімдіктердің өсуіне өсіргіш заттардың әсерінің механизмін түсіндіреді. Оқушылар өсімдіктерге гормондардың әсерін сипаттайды және түсіндіреді. |
|||||||||||||||||||||||||||||
|
Бастапқы білім |
Жүйке жасушасы, ұлпа, жүйке жүйесі: 7-10 сыныптар. Эндокринді жүйе: 7-10 сыныптар. |
|||||||||||||||||||||||||||||
|
Сабақ барысы |
||||||||||||||||||||||||||||||
|
Сабақтың жоспарланған кезеңдері |
Сабақтағы жоспарланған іс-әрекет |
Ресурстар |
||||||||||||||||||||||||||||
|
Сабақтың басы 1-5 мин
5-10 мин
Сабақтың ортасы
10-15
|
1.Өткен тақырыптың өзектілігі. «Сәйкестендіру»Тапсырма (жұптық):
|
|||||||||||||||||||||||||||||
|
Гормон |
Қызметі |
|
1. Ауксин |
A. Жапырақтың түсуін тежейді |
|
2. Цитокинин |
B. Жасушаның созылуын күшейтеді |
|
3. Этилен |
C. Қартаюды баяулатады |
|
4. Абсциз қышқылы |
D. Жапырақ түсуін тездетеді |
Дұрыс
жауабы:
1–B, 2–C, 3–A, 4–D
Дескриптор:
-
гормон мен қызметін дұрыс сәйкестендіреді – 1 б
-
ЖИ берген түсіндірмені қысқаша жазады – 1 б
-
биологиялық терминдерді қолданады – 1 б
Проблемалық сұрақ
Жеке жұмыс
Сұрақ:
«Егер өсімдікте ауксин
мүлде түзілмесе, қандай өзгерістер болар
еді?»
Оқушы ЖИ-ден 3
болжам алып, соның
ішінен ең ғылыми
негізделгенін таңдайды.
Мүмкін болатын жауап:
-
Өсімдік бойы аласа болады
-
Жасушалар созылмайды
-
Тропизмдер байқалмайды
Дескриптор:
-
кемінде 2 ғылыми дәлел келтіреді – 2 б
-
себеп–салдар байланысын көрсетеді – 1 б
Сабақ мақсатын қалыптастыру (Жұптық)
Тапсырма::
«Өсімдік гормондары
тақырыбына SMART форматында сабақ мақсатын құрастыр»
жауап:
Өсімдік гормондарының түрлерін анықтап, олардың өсу мен дамудағы рөлін түсіндіру.
Дескриптор:
-
мақсат нақты – 1 б
-
өлшенетін – 1 б
-
тақырыпқа сай – 1 б
Мұғалім түсіндірмесі + визуал тапсырма
Өсіргіш заттар. Өсіргіш заттардың өсімдіктерге әсер ету механизмі. Ауксин әсері
Мұғалім сабақтың негізгі тірек терминдерін түсіндіреді. Сонымен қатар өсімдіктің өсуіндегі және дамуындағы ауксиннің ролін түсіндіреді. Оқушылар дәптерге ауксиннің өсімдік жасушаларына әсерінің суретін салу қажет.
Оқу таныстырылымы
презентация
15-25 мин
25-35 мин
35-38 мин
4.Мұғалім түсіндірмесі. Өсіргіш заттар. Өсіргіш заттардың өсімдіктерге әсер ету механизмі. Ауксин әсері
Мұғалім сабақтың негізгі тірек терминдерін түсіндіреді. Сонымен қатар өсімдіктің өсуіндегі және дамуындағы ауксиннің ролін түсіндіреді. Оқушылар дәптерге ауксиннің өсімдік жасушаларына әсерінің суретін салу қажет.



Жеке жұмыс:
Оқушы дәптерге:
-
өсімдік жасушасын
-
ауксиннің біржақты жиналуын
-
жасушаның созылуын
сызба түрінде салады.
Дескриптор:
-
суретте гормон бағыты көрсетілген – 1 б
-
жасуша созылуы белгіленген – 1 б
Топтық жұмыс (зерттеу)
«Гормон + өмірлік жағдай»
|
Топ |
Гормон |
сұрақ |
|
1 |
Цитокинин |
Қартаюға қалай әсер етеді? |
|
2 |
Гиббереллин |
Сабақтың өсуін қалай арттырады? |
|
3 |
Абсциз қышқылы |
Стресте неге маңызды? |
|
4 |
Этилен |
Жемістің пісуін қалай реттейді? |
Постерде болуы керек:
-
гормонның қызметі
-
нақты мысал
-
схема / сурет
Дескриптор:
-
ғылыми дәлдік – 2 б
-
көрнекілік – 1 б
-
түсіндіру сапасы – 1 б
Қорғау кезіндегі тыңдаушыларға тапсырма (Жеке)
Тапсырма:
Әр топтан 1 жаңа факт жаз немесе мини-сызба сал.
Дескриптор:
4 гормон бойынша ақпарат жазылған – 2 б
қысқа әрі нақты – 1 б
да әртүрлі өсімдік гормондарын зерттеу қажет.
7. «Шындық/Жалған»
Оқушылар өз жетістіктерін «Шындық/Жалған» тапсырмасы арқылы тексере алады.
(Өзін-өзі бағалау)
|
Тұжырым |
Ш/Ж |
|
Ауксин жасушаның созылуын арттырады |
Ш |
|
Этилен – газ тәрізді гормон |
Ш |
|
Абсциз қышқылы өсу стимуляторы |
Ж |
|
Цитокинин қартаюды баяулатады |
Ш |
Дұрыс
жауаптар:
Ш, Ш, Ж, Ш
Тест тапсырмасы

Қосымша 1
Маркерлер, А3 форматындағы қағаздар, ноутбуктер
Қосымша 2
Сабақтың соңы
38-40
Кері байланыс:
Мұғалім сабақ мақсатына оралып, критерийлердің орындалу деңгейін талқылайды. Оқушылар сабақ барысында жақсы іске асқан немесе қиындық туғызған мәселелерді анықтайды.
стикерлер
11 сабақҚМЖ
|
Бөлім: |
11.2 Көбею |
|
Педагогтің аты-жөні: |
|
|
Күні: |
|
|
Сыныбы: |
Қатысушылар саны: Қатыспағандар саны: |
|
Сабақтың тақырыбы: |
Гаметогенез.Адам гаметогенезінің сатылары |
|
Оқу бағдарламасына сәйкес оқу мақсаты |
11.2.1.1 - адам гаметогенезінің сызбасын талдау |
|
Сабақтың мақсаты: |
Адам гаметогенезінің сызбасын талдап үйренеді. |
|
Адал азамат» біртұтас тәрбие бағдарламасы құндылықтарын енгізу |
Академиялық шыншылдық, нақтылық, өзін өзі реттей білу , ойды реттей білу, сенімділік, дәлелдерді қолдана білу ,өзіне деген сенімділік, өзін-өзі көрсету болу құндылықтары дамытылады. |
Сабақтың барысы:
|
Сабақ кезеңі/Уақыты |
Педагогтің іс-әрекеті |
Ресурстар |
||||||||||||||||||||
|
Сабақтың басы Қызығушылықты ояту. |
(Ұ). Ұйымдастыру кезеңі: 1. Оқушылармен амандасу, түгендеу. .Қызығушылықты ояту (ЖИ + визуал әдіс)
Проблемалық сұрақ Неліктен сперматогенез бен овогенез нәтижесінде түзілетін гаметалардың саны мен құрылысы әртүрлі? Оқушылар өз болжамдарын айтады (ауызша, ой шақыру). |
Оқулық, жұмыс дәптері Кітап, дәптер, қалам суреттері бейнеленген қима қағаздар топтамасы (Қазіргі жағдайда) ДК экраны |
||||||||||||||||||||
|
Жаңа сабаққа кіріспе
|
ЖИ көмегімен интерактивті түсіндіру Мұғалім гаметогенездің дайын сызбасын көрсетіп, ЖИ арқылы:
|
Өз ойын дұрыс мағынада білдіріп, талқылауға белсенділікпен қатысқан оқушыға «Жарайсың!» деген мадақтау сөзімен ынталандыру. |
||||||||||||||||||||
|
Сабақтың ортасы Мағынаны ашу. 26 мин. |
ЖЕКЕ ТАПСЫРМА (деңгейлік) 1-тапсырма. «Сызбаны талда» Берілген сызба бойынша кестені толтыр.
Дескриптор:
|
Тапсырма бойынша интернет құралдарын пайдаланып видео көру |
||||||||||||||||||||
|
|
ЖҰПТЫҚ ТАПСЫРМА 2-тапсырма. Венн диаграммасы Сперматогенез бен овогенезді салыстыр Ортақ белгілері:
Айырмашылықтары:
Дескриптор: КЕСТЕМЕНЖҰМЫС 3-тапсырма. Толықтыр
Дескриптор:
|
ДК экраны 11-сынып оқулығы. Жұмыс дәптерлері.
Бейнежазба презентация |
||||||||||||||||||||
|
|
Тест тапсырмалары
|
ДК экраны 11-сынып оқулығы. Жұмыс дәптерлері. |
||||||||||||||||||||
|
Сабақтың соңы Ой толғаныс. Рефлексия
|
Кері байланыс: Мұғалім сабақ мақсатына оралып, критерийлердің орындалу деңгейін талқылайды. Оқушылар сабақ барысында жақсы іске асқан немесе қиындық туғызған мәселелерді анықтайды |
|
11- ҚМЖ
|
Бөлім 11.2С Өсу және даму |
Мектеп: |
||||||||||||||||||
|
Күні: |
Мұғалімнің аты-жөні: |
||||||||||||||||||
|
Сыныбы:11 |
Қатысушылар саны: |
Қатыспағандар: |
|||||||||||||||||
|
Сабақ тақырыбы |
Бағаналы жасушалар ұғымы және олардың қасиеттері (қайта жаңаруы, жіктелуі). |
||||||||||||||||||
|
Осысабақтақолжеткізілетіноқумақсаттары (оқубағдарламасынасілтеме) |
11.2.3.1 - бағаналы жасушалардың мамандану үдерісін және олардың практикалық қолданылуын түсіндіру |
||||||||||||||||||
|
Сабақ мақсаты |
Оқушылар: Сабақ барысында бағаналы жасушалар ұғымы мен олардың жаңаруы мен жіктеліуін танып біледі. |
||||||||||||||||||
|
Бағалау критерийлері |
|
||||||||||||||||||
|
Сабақ барысы |
|||||||||||||||||||
|
Сабақтың жоспарланған кезеңдері |
Сабақтағы жоспарланған іс-әрекет
|
Ресурстар |
|||||||||||||||||
|
Сабақтың басы 5минут |
Ой-қозғау: Адам денесінде эритроциттер шамамен 100—120 күн аралығында өмір сүреді, кейін тіршіліктері макрофагтарды арқасында жойылады. Бірақ, адамның қанында үнемі жаңа эритроциттер үнемі пайда болады.
Оқушылармен бірлесе ой қозғау арқылы, бүгінгі сабақтың тақырыбы, оқыту мақсаты және сабақ мақсаттары талқыланады. |
Презентация Слайд 3 |
|||||||||||||||||
|
Сабақтың ортасы |
I. Жеке жұмысТапсырма 1. «Ақылды түсіндірме»
Нұсқау:
Формат: 5–6 сөйлем, тірек сөздермен Дескриптор:
|
Ақпарат парақшасы |
|||||||||||||||||
|
|
I. Жұптық жұмыс Тапсырма 2. «Сәйкестендіру + мысал»
Дескриптор:
|
|
|||||||||||||||||
|
|
Тапсырма 3. «Диалогтық түсіндіру»
Нұсқау: «Неге плюрипотентті жасушалар барлық ұлпаны түзбейді?» Дескриптор:
I. Топтық жұмыс (күрделі, ойлау дағдысы жоғары) Тапсырма 4. «Видео + Талдау» Нұсқау:
Презентация құрылымы (5 слайд):
Дескриптор:
Тапсырма 5. «Проблемалық жағдай»
Жағдай: Қандай типті бағаналы жасуша тиімді? Неліктен? Дескриптор:
Тест тапсырмалары
|
«Сornel» әдісі негізіндегі жұмыс парағы 1,2
YouTube «Stem cell differentiation» |
|||||||||||||||||
|
Сабақтың соңы
|
Рефлексиямұғалімнің сұрақ қоюы негізінде жүзеге асады:
Үй тапсырмасы: рефератдайындау |
|
|||||||||||||||||
13 сабақ ҚМЖ
|
11.2С Өсу және даму |
|
||||||||||||||||||||||||||||||||||
|
Күні: |
Мұғалім: |
||||||||||||||||||||||||||||||||||
|
Сыныбы |
қатысушылар саны: |
қатыспаушылар саны: |
|||||||||||||||||||||||||||||||||
|
Сабақ тақырыбы |
Бағаналы жасушалардың түрлері: эмбрионалды және соматикалық |
||||||||||||||||||||||||||||||||||
|
Сабақтажүзеге асырылатын оқу мақсаты |
11.2.3.1 бағаналы жасушалардың мамандану үдерісін және олардың практикалық қолданылуын түсіндіру |
||||||||||||||||||||||||||||||||||
|
Сабақ мақсаттары |
* бағаналы жасушалардың түрлерінсипаттау; * бағаналы жасушалардың түрлерінсалыстыру. |
||||||||||||||||||||||||||||||||||
|
Бағалау критерийлері |
- бағаналы жасушалардың сипаттамаларын көрсетеді; - бағаналы жасушалардың ұқсастығы мен айырмашылықтарын сипаттайды. |
||||||||||||||||||||||||||||||||||
|
Адал азамат» біртұтас тәрбие бағдарламасы құндылықтарын енгізу |
Академиялық шыншылдық, нақтылық, өзін өзі реттей білу , ойды реттей білу, сенімділік, дәлелдерді қолдана білу ,өзіне деген сенімділік, өзін-өзі көрсету болу құндылықтары дамытылады. |
||||||||||||||||||||||||||||||||||
|
Сабақ жоспары |
|||||||||||||||||||||||||||||||||||
|
Сабақтың кезеңдері |
Сабақта орындалуы тиіс іс -әрекеттер |
Оқыту ресурстары |
|||||||||||||||||||||||||||||||||
|
0-10 |
1. Топтық жұмыс (жоғары деңгей – талдау, синтез) ? Тапсырма: «AI + Видео + Талдау»
Мұғалім ЖИ көмегімен
дайындалған 2–3 минуттық ғылыми
видеоны көрсетеді
Топтарға бөліну:
Орындау:
Дескриптор:
2. Жұптық жұмыс (салыстыру, логикалық ойлау) Тапсырма: «Салыстырмалы кесте + AI» Жұпта AI көмегімен төмендегі кестені толтырыңдар:
Дескриптор:
3. Жеке жұмыс (ойлау дағдысы – бағалау) Тапсырма: «Ғылыми пікір» Сұрақ: Неліктен соматикалық бағаналы жасушалар медицинада этикалық тұрғыдан жиі қолданылады? Жауапты AI-мен тексеріп, жетілдіреді. Дескриптор:
Шығармашылық тапсырма (жоғары деңгей) Тапсырма: «AI-инфографика / презентация»
AI (Canva, Gamma) көмегімен 5 слайдтық презентация жаса:
Дескриптор:
10 ТЕСТ ТАПСЫРМАСЫ
|
презентация Stem cells: types and differentiation видео ғылыми
ChatGPT / Copilot – ақпаратты талдау, салыстыру, сұрақ құрастыру AI video generator (Pictory, Canva AI) – ғылымибейнероликқарау AI презентация (Gamma, Canva) – инфографикаменжұмыс
|
|||||||||||||||||||||||||||||||||
|
35 - 40 |
Рефлексия «551» |
|
|||||||||||||||||||||||||||||||||
14-15 сабақ ҚМЖ
|
Тұқым қуалаушылық және өзгергіштік заңдылықтары |
|
|||
|
Тақырыбы: |
ДНҚ-ның кездейсоқ мутациясы ,генетикалық үдеріс қателіктері,репликация.ДНҚ-ның кездейсоқ мутациясы,репарация,репкомбинация |
|||
|
Күні: |
Мұғалімнің аты-жөні: |
|||
|
Сынып: 11 |
Қатысушылар саны: |
Қатыспағандар: |
||
|
Осы сабақ арқылы жүзеге асырылатын оқу мақсаттары |
Мутацияның ДНҚ репарациясымен, ДНҚ рекомбинациясымен, сонымен қатар ДНҚ репликациясымен байланысын табу |
|||
|
Бағалау критерийлері |
Оқушы оқу мақсатына жетеді, егер; Мутациия, ДНК репарациясын, ДНК рекомбинациясын, ДНК репликациясын біледі және түсінеді. Мутацииямен кем дегенде бір ДНК репарациясын, ДНК рекомбинациясын, ДНК репликациясы арасындағы байланысты сипаттайды. |
|||
|
Адал азамат» біртұтас тәрбие бағдарламасы құндылықтарын енгізу |
Академиялық шыншылдық, нақтылық, өзін өзі реттей білу , ойды реттей білу, сенімділік, дәлелдерді қолдана білу ,өзіне деген сенімділік, өзін-өзі көрсету болу құндылықтары дамытылады. |
|||
|
Сабақ барысы |
||||
|
Сабақ қезеңдері |
Жоспарланғаніс-әрекеттер |
Оқыту көздері мен ресурстар |
||
|
0-7 минут |
Ұйымдастыру кезеңі. Қызығушылықты ояту (10 минут) Проблемалық сұрақ: «Егер жасушада қателіктерді түзететін механизмдер болмаса, тірі ағзалар қандай күйге түсер еді?»
Күрделібейне (5 мин):
ЖИқолдану:
«Бұлбейнедемутацияныңқайкезеңдепайдаболуқаупіжоғары?» Топқа бөлу: |
Презентация
DNA replication errors and repair mechanisms» (молекулалықдеңгейдеанимация) |
||
|
Сабақтың Басы Сабақтың ортасы
|
Жаңабілімдімеңгеру (20 минут) Мұғалімніңтүсіндірмесі + презентация
Негізгібайланыс: Егеррепликациякезіндеқатекетіп, репарацияонытүзетпесе → мутациясақталады Топтықжұмыс (20 минут) Тапсырма: «Генетикалықбайланыскартасы» Бұл топ оқушылары мейлінше интернет көзімен жұмыс жасап,берілген тапсырма бойынша ақпаратттар жинақтап, слайд жасайды. Оқушыларға ұсынылатын материалдар:
ДНҚ репарациясының негізгі қасиеттері Әр топ:
Дескриптор:
Жұптық жұмыс (15 минут) Тапсырма: «Себеп–салдар» Берілген жағдаятты талдау: «Репликация кезінде тиминнің орнына гуанин жалғанды. Репарация жүйесі істен шықты. Қандай нәтиже болады?» Жауапты:
Дескриптор:
VI. Жеке жұмыс (10 минут) «3–2–1» әдісі
Тест тапсырмалары
|
https://www.youtube.com/watch?v=vNXFk_d6y80
https://www.youtube.com/watch?v=-jjCjdvJTSw
https://www.youtube.com/watch?v=vNXFk_d6y80 Қосымша 1 Кестелер, суреттер, сызбанұсқалар
|
||
|
|
||||
|
87-90 минут |
Кері байланыс. «Пирамида» Үйге тапсырма беру:Мутацияның ДНҚ репарациясымен, ДНҚ рекомбинациясымен, сонымен қатар ДНҚ репликациясымен өзара байланысын өз сөздерімен баяндама дайындау |
|
||
16 сабақ ҚМЖ
|
|
Мектеп: |
|||||||||||||
|
Күні: |
Мұғалімніңаты-жөні: |
|||||||||||||
|
Сынып: 11 |
Қатысқандарсаны:Қатыспағандарсаны: |
|||||||||||||
|
Сабақтақырыбы:Адам геномдық ДНК- ын секвенерлеу |
||||||||||||||
|
Осы сабақта қол жеткізілетін оқу мақсаттары |
11.2.4.3- «Адам геномы» жобасының маңызын талдау |
|||||||||||||
|
Сабақмақсаттары |
«Адам геномы» жобасы аясында жүргізілген зерттеулердің маңызы |
|||||||||||||
|
Жетістік критерийлері |
|
|||||||||||||
|
Адал азамат» біртұтас тәрбие бағдарламасы құндылықтарын енгізу |
Академиялық шыншылдық, нақтылық, өзін өзі реттей білу , ойды реттей білу, сенімділік, дәлелдерді қолдана білу ,өзіне деген сенімділік, өзін-өзі көрсету болу құндылықтары дамытылады. |
|||||||||||||
|
Сабақбарысы |
||||||||||||||
|
Сабақтың Жоспарлан-ған кезеңдері |
Сабақтағыжоспарланғаніс-әрекет |
Ресурстар |
||||||||||||
|
Сабақтыңбасы 3 мин. |
І. Ұйымдастыру кезеңі. Қызығушылықты ояту – проблемалық видео Видео:Human Genome Project Explained (3–4 мин) Проблемалық сұрақтар:
Жеке ойлану – 1 мин, жұпта талқылау – 3 мин, ортақ жауап – 3 мин
|
Видео:Human Genome Project Explained |
||||||||||||
|
Сабақтың ортасы |
ІІ. Жаңа тақырып. Мұғалім түсіндірмесі: Таратпа материал
Мұғалімнің қысқаша түсіндірмесі + презентация Негізгі мазмұн:
Бейнебаян. DNA sequencing – 3D III. Топка бірігу. Оқушыларды 3 топқа бөлу: 1-топ: Секвенерлеу технологиялары 2-топ: «Адам геномы» жобасының кезеңдері 3-топ: Геномдық зерттеулердің қолданылуы |
Презентация https://present5.com/dnk-sekvenirleu-disi%D3%99-dnk-sekvenirleu-%D3%99disi/ |
||||||||||||
|
|
-Тапсырма. Топтық жұмыс
Тапсырма: Бағыттар:
Дескриптор:
2-Тапсырма. Жұптық аналитикалық тапсырма (10 мин)
Тапсырма:
Дескриптор:
3-Тапсырма. Жеке жұмыс – ЖИ қолдану
Тапсырма: Дескриптор:
4-Тапсырма. Сыни ойлау (Think–Why–Future) (5 мин)Сұрақ:
қысқа аргумент (3–4 сөйлем) Тест (бірдұрысжауап)
|
ЖИ құралымен – ChatGPT, Canva, Gamma)
|
||||||||||||
|
Рефлексия
1мин |
Рефлексия «3–2–1» әдісі
Үй тапсырмасы
«Геномды секвенерлеудің этикалық мәселелері» тақырыбында мини-эссе (200 сөз) немесе 1 слайдтық презентация (инфографика)
|
|
||||||||||||
17 сабақ Қмж
Микробиологиялық зерттеудің кезеңдері
|
Ұзақ мерзімді жоспар бөлімі:
|
Мектеп: |
|||||||||||||||||
|
Күні: |
Мұғалім: |
|||||||||||||||||
|
Сынып: 11 |
Қатысушылар саны: |
Қатыспағаны: |
||||||||||||||||
|
Сабақ тақырыбы |
Микробиологиялық зерттеудің кезеңдері |
|||||||||||||||||
|
Осы сабақ арқылы жүзеге асырылатын оқу мақсаттары |
микробиологиялық зерттеу кезеңдерін сипаттау және түсіндіру |
|||||||||||||||||
|
Сабақтың мақсаттары |
Оқушылар: -микробиологиялық зерттеулерде қолданылатын қоректік ортаның түрлі түрлерін анықтайды -оларды дайындай алады |
|||||||||||||||||
|
Бағалау критерийі |
Оқушылар: қоректік ортаның әр түрлерін жасай біледі |
|||||||||||||||||
|
Адал азамат» біртұтас тәрбие бағдарламасы құндылықтарын енгізу |
Академиялық шыншылдық, нақтылық, өзін өзі реттей білу , ойды реттей білу, сенімділік, дәлелдерді қолдана білу ,өзіне деген сенімділік, өзін-өзі көрсету болу құндылықтары дамытылады. |
|||||||||||||||||
|
Сабақ барысы |
||||||||||||||||||
|
Сабақтың жоспарланған кезеңдері |
Жоспарланған іс-әрекеттер |
Ресурстар |
||||||||||||||||
|
Сабақтың басы 0-5 мин |
Ұйымдастырукезеңі (2 мин) Қызығушылықтыояту (5 мин) – ЖИ + бейне
Жаңабілімдімеңгеру (10 мин)Мұғалімніңқысқашатүсіндірмесі + презентацияМикробиологиялық зерттеу кезеңдері:
Қоректік орталардың түрлері:
Микробиологиялық зерттеу қалай жүргізіледі?» (2–3 мин) Талқылау сұрақтары (Think–Pair–Share):
|
кесте |
||||||||||||||||
|
Сабақтың ортасы 6-11 мин 12-30 мин 31-35 мин |
Топтық жұмыс (10 мин) – ЖИ қолданысымен 1-тапсырма (4 топ) кезекті ресурстар таратылады оқушыларға қоректік орта түрлері және олардың тағайындалуы туралы біледі деп сұрайды Содан кейін кейбір негізгі ақпаратты енгізеді: * қоректік орта: микроорганизмдердің өсуі үшін дайындалған қоректік заттар * стерильді: тірі микробтар жоқ * инокулят: микробтарды ортаға енгізу. * Мәдениет: Мәдени ортада өсетін микробтар * синтетикалық тасушылар * синтетикалық тасушы анықталған * күрделі орта Агар: * Кешенді полисахарид * Петри тостағандарында, көлбеу және тереңдете қоректік орта үшін қатайтқыш ретінде қолданылады • * Әдетте микробтармен метаболизденбейді * 100 ° C кезінде ыдырайды • 40 ° C Қатайтады
Тапсырма:
Дескриптор:
Барлығы: 4 балл
Жұптық жұмыс (8 мин) 2-тапсырма: «Салыстыр»
Тапсырма:
Дескриптор:
Жеке жұмыс (5 мин) 3-тапсырма: «Ойлан, жаз»
Сұрақ: Дескриптор:
ЖИ қолдану – күрделі тапсырма
Тапсырма: Бағалау:
ТЕСТ тапсырмасы
|
https://microbeonline.com/types-of-bacteriological-culture-medium/
https://www.slideshare.net/HiwrHastear/types-of-culture-media
|
||||||||||||||||
|
Сабақ соңы 36-40 мин |
Рефлексия Менің ойымша… Өйткені … Мен оны мысалда дәлелдеуге болады... Осыған орай, Мен бұл ...
ЖИ көмегімен «Қазіргі медицинадағы микробиологиялық зерттеулер» тақырыбында 5 слайдтық мини-презентация жасау |
|
||||||||||||||||
18 сабақ ҚМЖ
|
Ұзақ мерзімді жоспар бөлімі:: 11.3D Биотехнология |
Мектеп: |
||||
|
Мерзімі: |
Мұғалім: |
||||
|
Сынып: 11 |
Қатысқандар саны:
|
Қатыспағандар саны: |
|||
|
Сабақ тақырыбы: |
Зертханалық жұмыс: "Әртүрлі қоректік ортада қышқыл сүт өнімдерінің микрофлорасын зерттеу". |
||||
|
Осысабақтақолжеткізілетіноқумақсаттары (оқубағдарламасынасілтеме) |
11.4.3.1 микробиологиялық зерттеудің кезеңдерін сипаттау және түсіндіру |
||||
|
Сабақ мақсаттары |
|
||||
|
Бағалау критерийлері |
Оқушылар оқу мақсатына жетеді,егер олар:
|
||||
|
Адал азамат» біртұтас тәрбие бағдарламасы құндылықтарын енгізу |
Академиялық шыншылдық, нақтылық, өзін өзі реттей білу , ойды реттей білу, сенімділік, дәлелдерді қолдана білу ,өзіне деген сенімділік, өзін-өзі көрсету болу құндылықтары дамытылады. |
||||
|
Сабақ барысы |
|||||
|
Сабақтың жоспарланған кезеңдері |
Сабақтағы жоспарланған іс-әрекет
|
Ресурстар |
|||
|
Сабақтың басталуы 2 мин 4 мин |
Ұйымдастыру Интерактивтісұрақ (Mentimeter / Kahoot): «Қышқылсүтөнімдерінегеұзақсақталады?» II. Қызығушылықтыояту – Видео (5 мин)
Қысқағылымивидео:
ЖИқолдану:
Қоректік орталар туралы қысқаша теория
Сұйық қоректік орта
Қатты қоректік орта
Микробиологиялық зерттеудің негізгі кезеңдері Зерттеу объектісін таңдау (айран, йогурт, қымыз) Қоректік ортаны дайындау (сұйық/қатты) Стерильдеу Үлгіні егу Инкубациялау Бақылау, микроскопия Нәтижені тіркеу және талдау |
PPT ЗЖ парақтары
«Lactic acid bacteria – how they
work?» |
|||
|
Сабақтың ортасы 10 мин 3 мин |
Жаңа білімді меңгеру (10 мин) – Топтық жұмыс 1-топ: Сұйық қоректік орта 2-топ: Қатты қоректік орта 3-топ: Қышқыл сүт өнімдерінің микрофлорасы Тапсырма:
Дескриптор:
Зертханалық жұмыс (15 мин) – Жұптық жұмыс
Зертханалық тапсырма
Жұмыс парағы
Дескриптор:
Талдау және ойлау дағдысы (Жеке жұмыс – 8 мин) ЖИ көмегімен тапсырма «Егер қышқыл сүт өнімінде бөгде бактерия көбейсе, не болады?» Дескриптор:
тест тапсырмасы
|
Canva, PowerPoint, ЖИ сурет генераторы |
|||
|
Сабақтың соңы 2 мин |
Рефлексия 1. Бүгін сабақта неге үйрендім? 2. Мен ең жақсы не істедім? 3. Едім жақсартты өз жұмысында келесі жолы? Үй тапсырмасы: ЗЖ оқыңыз + жұмыс парақтарының сұрақтарына жауап береңіз |
Стикерлер |
|||
19 –сабақ ҚМЖ
|
Бөлім: |
11.3 Биотехнология |
|
Педагогтің аты-жөні: |
|
|
Күні: |
|
|
Сыныбы:11а |
Қатысушылар саны: Қатыспағандар саны: |
|
Сабақтың тақырыбы: |
Грамм оң және грамм теріс бактериялар және олардың құрылысерекшеліктері. |
|
Оқу бағдарламасына сәйкес оқу мақсаты |
11.4.3.2 -грамм оң және грамм теріс бактерияларды зерттеу |
|
Сабақтың мақсаты: |
грамм оң және грамм теріс бактерияларды зерттей алады |
|
Адал азамат» біртұтас тәрбие бағдарламасы құндылықтарын енгізу |
Академиялық шыншылдық, нақтылық, өзін өзі реттей білу , ойды реттей білу, сенімділік, дәлелдерді қолдана білу ,өзіне деген сенімділік, өзін-өзі көрсету болу құндылықтары дамытылады. |
Сабақтың барысы:
|
Сабақ кезеңі/Уақыты |
Сабақтағыіс-әрекет Бағалау |
Ресурстар |
||||||
|
Сабақтың басы Қызығушылықты ояту |
(Ұ). Ұйымдастыру кезеңі: 1.Оқушылармен амандасу, түгендеу. Сынып реттілігін қадағалау. |
|||||||
|
Жаңа сабаққа кіріспе |
(Ұ) «Миға шабуыл» Бейнематериал (3–4 мин)
Тақырып: (YouTube: 3D анимация, микроскопиялық салыстыру)
«Қай бактерия қабырғасы қалың, қайсысы жұқа? Неліктен |
Gram-positive vs Gram-negative Bacteria (cell wall structure animation) (YouTube: 3D анимация, микроскопиялық салыстыру |
||||||
|
Сабақтың ортасы Мағынаны ашу. |
Мағынаны ашу Топтық жұмыс (Structure Mapping)
Тапсырма:
Дескриптор:
|
презентация |
||||||
|
|
Жұптықжұмыс – Салыстыру (Higher Order Thinking) Венн диаграммасы
Дескриптор:
|
ДК экраны 11-сынып оқулығы. Жұмыс дәптерлері. |
||||||
|
|
||||||||
|
|
Тапсырмалар айдарындағы -тапсырманы орындатады, бақылайды, мысал, үлгі көрсетеді. Жеке жұмыс– ЖИ көмегімен талдау
AI Prompt
(оқушыға): «Грамтеріс бактериялардың антибиотикке төзімді болу себебін түсіндір» Дескриптор:
Бекіту – Презентация + ойлау тапсырмаларыПрезентация слайдтары:
Ойлау дағдысы (Себеп–салдар):Сұрақ: Егер грамтеріс бактерияда сыртқы мембра Тест тапсырмалары
|
ДК экраны 11-сынып оқулығы. Жұмыс дәптерлері. |
||||||
|
Сабақтың соңы Ой толғаныс. Рефлексия
|
«3–2–1» әдісі:
|
|
||||||
20-сабақ ҚМЖ
|
САБАҚ: |
|
||||||||||||
|
Күні: |
Мұғалімнің аты-жөні: |
||||||||||||
|
Сыныбы:11 |
Қатысушылар саны: |
Қатыспағандар: |
|||||||||||
|
Сабақ тақырыбы |
Рекомбинатты ДНҚ алу тәсілдері |
||||||||||||
|
Осысабақтақолжеткізілетіноқумақсаттары (оқубағдарламасынасілтеме) |
Оқушыларорындайалады: 11.4.3.2- рекомбинанттыДНҚалутәсілдерінтүсіндіру |
||||||||||||
|
Сабақ мақсаты |
Оқушылар: Рекомбинатты ДНҚ ұғымымен танысады Рекомбинантты ДНҚ –ын алу тәсілін біледі Сызбалармен жұмыс жасай алады Рекомбинатты ДНҚ –ны алу тәсілдерін түсіндіре алады |
||||||||||||
|
Адал азамат» біртұтас тәрбие бағдарламасы құндылықтарын енгізу |
Академиялық шыншылдық, нақтылық, өзін өзі реттей білу , ойды реттей білу, сенімділік, дәлелдерді қолдана білу ,өзіне деген сенімділік, өзін-өзі көрсету болу құндылықтары дамытылады. |
||||||||||||
|
Сабақ барысы |
|||||||||||||
|
Сабақтың жоспарланған кезеңдері |
Сабақтағы жоспарланған іс-әрекет
|
Ресурстар |
|||||||||||
|
Сабақтың басы 0-5 минут 5-10 мин |
Ой-қозғау: Қызығушылықты ояту (5 мин) Проблемалық сұрақ (сыни ойлау): «Адам инсулині бактерия арқылы қалай өндіріледі деп ойлайсың?» ЖИ қолдану:
ДНҚ ға тән қандай қасиеттер бар? ДНҚ ның екі еселенуі қалай жүзеге асатын еді? Мұғалімнің түсіндірмесі: Слайд № 3 Тақтаға Рекамбинантты ДНҚ алу жолы туралы сызба көрсетіледі.
Гендердің көптеген бірдей көшірмелерін алу клондау деп аталады. Көшірмеге негіз болатын генді векторлы ген деп атайды және оларды плазмидалардан немесе бактериофагтардан алады. Плазмидалар – прокариоттарға тән сақина тәрізді ДНҚ бөлігі және ол ДНҚ-дан тыс репликацияланады. Бактериофагтар (немесе фагтар) – бұлар бактерия жасушасына өз ДНҚ-ын енгізіп репликациялайтын вирустар. Клондауға арналған ДНҚ фрагменттерін фаг немесе плазмида денесіне енгізеді. Алынған «қоспаны» рекомбинантты ДНҚ деп айтады. .
|
Мұғалімнің түсіндірмесі толығымен Қосымша №1 Дарынды оқушылар үшін қосымша ақпарат Қосымша №2 Анимация https://www.dnalc.org/content/c15/15929/insulin_yeast.swf http://www.glynwalton.co.uk/SWFs_files/biotech_medicines_1-4.swf http://highered.mheducation.com/sites/dl/free/0072421975/196644/cloning_gene.swf видео: |
|||||||||||
|
Сабақтың ортасы 10-30 мин 30-35 мин 35-38 мин |
Мағынаны тану: Оқушыларды шағын 3 топқа бөлу. «Мозайка» әдісі арқылы топтарға бөлінеді Топтарға тапсырма: Әр топ рекомбинантты ДНҚ –ның бір тәсіліне зерттеу жүргізеді Бағалау критерийі:
1 топ – жабысқақ ұштар әдісі 2 топ – гомополимерлі ұштар әдісі 3 топ – доғал ұштарды жалғау(тігу) әдісі Мақсатты тұжырымдау: Түрлі терминдер мен суреттер берілген карточкалар беріледі. Оқушылар толық рекомбинантты ДНҚ ның жасалу тәсілінің стандартты сызбасын құрастырады. Әр кезеңге қажетті терминдер мен суреттер бір топ болады. Топтар жасалу реттілігі бойынша орналасады. Әр топ келесі топқа осы тақырып бойынша негізгі деп тапқан екі термин сөздің анықтамасын және оның қызметін немесе қасиетін айтуларын сұрайды. Бекіту тапсырмасы: «Мұғалімнен 3 минуттық 3 сұрақ» Оқушыларға жеке жұмыс беріледі Мұғалім ауызша жауабын айтады, «Карусель» әдісі арқылы оқушылар өздерін тексереді. Жұптық жұмыс
Тапсырма:
Дескриптор:
Жеке жұмыс (сыни ойлау) Тапсырма: «Рекомбинантты ДНҚ қолданудың медицинадағы маңызын түсіндір» Дескриптор:
V. ЖИ қолдану
AI
тапсырмасы: «Рекомбинантты ДНҚ алу процесін 5 қадаммен қысқаша сипатта» (талқылау, салыстыру)
|
Интернет ресурстар, тапсырмалармен карточкалар
Топтық жұмыс үшін оқу материалы Қосымша №1,2
Қажетті сызбалар мен суреттер
Қосымша №3 |
|||||||||||
|
Сабақтың соңы
38-40 мин |
Рефлексиямұғалімнің сұрақ қоюы негізінде жүзеге асады:
|
|
|||||||||||
21-сабақ ҚМЖ
|
Ұзақ мерзімді жоспар бөлімі: Биотехнология |
Биотехнология |
|||||||
|
Күні: |
Мұғалімнің аты-жөні: |
|||||||
|
Сынып: |
Қатысқандар саны: Қатыспағандар саны: |
|
||||||
|
Сабақ тақырыбы |
Плазмиданың қасиеті және оларды гентикалық клондауда қолданылуы |
|||||||
|
Осы сабақта қол жеткізілетін оқу мақсаттары (оқу бағдарламасына сілтеме) |
|
|||||||
|
Сабақ мақсаттары |
Рекомбинатты ДНҚ алу тәсілдерін толыққанды түсінеді |
|||||||
|
Адал азамат» біртұтас тәрбие бағдарламасы құндылықтарын енгізу |
Академиялық шыншылдық, нақтылық, өзін өзі реттей білу , ойды реттей білу, сенімділік, дәлелдерді қолдана білу ,өзіне деген сенімділік, өзін-өзі көрсету болу құндылықтары дамытылады. |
|||||||
|
Сабақ барысы |
||||||||
|
Сабақтың жоспарланған кезеңдері |
Сабақтағы жоспарланған іс-әрекет |
Ресурстар |
||||||
|
Сабақтың басы 0-5 |
Ұйымдастыру кезеңі (2 мин)
Қызығушылықты ояту – Видео + ЖИ (5 мин)
Видео: RecombinantDNAtechnology (3–4 мин, анимация) «Рекомбинантты ДНҚ қалай алынады? Қарапайым тілмен түсіндір |
сурет Презентация видео |
||||||
|
Сабақтың ортасы |
Мұғалім түсіндірмесі Гендердің көптеген бірдей көшірмелерін алу клондау деп аталады. Көшірмеге негіз болатын генді векторлы ген деп атайды және оларды плазмидалардан немесе бактериофагтардан алады. Плазмидалар – ДНҚ-ның сақина тәрізді фрагменттері, олар кейбір бактерияларда кездеседі және ДНҚ-дан тыс репликацияланады. Бактериофагтар (немесе фагтар) – бұлар бактерия жасушасына өз ДНҚ-ын енгізіп репликациялайтын вирустар. Клондауға арналған ДНҚ фрагменттерін фаг немесе плазмида денесіне енгізеді. Алынған «қоспаны» рекомбинантты ДНҚ деп айтады. . Топтық жұмыс (10 мин) 1-тапсырма. «Сызбаны сөйлет» (Топтық) Берілген сызба бойынша рекомбинантты ДНҚ алу кезеңдерін түсіндіріңіз:
Дескриптор:
Рекомбинанттық ДНҚ-ның осылай қолданылуын түсіндіретін модель дайындауларын сұрау. (8 логикалық қадам + 3 сызбалық көрсету) I. 8 ЛОГИКАЛЫҚ ҚАДАМ (модель мазмұны) 1-қадам. Қажетті генді таңдау Мысалы: адам инсулині гені 2-қадам. Генді бөліп алу Рестриктаза ферменті адам ДНҚ-сынан генді кесіп алады 3-қадам. Плазмиданы алу Бактериядан плазмида (сақиналы ДНҚ) бөлінеді 4-қадам. Плазмиданы кесу Сол рестриктаза плазмиданы да кеседі 5-қадам. Генді плазмидаға енгізу Лигаза
ферменті ген мен плазмиданы
біріктіреді 6-қадам. Бактерияға енгізу Рекомбинанттық плазмида
бактерия жасушасына енгізіледі 7-қадам. Клондау (көбею) Бактериялар көбейеді → ген де көбейеді 8-қадам. Дайын өнім алу Бактерия инсулин / фермент / вакцина өндіреді II. 3 СЫЗБАЛЫҚ КӨРСЕТУ 1-СЫЗБА. Генді алу Адам ДНҚ ──✂ (рестриктаза)──► Қажетті ген 2-СЫЗБА. Рекомбинанттық плазмида Плазмида ──✂──► + Қажетті ген ↓ (лигаза) Рекомбинанттық плазмида 3-СЫЗБА. Қолданылуы Рекомбинанттық плазмида ↓ Бактерия ↓ Дайын өнім (инсулин) V. Жұптық жұмыс 2-тапсырма. «Салыстыр» Плазмида мен хромосомалық ДНҚ-ны салыстырыңыз
Дескриптор:
Жеке жұмыс 3-тапсырма. Жоғары деңгейлі ойлау Сұрақ: Егер плазмида болмаса, генетикалық клондау қалай өзгерер еді? Дескриптор: 1.себеп-салдар байланысын көрсетеді – 1 б 2.ғылыми негіз келтіреді – 1 б Бекіту – Тест тапсырмалары
|
Microsoft PowerPoint презентациясы
Анимация https://www.dnalc.org/content/c15/15929/insulin_yeast.swf
http://www.glynwalton.co.uk/SWFs_files/biotech_medicines_1-4.swf
http://highered.mheducation.com/sites/dl/free/0072421975/196644/cloning_gene.swf
|
||||||
|
Сабақтың соңы 35-40 |
Рефлексия (3 мин) «3–2–1» әдісі:
|
Стикер |
||||||
22-сабақ ҚМЖ
|
Ұзақ мерзімді жоспар бөлімі: |
Биомедицина және биоинформатика |
|||||||||||||||||||||||||
|
Күні: |
Мұғалім: |
|||||||||||||||||||||||||
|
Сынып: 11 (Жаратылыстану-математика бағытында) |
Қатысқандар: |
Қатыспағандар: |
||||||||||||||||||||||||
|
Сабақ тақырыбы: |
Электромагниттік және дыбыс толқындарының адам ағзасына әсері |
|||||||||||||||||||||||||
|
Осы сабақта қол жеткізілетін оқу мақсаттары (оқу бағдарламасына сілтеме) |
12.4.5.3 - электромагниттік және дыбыс толқындарының адам ағзасына әсерін түсіндіру |
|||||||||||||||||||||||||
|
Сабақ мақсаттары |
|
|||||||||||||||||||||||||
|
|
|
|||||||||||||||||||||||||
|
Сабақ барысы |
||||||||||||||||||||||||||
|
Сабақтың жоспарланған кезеңдері |
Сабақтағы жоспарланған іс-әрекет |
Ақпарат көзі |
||||||||||||||||||||||||
|
Сабақтың басы 0-2 3-5 |
. Ұйымдастыру кезеңі
ІІ. Қызығушылықты ояту Кіріспе видео (2–3 мин):
|
Power Point presentation Slide пайдалысілтеме сергіту сәтіне арналған https://www.youtube.com/watch?v=kOkv8ynpppk |
||||||||||||||||||||||||
|
Сабақтың ортасы 6-15 |
Мағынаны ашу
1Дыбыс
толқындарының адам ағзасына әсері Сурет/слайд: Құлақ құрылысы Өту жолы:
Әсері:
2️⃣ Электромагниттік толқындардың әсері
Кесте/слайд:
3 Адам жүйелеріне әсері Жүйке жүйесі:
Гуморалды жүйе:
Иммунды жүйе:
Қанайналым жүйесі:
IV. Тапсырмалар (15 мин) 1-тапсырма. Жұптық жұмыс
Тапсырма: Дескриптор:
2-тапсырма. Топтық жұмыс (Зерттеу)
Тақырыптар: ЖИ қолдану: ChatGPT – ғылыми түсіндірме, инфографика жасау Дескриптор:
3-тапсырма. Жеке жұмыс (Сыни ойлау)
Сұрақ: Дескриптор:
V. Бекіту. Тест тапсырмалары
|
Қосымша 2
Қосымша 3
|
||||||||||||||||||||||||
|
Сабақтың соңы 39-40
|
Бізге айтыныз. Активити Оқушылар сабақтың негізгі идеясын түсіндіретін дыбыс (jingle) жазады
Үй жұмысы: Оқушыларға «ЭМ толқындарының пайда болуы және оның зияны» тақырыбында қысқаша эссе жазу тапсырмасын беріңіз. |
|
||||||||||||||||||||||||
24-сабақ ҚМЖ
|
Тарау; 1.3Биомедицина және биоинформатика |
Мектеп: |
||||
|
Күні: |
Мұғалімнің аты-жөні: |
||||
|
Сыныбы: 11 |
Қатысушылар саны: |
Қатыспағандар: |
|||
|
Сабақ тақырыбы |
«Биоинформатика» ұғымы. Биоинформатикақұралдарын зерттеулерге қолдану |
||||
|
Осысабақтақолжеткізілетіноқумақсаттары (оқубағдарламасынасілтеме) |
11.4.4.3 – биоинформатика ролін түсіндіру |
||||
|
Сабақ мақсаты |
|
||||
|
Бағалау критерийлері |
|
||||
|
Алдыңғы білімдер: |
Биотехнология маңызы, бөлімдері |
||||
|
Сабақ барысы |
|||||
|
Сабақтың жоспарланған кезеңдері |
Сабақтағы жоспарланған іс-әрекет
|
Ресурстар
|
|||
|
Сабақтың басы 3минут 20минут Сабақтың ортасы 17 минут |
. Ұйымдастыру кезеңі (2 мин)Психологиялық ахуал «Геном – бұл ақпарат. Ақпаратты кім талдайды?» – сұрағы арқылы тақырыпқа жетелеу II. Қызығушылықты ояту (5 мин) – ЖҰПТЫҚ ЖҰМЫС Видео 1
Тақырыбы:What
is Bioinformatics? Тапсырма:
Дескриптор:
III. Жаңа білімді меңгеру (15 мин)Мұғалім түсіндірмесіБиоинформатика –
биологиялық деректерді (ДНҚ, РНҚ, ақуыз, геном)
СУРЕТ
1
|
Биоинформатика как дисциплина https://www.youtube.com/watch?v=IE8PRZrU7XI&list=PLh6dVTO7f4FazIQHrdOT1W0N1yMPRlzwEhttps://www.youtube.com/watch?v=IE8PRZrU7XI&list=PLh6dVTO7f4FazIQHrdOT1W0N1yMPRlzwE Презентация Қосымша 1, 2 ) / видеоролик Структурная биоинформатика https://www.youtube.com/watch?v=PlYov5sXNKw&list=PLh6dVTO7f4FazIQHrdOT1W0N1yMPRlzwE&index=7 Ноутбук, қағаз А3, маркерлер, түсті қарындаштар Қосымша 3 Қағаз А2, маркерлер, түсті қарындаштар, клей |
|||
|
Сабақ соңы 3 минут |
V. Рефлексия«3–2–1» әдісі
Үй тапсырмасы: «Биоинформатиканың қазіргі заманғы мүмкіншіліктері»атты тақырыпқа постер дайындау |
Стикерлер |
|||
25 сабақ-ҚМЖ
|
Ұзақ мерзімді жоспар бөлімі: Көбею |
Көбею |
|||||||||||||
|
Күні |
Мұғалімніңаты-жөні: |
|||||||||||||
|
Сынып:11 |
Қатысқандарсаны: |
Қатыспағандар саны: |
||||||||||||
|
Сабақтақырыбы |
Экстракорпоралды ұрықтандыру әдісі және оның маңызы |
|||||||||||||
|
Осысабақтақолжеткізілетіноқумақсаттары (оқубағдарламасынасілтеме) |
11.4.4.4-Экстракорпоралдық ұрықтандыру әдісінің мәнін түсіндіру |
|||||||||||||
|
Сабақ мақсаттары |
ЭКҰқолданылуыменмаңызынтүсіндіру |
|||||||||||||
|
Бағалау критерийлері |
ЭКҰ әдісінің мәнісін сипаттап, түсіндіреді. Экстракорпоралды ұрықтандырудың маңызын сипаттайды
|
|||||||||||||
|
Адал азамат» біртұтас тәрбие бағдарламасы құндылықтарын енгізу |
Академиялық шыншылдық, нақтылық, өзін өзі реттей білу , ойды реттей білу, сенімділік, дәлелдерді қолдана білу ,өзіне деген сенімділік, өзін-өзі көрсету болу құндылықтары дамытылады. |
|||||||||||||
|
Сабақ барысы |
||||||||||||||
|
Сабақтың жоспарланған кезеңдері |
Сабақтағы жоспарланған іс-әрекет |
Ресурстар |
||||||||||||
|
Сабақтың басы
|
Ұйымдастыру кезеңі (2 мин)
II. Қызығушылықты ояту (5 мин) Видео қарау Тақырып:» Сұрақтар (жеке жұмыс):
➡ЖИ
қолдану: |
Презентация видео "Процедура IVF" |
||||||||||||
|
Сабақтың ортасы 11-36 минут
|
Экстракорпоралды ұрықтандыру (ЭКҰ) дегеніміз: Аналық жасуша мен сперматозоидтың ағзадан тыс (in vitro) жағдайда ұрықтандырылып, кейін эмбрионның жатыр қуысына енгізілуі. ЭКҰ негізгі кезеңдері презентация
Топтық жұмыс 1-топ: «ЭКҰ қолданылу себептері»
2-топ: «ЭКҰ маңызы»
3-топ: «ЭКҰ-ның артықшылықтары мен шектеулері» 4-топ: «ЭКҰ және биоэтика»
Дескрипторлар:
Жұптық жұмыс «Салыстыр» әдісі Табиғи ұрықтану vs ЭКҰ
➡ЖауаптыЖИарқылытексеру (қателерінанықтау)
VI. Жекежұмыс «Ойлан – жауапбер»
Сұрақ: Дескриптор:
Тест тапсырмалары
|
видео "Процедура IVF" https://www.youtube.com/watch?v=KSrTfxhLb8o https://www.youtube.com/watch?v=uXsCngh89fI
|
||||||||||||
|
Сабақтың соңы 37-40 |
Рефлексия мұғалімнің сұрақтарына негізделеді: 1. Сіз қай кезеңде қиындық көрдіңіз? 2. Келесі сабақта мұғалімнен сізге қандай көмек қажет болуы мүмкін? Немесе Синквейн түрінде өткізуге болады |
|
||||||||||||
Сабақ 26 ҚМЖ
|
Бөлім 11.4 А Биомедицина және биоинформатика |
Мектеп: |
|||||
|
Күні: |
Мұғалімнің аты-жөні: |
|||||
|
Сыныбы:11 |
Қатысушылар саны: |
Қатыспағандар: |
||||
|
Сабақ тақырыбы |
Экстракорпоральды ұрықтандырудың этикалық аспектілері. |
|||||
|
Осысабақтақолжеткізілетіноқумақсаттары (оқубағдарламасынасілтеме) |
Оқушыларорындайалады: 11.4.4.3 - экстракорпоральдыұрықтандыру (ЭКҰ) әдісініңмаңызынтүсіндіру |
|||||
|
Сабақ мақсаты |
Оқушылар сабақта: ЭКҰ маңыздылығын және этикалық аспектілерін анықтауды үйренеді. |
|||||
|
Бағалау критерийлері |
Бағалау критерийлері:
|
|||||
|
Адал азамат» біртұтас тәрбие бағдарламасы құндылықтарын енгізу |
Академиялық шыншылдық, нақтылық, өзін өзі реттей білу , ойды реттей білу, сенімділік, дәлелдерді қолдана білу ,өзіне деген сенімділік, өзін-өзі көрсету болу құндылықтары дамытылады. |
|||||
|
Сабақ барысы |
||||||
|
Сабақтың жоспарланған кезеңдері |
Сабақтағы жоспарланған іс-әрекет |
Ресурстар |
||||
|
Сабақтың басы 5 минут |
Ұйымдастыру кезеңі (2 мин)
Қызығушылықты ояту (Жеке жұмыс, 5 мин) Видео көру Тапсырма: бейнені көріп, сұрақтарға жауап беру
Дескриптор:
|
|
||||
|
Сабақтың ортасы |
Жаңа білімді меңгеруМұғалім түсіндірмесі:
эмбрион тағдыры донорлық генетикалық іріктеу дін мен қоғам көзқарасы IV. Топтық жұмыс (10 мин) 1-топ: ЭКҰ-ның маңыздылығы 2-топ: ЭКҰ-ны қолдайтын этикалық дәлелдер 3-топ: ЭКҰ-ға қарсы этикалық көзқарастар Тапсырма: постер дайындау (Canva / қағаз)
Дескриптор:
V. Жұптық жұмыс (Сыни ойлау, 7 мин)
«Иә / Қарсы» дебат кестесі
Дескриптор:
VI. Жеке жұмыс (ЖИ қолдану, 5 мин) AI тапсырма
Тапсырма: Дескриптор:
Тест тапсырмалары
|
ЭҰҚныңэтикалықа спектісі |
||||
|
Сабақтың соңы 3 минут |
К «Нысана» әдісі бойынша. |
|
||||
27 сабақ ҚМЖ
|
Бөлім:11.3D Биотехнология |
Мектеп:Әл-Фарабиатындағыбейіндікмектеп |
||||
|
Күні: |
Мұғалім:МанаеваБ.Б. |
||||
|
Сынып: |
Қатысқандарсаны: |
Қатыспағандарсаны: |
|||
|
Сабақтақырыбы |
Моноклоналдыантиденелердіқолдануарқылыаурулардыдиагностикалау және емдеу |
||||
|
Осы сабақта қол жеткізілетін оқу мақсаттары |
11.4.4.4аурулардыдиагностикалауменемдеудемоноклоналды антиденелердің қолданылуын түсіндіру |
||||
|
Сабақ мақсаттары |
|
||||
|
|
|
||||
|
Сабақтыңбарысы |
|||||
|
Сабақтыңжоспарлан ған кезеңдері |
Сабақтағыжоспарланғаніс-әрекет |
Ресурстар |
|||
|
Сабақтыңбасы 0-5мин.
Сабақтың ортасы
Сабақтың соңы
|
Қызығушылықты ояту– Жұптық жұмыс Видео көруСұрақтар
?Дескриптор:
Моноклоналды антиденелер қалай түзіледі? Гибридома әдісі:
Нәтиже: бір ғана антигенге дәл әсер ететін антидене
Диагностикадағы рөлі
3️ Емдеудегі рөлі
Топтық жұмыс 1-топ: «Құрылу механизмі»
Сурет бойынша кезеңдерді реттеп, түсіндіру 2-топ: «Диагностика» Нақты ауру + қандай тест + антидене рөлі 3-топ: «Емдеу» Белгілі препарат (мыс: Трастузумаб) – әсері
4-топ: «ЖИ және болашақ»
ЖИ моноклоналды антиденелерді жасауда қалай көмектеседі? Дескриптор:
ғылыми термин қолданады Жеке жұмыс Сыни ойлау Эссе (5–6 сөйлем): «Моноклоналды антиденелер – болашақ медицинасының негізі ме?» Дескриптор:
ТЕСТ
«3–2–1» әдісі:
Үйге тапсырма «Моноклоналды
антиденелер және онкология» тақырыбына
инфографика |
Power Point таныстырылымы
1 қосымша (сәйкестендіру тапсырмасы)
https://www.youtube.com/watch?v=uuT08OT3wTc– “How to produce monoclonal antibody” анимация
ноутбук 4 қосымша (A-levelпрактикалық сұрақтары)
Стикер Қосымша сілтеме https://www.youtube.com/
|
|||
|
|
|
|
|||
28 сабақ ҚМЖ
|
САБАҚ: |
|
|||
|
Күні: |
Мұғалімнің аты-жөні: |
|||
|
Сыныбы:11 |
Қатысушылар саны: |
Қатыспағандар: |
||
|
Сабақ тақырыбы |
Харди-Вайнберг генетикалық тепе-теңдік заңы.Сирек кездесетін және жойылып бара жатқан өсімдіктер мен жануарлардың түрлерін қорғау |
|||
|
Осысабақтақолжеткізілетіноқумақсаттары (оқубағдарламасынасілтеме) |
Оқушыларорындайалады: Экожүйенің алуан түрлілігі мен тұрақтылығы арасындағы өзара байланысты орнату |
|||
|
Сабақ мақсаты |
экожүйенің алуан түрлілігі мен тұрақтылығы арасындағы өзара байланысты орнату |
|||
|
Бағалау критерийлері |
Оқушылар орындай алады:
|
|||
|
Адал азамат» біртұтас тәрбие бағдарламасы құндылықтарын енгізу |
Академиялық шыншылдық, нақтылық, өзін өзі реттей білу , ойды реттей білу, сенімділік, дәлелдерді қолдана білу ,өзіне деген сенімділік, өзін-өзі көрсету болу құндылықтары дамытылады. |
|||
|
Сабақ барысы |
||||
|
Сабақтың жоспарланған кезеңдері |
Сабақтағы жоспарланған іс-әрекет |
Ресурстар |
||
|
Сабақтың басы |
Оқушылармен сәлемдесу Қызығушылықты ояту
Видео (2–3
мин): Ой қозғау сұрақтары (жұптық жұмыс):
Жаңа білімді меңгеру (10 мин) Презентация мазмұны:
p2+2pq+q2=1p^2 + 2pq + q^2 = 1p2+2pq+q2=1
Топтық жұмыс
Тапсырма: 1-топ – Қар барысы
2-топ – Қызғалдақтың сирек түрі
3-топ – Ақбөкен
Сұрақтар:
Дескрипторлар:
Жұптық жұмыс
Есеп
шығару:
Дескрипторлар:
Жекежұмыс Сыни ойлау тапсырмасы: «Неліктен сирек түрлерді қорғауда тек санын көбейту жеткіліксіз?» Дескрипторлар:
Есептер шығару
q2=98/200 =0,49q=0,49=0,7p=1−q=1−0,7=0,3 2pq=2⋅0,3⋅0,7=0,42Жауабы:Гетерозиготалар жиілігі: 42%2. Тышқандарда сұр аң терісіне қарағанда қоңыр түсі басымдылық көрсетеді. Егер сізде 200 тышқанның 168 қоңыр тышқандар болса Гомозиготалы доминанттардың,гетерозиготалары және гомозиготалы рецессивтіліктің болжамды жиілігі қандай? Гомозиготалы доминантты (p²): q2=200/32=0,16q=0,4p=0,6 Гетерозиготалы (2pq): p2=0,36⇒36%2pq=2⋅0,6⋅0,4=0,48⇒48% Гомозиготалы рецессивті (q²): 0,16⇒16%
10 ТЕСТ ТАПСЫРМАСЫ
|
Презентация, Суреттер |
||
|
39-40 минут |
Үйге тапсырма: Презентацияны оқу және Харди-Вайнберг заңына тапсырмалар жинақтау РЕФЛЕКСИЯ: 1. Жұмыстың қай кезеңінде сіз қиындықтарға тап болдыңыз? 2. Келесі сабақта мұғалімнен сізге қандай көмек қажет болуы мүмкін? |
|||
29 сабақ ҚМЖ
|
Ұзақ мерзімді жоспар бөлімі: |
11.4АБиосфера, экожүйе, популяция |
||||||||||||||||||||||||||||||||||||||||||||
|
Күні: |
Мұғалімнің аты-жөні: |
||||||||||||||||||||||||||||||||||||||||||||
|
Сынып: |
Қатысқандар саны: |
Қатыспағандар саны: |
|||||||||||||||||||||||||||||||||||||||||||
|
Сабақ тақырыбы |
Экологиялық жағдайлар мен экологиялық есептер шешу |
||||||||||||||||||||||||||||||||||||||||||||
|
Осы сабақта қол жеткізілетін оқу мақсаттары (оқу бағдарламасына сілтеме) |
11.3.1.2 - экожүйелердегі трофикалық деңгейлердің сызбасын құрастыру |
||||||||||||||||||||||||||||||||||||||||||||
|
Сабақ мақсаттары |
Оқушылар:
|
||||||||||||||||||||||||||||||||||||||||||||
|
Жетістік критерийлері |
|
||||||||||||||||||||||||||||||||||||||||||||
|
Адал азамат» біртұтас тәрбие бағдарламасы құндылықтарын енгізу |
Академиялық шыншылдық, нақтылық, өзін өзі реттей білу , ойды реттей білу, сенімділік, дәлелдерді қолдана білу ,өзіне деген сенімділік, өзін-өзі көрсету болу құндылықтары дамытылады. |
||||||||||||||||||||||||||||||||||||||||||||
|
Сабақ барысы |
|||||||||||||||||||||||||||||||||||||||||||||
|
Сабақтың жоспарланған кезеңдері |
Сабақтағы жоспарланған іс-әрекет |
Ресурстар |
|||||||||||||||||||||||||||||||||||||||||||
|
Сабақтың басы |
.Қызығушылықтыояту – ВИДЕОВидеоұсыныс:
“Energyflowinecosystems” Мұғалім сұрақтары:
Ойлау дағдысы: Талдау, себеп-салдар |
Презентация MS PowerPoint Слайд 1 Қосымша 1 (диктовкалық белсенділікті айқайлауға арналған бос орындары бар мәтін) Слайд 2-4 |
|||||||||||||||||||||||||||||||||||||||||||
|
Сабақтың ортасы |
Жұптық жұмыс – Энергия берілу сызбасы Әдіс: Think–Pair–Share Тапсырма: Берілген мәлімет: Продуцент – 15 000 кДж Жұппен:
Формула:Тиімділік=Алдыңғы деңгей/Келесі деңгей×100 Дескриптор:
Жеке жұмыс – Экологиялық есептер Есеп 1 Жыртқышта 80 кДж энергия бар. Жауабы: Есеп 2 Егер I консумент жойылса, экожүйеде қандай өзгеріс болады? Жауабы:
Дескриптор:
ЖИ қолдану (5 мин) Тапсырма: ChatGPT немесе басқа ЖИ арқылы: «Орман экожүйесінің трофикалық деңгейлерінің сандық моделін құрастыр» Нәтиже: Сандық дерек Энергия пирамидасы ➡ XXI ғасыр дағдысы: цифрлық сауаттылық ЗЕРТТЕУЖҰМЫСТАРЫ Жұптық тапсырма: Қоректік желі диаграммасын талдау Мақсаты: Оқушылар қоректік желінің құрылымын түсінеді, байланыстарды анықтайды. Орындау:
Дескриптор:
2 Жұптық тапсырма: Қоректік желі бойынша мәлімдемелер жасау Мақсаты: Оқушылар қоректік желі бойынша логикалық қорытындылар жасайды Орындау:
Дескриптор:
3️ Өзара бағалау Мақсаты: Көршінің жұмысын талдау, сыни ойлау дағдысын дамыту Орындау:
Дескриптор:
4. Жеке тапсырма: Жұмыс парағын толтыру Мақсаты: Экологиялық есептер мен өткен Кембридж емтихан тапсырмаларын шешу Орындау:
Дескриптор:
5️ Мұғаліммен кері байланыс Мақсаты: Тақырып бойынша негізгі идеялар мен қорытындыларды талдау Орындау:
Дескриптор:
ТЕСТ 1. Продуценттерге жатады:
A) Қасқыр 2. Энергияның негізгі көзі:
A) Су 3. 10% ережесі нені білдіреді?
A) Энергия толық өтеді 4. Қоректік тізбектің соңында:
A) Продуцент 5. 1 000 кДж → келесі деңгейде:
A) 1 000 6. II реттік консумент:
A) Шөп 7. Қайсысы энергия пирамидасына тән?
A) Кеңейеді 8. Экожүйе тұрақтылығы тәуелді:
A) Бір түрге 9. Энергия жоғалуы себебі:
A) Фотосинтез 10. Қоректік желі дегеніміз:
A) Бір тізбек
|
Презентация MS PowerPoint Слайд 5 Қосымша 2 (қоректік желілер суреттері бар үлестірме материал) Слайд 6 Қосымша 3 және 4 (студенттің жұмыс парағы, жауаптар)
Ұсынылған бейне фильм: 1)https://www.youtube.com/watch?v=VfhgthqiGgY(ағылшын тілін)
2)https://www.youtube.com/watch?v=9R5nMvkZrC8 (ағылшын тілін)
3)https://www.youtube.com/watch?v=wx9Ku_R-Zqo(ағылшын тілін)
|
|||||||||||||||||||||||||||||||||||||||||||
|
Сабақтың соңы 39-40 мин |
Үй жұмысы. Эссежазу 250сөз - Рефлексия. Ең қызығы не болды? Ең тиімдісі не болды? Мен әлі түсінбеймін ... |
|
|||||||||||||||||||||||||||||||||||||||||||
30 сабақ ҚМЖ
|
Ұзақ мерзімді жоспар бөлімі: Бөлім 11.4А Биосфера, экожүйе, популяция |
11.4А Биосфера, экожүйе, популяция |
||||||||||||||||||||||||||||
|
Күні: |
Мұғалімнің аты-жөні: |
||||||||||||||||||||||||||||
|
Сынып: |
Қатысқандар саны: Қатыспағандар саны: |
|
|||||||||||||||||||||||||||
|
Сабақтақырыбы:Жергілікті экожүйенің биоәртүрлілігін анықтауда кездейсоқ іріктеудің мәні. |
|||||||||||||||||||||||||||||
|
Осысабақтақолжеткізілетіноқумақсаттары (оқубағдарламасынасілтеме) |
өз аймақтың экожүйесін статистикалық талдау әдістерін (Стьюденттің t-критерийі, χ2-критерий) мысал келтіре отырып, есептерді қадам бойынша шығарады |
||||||||||||||||||||||||||||
|
Сабақ мақсаттары |
• Экологиялық зерттеулердегі статистиканы салыстырып, мысал ретінде есептер шығарады |
||||||||||||||||||||||||||||
|
Бағалау критерийлері |
Оқушы оқу мақсатына қол жеткізді, егер ол: • t - тестстатистикалық әдісіне мысал келтіріп, гипотезалар қойып, қадам бойынша есеп шығарады • хи квадраты статистикалық әдісіне мысал келтіріп, гипотезалар қойып, қадам бойынша есеп шығарады |
||||||||||||||||||||||||||||
|
Бастапқы білім |
Жергілікті экожүйенің организмдерінің саны мен таралуын анықтауда әртүрлі статистикалық әдістерді қолдану – Бірінші және екінші сабақтар |
||||||||||||||||||||||||||||
|
Сабақ барысы |
|||||||||||||||||||||||||||||
|
Сабақтың жоспарланған кезеңдері |
Сабақтағы жоспарланған іс-әрекет |
Ресурстар |
|||||||||||||||||||||||||||
|
Сабақтың басы 3 мин 5 мин |
Сабақ тақырыбы мен мақсаттарын хабарлау
Оқушыларды 3 топқа
бөлу: 2-топ – χ², 3-топ – Аналитиктер (ЖИ) II. ҚЫЗЫҒУШЫЛЫҚТЫ ОЯТУВидео көру (3 минут)Тақырып: Видео мазмұны: ЖИ арқылы жануарларды санау Кездейсоқ іріктеу не үшін қажет? |
Презентация Өткен сабақта берілген Венн диаграмасын қолдануға болады |
|||||||||||||||||||||||||||
|
Сабақтың ортасы 15 мин |
Жұптық талқылау Сұрақтар:
Жұп 1 ойы:
Жұп 2 ойы:
Жұп 3 ойы:
Жұп 4 ойы: 2-сұрақ: Кездейсоқ іріктеу нәтижеге қалай әсер етеді?
Жұп 1 ойы:
Жұп 2 ойы:
Жұп 3 ойы:
Жұп 4 ойы: ЖАҢА ТАҚЫРЫПТЫ МЕҢГЕРУ Презентация мазмұны
Суреттер:
1-топ – t-тест есебі
Мысал
есеп: Жергілікті өзеннің екі бөлігіндегі балық саны:
Гипотезалар:
Қорытынды: Дескриптор:
2-топ – χ²-критерийі
=20/4+30/16+50/4=0.2+0.53+0.08=0.81 df = 2, χ²крит = 5.99
Қорытынды: Дескриптор:
3-топ – ЖИ қолдану
Кездейсоқ іріктеудің артықшылықтары
Қате іріктеудің салдары
ТЕСТ
|
Бірінші Презентация Жұмыс парағы Екінші презентация Жұмыс парағы |
|||||||||||||||||||||||||||
|
Сабақтың соңы 2мин |
Рефлексия. Ең қызығы не болды? Ең тиімдісі не болды? Мен әлі түсінбеймін ... |
|
|||||||||||||||||||||||||||
31 Сабақ ҚМЖ
|
Ұзақ мерзімді жоспар бөлімі: 11.4АБиосфера, экожүйе, популяция |
Экологияжәнеадаміс-әрекетінің қоршаған ортаға әсері |
|||||||||||||||||||
|
Күні: |
Мұғалімнің аты-жөні: |
|||||||||||||||||||
|
Сынып: |
Қатысқандар саны: |
Қатыспағандар саны: |
||||||||||||||||||
|
Сабақ тақырыбы |
Климаттың экологиядлық проблемалары және оны шешу жолдары дебат сабақ |
|||||||||||||||||||
|
Осы сабақта қол жеткізілетін оқу мақсаттары (оқу бағдарламасына сілтеме) |
11.3.2.2 Қазақстанның экологиялық проблемаларын оқып білу және шешу жолдарынұсыну |
|||||||||||||||||||
|
Сабақ мақсаттары |
11.3.2.2 Қазақстанның экологиялық проблемаларын оқып білу және шешу жолдарын ұсынады |
|||||||||||||||||||
|
Адал азамат» біртұтас тәрбие бағдарламасы құндылықтарын енгізу |
Академиялық шыншылдық, нақтылық, өзін өзі реттей білу , ойды реттей білу, сенімділік, дәлелдерді қолдана білу ,өзіне деген сенімділік, өзін-өзі көрсету болу құндылықтары дамытылады. |
|||||||||||||||||||
|
Сабақ барысы |
||||||||||||||||||||
|
Сабақтың жоспарланған кезеңдері |
Сабақтағы жоспарланған іс-әрекет |
Ресурстар |
||||||||||||||||||
|
Сабақтың басы 0-2 САБАҚТЫҢ ОРТАСЫ |
II. ҚЫЗЫҒУШЫЛЫҚТЫОЯТУ (5 мин) AI Видео Тақырып:“Climate Change: Ecological Consequences” Жеке ойлану: 1 экологиялық проблемаНегізгі мәселе: Атырау қаласының атмосфералық ауасының жоғары ластануыАтырау – Қазақстандағы ірі мұнай–газ өнеркәсібі орналасқан қала. Ол жерде мұнай өңдеу зауыты, мұнай және газ объектілері, құбыр желілері, сүзу жүйесі сияқты өндірістер бар, сондықтан ауаның химиялық заттармен, соның ішінде күкіртсутегі (құрымсыз жұмыртқа иісі) сияқты уытты газбен ластануы байқалады. Бұл мәселе тұрғындар арасында ұзақ уақыттан бері байқалып келеді: тұрғындар қаланың кей аудандарында ауа ластанған кезде тыныс алу қиындықтары, бас аурулары және шаршағыштық туралы шағымдануда. Нақты дерекетер Экологиядепартаментініңзерттеулерінесәйкес, Атырауқаласыныңатмосферасыкөптегенкүндеріластанғанжәнеоныңқұрамындауыттыгаздарбар. en.orda.kz Жергілікті тұрғындар Атырау мұнай өңдеу зауыты жұмыс істеген кезде ауада құрамында зиянды заттар пайда болатынын растайды. en.orda.kz Қазақстанның Экологиялық реттеу және бақылау комитеті Атырау қаласын атмосфералық ауа ластанған 10 қала қатарына енгізген Экологиялық проблеманың себептері Себептер:
Табиғи және адамға әсері Адам денсаулығына әсері:
? Табиғи ортаға әсері:
1 шешу жолы Проблеманы шешу жолдары (жалпы ұсыныстар) 1) Құрылған «Жол картасы» бойынша шаралар Атырау облысы Экология департаментінің «Жол картасына» сәйкес:
2) Ғылыми және технологиялық тәсілдер
Қоғамдық бақылау және заңнама
III. ДЕБАТҚАДАЙЫНДЫҚ (10 мин)Дебатрезолюциясы:«Климаттық дағдарысты шешуде технологиялық шешімдер табиғи экожүйені қорғаудан тиімді» Дебатқа арналған нақты аргументтер Үкімет технологиялық шешімдер қолдайды Аргумент 1. Технологиялық жүйелер ауа сапасын жақсартуға әсер етеді
Аргумент 2. Қалдық тазарту және сүзу технологиялары
Аргумент 3. Инновация және ЖИ шешімдері
Аргумент 4. ҚР-да «Жол картасы» жобасы бар
Оппозиция– табиғатты қорғауды қолдайды Аргумент 1. Тек технология жеткіліксіз
Аргумент 2. Табиғи ортаны қорғау түзету шараларын қажет етеді
Аргумент 3. Жергілікті тұрғындардың денсаулығы мен өмір сапасына назар аудару
Аргумент 4. Заң мен қоғамдық бақылауды күшейту керек
|
Презентация MS PowerPoint Слайд 1 Қосымша 1 (диктовкалық белсенділікті айқайлауға арналған бос орындары бар мәтін) Слайд 2-4
Презентация
(PowerPoint) |
||||||||||||||||||
|
|
Сарапшылардың бағалауы
|
|
||||||||||||||||||
|
Сабақтың соңы 39-40 мин |
|
Слайд 8
|
||||||||||||||||||
32 Сабақ ҚМЖ
|
Ұзақ мерзімді жоспар бөлімі:. |
Экология және адам іс-әрекетінің қоршаған ортаға әсері. |
|||
|
Күні: |
Мұғалімнің аты-жөні: |
|||
|
Сынып: 11 |
Қатысқандар саны:
|
Қатыспағандар саны: |
||
|
Сабақ тақырыбы |
Ғаламдық жылыну: себептері, салдарлары және шешу жолдары. |
|||
|
Осы сабақта қол жеткізілетін оқу мақсаттары (оқу бағдарламасына сілтеме) |
11.3.2.1 - мүмкін болатын климаттың жаһандық жылыну салдарын болжау. |
|||
|
Сабақ мақсаттары |
|
|||
|
Бағалау критерийлері |
|
|||
|
Адал азамат» біртұтас тәрбие бағдарламасы құндылықтарын енгізу |
Академиялық шыншылдық, нақтылық, өзін өзі реттей білу , ойды реттей білу, сенімділік, дәлелдерді қолдана білу ,өзіне деген сенімділік, өзін-өзі көрсету болу құндылықтары дамытылады. |
|||
|
Сабақ барысы |
||||
|
Сабақтың жоспарланған кезеңдері |
Сабақтағы жоспарланған іс-әрекет
|
Ресурстар |
||
|
Сабақтың басы 0-4 мин |
1 Ұйымдастыру кезеңі (3 мин)
II. Қызығушылықты ояту– Видео + ЖИ
Күрделі заманауи
видео «Егер ғаламдық температура 2°C-қа артса, Қазақстанға әсері қандай болады?» Жеке жұмыс Егер ғаламдық температура 2°C-қа артса, Қазақстанға әсері қандай болады?» Ғылыми негізделген болжам
пікір (қорытынды): Егер адамзат әрекетін өзгертпесе, 2050 жылға қарай ғаламдық жылыну экологиялық дағдарыстан гуманитарлық апатқа айналады.
Дескриптор:
|
ИТ, презентация 1-3 слайдтар ИТ, презентация 4-5 слайдтар |
||
|
Сабақтың ортасы 4-36 мин |
Мағынаны ашу 1-тапсырма – Топтық жұмыс (Jigsaw әдісі)
1-топ: Ғаламдық жылыну
себептері Презентация + инфографика + суреттер Аргументтер:
Мысал: Қарсы пікірлер:
Мысал:
Қорытынды (Топтық шешім)
Ғаламдық
жылынуды толық тоқтату
қиын, бірақ
баяулатуға және салдарын
азайтуға адамзаттың мүмкіндігі
бар. Дескриптор:
2-тапсырма – Жұптық жұмыс (Суретпен талдау)
Суреттер:
Мұздықтардың еруі Құрғақшылық Орман өрті Су тасқыны Тапсырма:
1-сурет: Мұздықтардың еруі
2-сурет: Құрғақшылық
3-сурет: Орман өрті
4-сурет: Су тасқыны
Дескриптор:
тест тапсырмасы
1. Ғаламдық жылынудың
негізгі себебі:
2. Парниктік газға
жатады:
3. Ғаламдық жылынудың
салдары емес:
4. Мұздықтардың еруі нені
арттырады?
5. Қазақстанда ғаламдық
жылынудың басты салдары:
6. Климаттың өзгеруі
экожүйеге әсері:
7. Ғаламдық жылынуды
азайтудың бір жолы:
8. Жаңартылатын энергия
көзі:
9. Ғаламдық жылыну қандай
масштабта?
10. Ғаламдық жылыну
мәселесін шешуде маңыздысы: |
ИТ, презентация 6-19 слайдтар Теориялық материал. Бейнебаяндар. |
||
|
Сабақтың соңы 37-40 мин |
3–2–1» әдісі
|
ИТ, презентация 20 слайд |
||
33 –сабақ дебат сабақ ҚМЖ
Сабақтың тақырыбы:: «Табиғат – ортақ үйіміз» (Атырау қаласы мысалында)
Сабақтың мақсаты: Оқушылардың болашақ мамандығы экология, инженерия, су ресурстары сияқты бағыттар болғандықтан, олардың сөздері ғылыми негізге сүйеніп, экологиялық сауаттылық пен талдау дағдысын дамытуға бағытталады
Бұл бөлімде 11сынып оқушыларына арналған дебаттың аргументтерді дайындау кезеңі толық сипатталған. Оқушылар 5 минут ішінде өз ұстанымдарын нақты деректер мен ғылыми дәлелдер арқылы қорғайды. Дебат екі топқа бөлінеді: Топ A – Өнеркәсіп дамуын жақтаушылар, Топ B – Табиғатты қорғаушылар.
Аргументтерді дайындау уақыты – 5 минут
Әр топ өз көзқарасын дәлелдейтін 3–4 аргумент дайындайды. Мақсат – ғылыми негізге сүйену, экологиялық деректерді қолдану және нақты ұсыныстар айту.
Бұл дебат 11-сынып оқушыларына арналған.
Тақырып Атырау қаласының экологиялық жағдайына, өнеркәсіптің (АНПЗ, химия зауыты) және Жайық өзені маңының ластануына негізделеді. Оқушылардың болашақ мамандығы экология, инженерия, су ресурстары сияқты бағыттар болғандықтан, олардың сөздері ғылыми негізге сүйеніп, экологиялық сауаттылық пен талдау дағдысын дамытуға бағытталады.
I. Кіріспе
Мақсаты: оқушылардың
экологиялық сауаттылығын арттыру, ғылыми деректерді қолдана отырып
экологиялық мәселелерді талдау және шешу жолдарын ұсыну.
Форматы: пікірталас-дебат (екі жақты).
Тақырып: «Табиғат – ортақ үйіміз». Атырау қаласы
мысалында.
II. Рөлдер мен құрам
-
1. Модератор Ойынды жүргізеді, сұрақтар мен тәртіпті бақылайды.
-
2. 1-топ – Өнеркәсіпті жақтаушылар (инженерлер, технология мамандары).
-
3. 2-топ – Табиғатты қорғаушылар (экологтар, су ресурстары мамандары).
-
4. Сарапшылар тобы – Бағалау, қорытынды шығару.
V. Қамылатын сұрақтар
-
1. Атырау қаласында ауа сапасының нашарлауына негізгі себеп қандай?
-
2. Өндіріс пен экология арасындағы тепе-теңдікті қалай сақтауға болады?
-
3. Инженерлік тұрғыдан шығарындыларды азайту үшін қандай технологияларды қолдануға болады?
-
4. Экологиялық мониторинг пен деректерді ашық жүргізу не үшін маңызды?
-
5. Жайық өзенін қорғауға қандай шаралар қажет?
-
6. Қалалық тұрғындардың экологиялық мәдениетін арттыру жолдары қандай?
VI. Аргументтер кестесі
|
Тарап |
Аргумент |
Ғылыми негіз / дерек |
|
Өнеркәсіпті жақтаушылар |
Өндіріс аймақ экономикасын дамытады |
Технологиялық жаңғырту шығарындыларды 40%-ға азайтады |
|
Табиғатты қорғаушылар |
Ауаның ластануы халық денсаулығына зиян |
Зияндызаттар менH₂S көрсеткіштері нормадан 4–8 есе жоғары |
|
Экологтар |
Жайық өзені суының сапасы төмендеген |
Суда ауыр металдар мен мұнай өнімдері анықталған |
VII. Бағалау парағы
Әр критерий 1–5 балл аралығында бағаланады.
|
Критерий |
Сипаттама |
Баға (1–5) |
|
Ғылыми дәлдік |
Оқушының айтқан деректері нақты және ғылымға негізделген |
|
|
Логикалық құрылым |
Ойы жүйелі, аргументі дәйекті |
|
|
Коммуникативтік дағды |
Өз ойын анық жеткізе білу, дәлел келтіру |
|
|
Сын тұрғысынан ойлау |
Қарсы тараптың пікірін талдай алу |
|
|
Шешім ұсыну |
Нақты экологиялық шешім ұсыну және қорғау |
|
Сарапшылар дебат соңында әр топтың нәтижесін бағалайды. Ең жоғары ұпай жинаған топ «Экологиялық ойлауы жоғары команда» деп танылады.
Аргументтерді дайындау кезеңінде екі топ өз көзқарасын ғылыми дәлелдермен нығайтады. Топ A – инженерлер – экологиялық қауіпсіз технологияларды ұсыну арқылы өндіріс пен табиғатты тең ұстауға тырысады. Топ B – экологтар мен су мамандары – адам денсаулығы мен табиғи тепе-теңдікті басты орынға қояды. Мақсат – экологиялық және экономикалық тұрақтылықтың үйлесімді шешімін табу.
Топ A: Өнеркәсіп дамуын жақтаушылар (инженерлердің ұстанымы)
Бұл топтың негізгі идеясы – өндіріс қаланың экономикалық дамуының өзегі, бірақ экологиялық қауіпсіздік технологиялық жаңғырту арқылы қамтамасыз етілуі мүмкін.
Аргумент 1. Экономикалық даму мен жұмыспен қамту**
Атырау қаласы Қазақстан экономикасының маңызды мұнай орталығы. Атырау мұнай өңдеу зауыты (АНПЗ) мен Теңізшевройл сияқты кәсіпорындар мыңдаған адамды жұмыспен қамтып отыр. 2023 жылғы мәлімет бойынша, тек АНПЗ-де 2000-нан астам адам тұрақты жұмыс істейді. Бұл өңірдің ЖІӨ-нің 40%-ы мұнай өнеркәсібінен түседі. Мұнай өңдеу зауытының маңызы.Мұнай өңдеу зауыттары – шикі мұнайды түрлі пайдалы өнімдерге айналдыратын кәсіпорындар. Маңызы: Энергия көзі – бензин, дизель отыны, мазут сияқты жанармай түрлерін өндіреді. Өнеркәсіптің басқа салаларына шикізат береді – пластмасса, синтетикалық талшық, резеңке, химиялық заттар жасауға пайдаланылады. Экономикалық пайда – экспорт арқылы ел қазынасына үлкен кіріс түсіреді. Жұмыс орындары – аймақтық экономиканы дамытуға, инфрақұрылымды жақсартуға ықпал етеді.
Газ өндіру өнеркәсібінің маңызыГаз – таза әрі тиімді энергия көзі. Маңызы:
Энергетикада қолданылады – электр энергиясын өндіруде, тұрмыстық жылыту жүйелерінде пайдаланылады. Экологиялық тұрғыдан тиімді – көмір мен мазутқа қарағанда атмосфераны аз ластайды.
Химия және өнеркәсіп салаларына шикізат береді – тыңайтқыш, пластмасса, резеңке өндірісінде қолданылады. Экспорт әлеуеті жоғары – Қазақстан сияқты елдер үшін шетелге сатылатын маңызды табиғи ресурс.
Мұнай және газ кендерін игеру.Мұнай мен газ кен орындарын барлау және игеру – елдің стратегиялық маңызы бар саласы. Маңызы: Мемлекеттің энергетикалық қауіпсіздігін қамтамасыз етеді. Аймақтық дамуға ықпал етеді – жол, тұрғын үй, әлеуметтік нысандар салынады. Инвестиция тартады – шетелдік және отандық компаниялар экономиканың дамуына үлес қосады.
Химия өнеркәсібінің маңызы.Химия зауыттары – мұнай мен газ өнімдерін өңдеп, түрлі өндірістік және тұрмыстық заттарды шығарады. Маңызы: Шикізатты терең өңдеу арқылы қосымша құн жасайды. Ауыл шаруашылығына тыңайтқыш, өсімдікті қорғау құралдарын өндіреді. Жеңіл өнеркәсіпке – бояу, пластмасса, талшық, сабын, парфюмерия сияқты өнімдер береді. Экономиканы әртараптандырады, яғни ел тек шикізат экспорттаумен шектелмей, дайын өнім шығара бастайды.
Қорытынды: Мұнай өңдеу, газ өндіру және химия зауыттары – елдің индустриялық дамуының тірегі. Бұл салалар:, ұлттық табысты арттырады, жаңа технологияларды енгізеді, халықтың өмір сапасын жақсартады
Аргумент 2. Экологиялық технологиялар енгізілуде**
Соңғы жылдары зауыттарда экологиялық жаңғырту жұмыстары жүргізілуде. Мысалы, 2022 жылы АНПЗ-де күкірт қалдықтарын өңдейтін жаңа кешен іске қосылды. Бұл атмосфераға тарайтын зиянды шығарындыларды 38%-ға дейін азайтуға мүмкіндік берді. (Дерек көзі: KMG Engineering, 2023 ж.) Инженерлік тұрғыдан, катализдік риформинг және газ тазалау жүйелері (Gas Treatment Units) арқылы NO₂ және SO₂ бөлінуін 50%-ға азайтуға болады. Болашақ инженерлер ретінде біз табиғатты қорғау мен өндірісті қатар дамыту мүмкін екенін дәлелдей аламыз. Өнеркәсіптегі экологиялық жаңғырту жұмыстары
Соңғы жылдары елімізде өнеркәсіп саласында экологиялық жаңғырту жұмыстары кеңінен жүргізілуде. Бұл шаралардың басты мақсаты – табиғатты қорғау, ауа мен судың ластануын азайту және өндірістің тұрақты дамуын қамтамасыз ету.
Мұнай өңдеу зауыттарында экологиялық жаңғырту нәтижесінде жаңа технологиялар енгізілуде. Зауыттарда мұнайды терең өңдеу деңгейі арттырылып, зиянды қалдықтар мен газдар шығарындылары азайтылуда. Арнайы тазарту қондырғылары орнатылып, ағын сулар биологиялық және механикалық әдіспен тазартылады. Бұл атмосфера мен өзен-көлдердің ластануын едәуір төмендетеді.
Химия зауыттарында экологиялық қауіпсіз өндіріс процестері енгізілуде. Зиянды реагенттердің орнына экологиялық таза материалдар қолданылып, қалдықсыз немесе аз қалдықты технологиялар пайдаланылуда. Сондай-ақ, зауыттарда қалдықтарды қайта өңдеу және қайта пайдалану жүйесі дамып келеді.
Мұнай және газ кен орындарында да экологиялық шаралар қолға алынған. Ұңғымалардан бөлінетін газдарды өртеу орнына, оларды жинап қайта пайдалану жүйесі енгізілуде. Топырақ пен жер асты суларының ластануын болдырмау үшін экологиялық бақылау күшейтіліп, жерді рекультивациялау (яғни бұрынғы табиғи қалпына келтіру) жұмыстары жүргізілуде
Аргумент 3. Технологиялық шешім – басты бағыт**
Қазіргі кезде зауыттар мен кен орындарында технологиялық жаңару мен цифрландыру – басты шешімге айналды. Заманауи технологиялар өндірістің тиімділігін арттырып қана қоймай, экологиялық қауіпсіздікті қамтамасыз етеді.
Жаңа автоматтандырылған жүйелер мен цифрлық бақылау құралдары арқылы өндіріс процестері нақты және жылдам басқарылады. Бұл энергияны үнемдеуге, шикізатты тиімді пайдалануға және қалдықтарды азайтуға мүмкіндік береді.
Мұнай, газ және химия салаларында жаңа буын қондырғылар енгізіліп, «жасыл технологиялар» қолданыла бастады. Мысалы, шығарындыларды азайтатын сүзгі жүйелері, суды қайта пайдалану станциялары және интеллектуалды ұңғымалар кеңінен таралуда.
Осылайша, технологиялық бағыт – қазіргі өнеркәсіптің бәсекеге қабілеттілігі мен экологиялық тұрақтылығын қамтамасыз ететін негізгі фактор болып отыр.
Мысалы:Инженерлік тұрғыдан, катализдік риформинг және газ тазалау жүйелері (Gas Treatment Units) арқылы NO₂ және SO₂ бөлінуін 50%-ға азайтуға болады. Болашақ инженерлер ретінде біз табиғатты қорғау мен өндірісті қатар дамыту мүмкін екенін дәлелдей аламыз. Өнеркәсіптегі экологиялық жаңғырту жұмыстары
Қорыта айтқанда, экологиялық жаңғырту – бүгінгі өнеркәсіптің маңызды бағыты. Табиғатты қорғау мен ресурстарды үнемдеу арқылы өндіріс пен экология арасындағы тепе-теңдікті сақтау – еліміздің тұрақты дамуының кепілі.
Аргумент 4. Қалдықсыз өндіріс қағидаты**
Қалдықсыз өндіріс – табиғи ресурстарды тиімді пайдаланып, өндіріс барысында пайда болатын қалдықтарды барынша азайту немесе толық қайта өңдеу жүйесі. Бұл бағытта зауыттар мен кен орындарында бірқатар маңызды жұмыстар жүргізілуде:
1. Қалдықтарды қайта өңдеу және қайта пайдалану – өндірістен шыққан шикізат қалдықтары мен суларды қайта өңдеп, екінші рет өндіріс процесіне енгізу.
Мысалы: мұнай өңдеу зауыттарында қалдық газдар мен суларды тазалап, қайта қолдану.
2. Қалдықсыз технологиялар енгізу – өнім өндіру кезінде артық қалдық қалдырмайтын жаңа технологиялар мен жабдықтар пайдалану.
Мысалы: химия зауыттарында реакцияны толық өтетіндей етіп жасау, қосымша өнімдерді жаңа материалдарға айналдыру.
3. Энергия мен ресурстарды үнемдеу – энергия үнемдейтін жабдықтар мен автоматтандырылған басқару жүйелерін қолдану.
Мысалы: газ кен орындарында ілеспе газды өртеу орнына, оны қайта пайдалану арқылы энергия өндіру.*
4. Экологиялық бақылау және мониторинг жүйесі – өндіріс кезінде ауа, су, топырақ сапасын тұрақты бақылау, ластану деңгейін азайту.
5. Жасыл экономикаға көшу – жаңартылатын энергия көздерін (күн, жел энергиясы) пайдалану және экологиялық таза өнім өндіру.
Қазақстанның «Жасыл экономика» тұжырымдамасы бойынша 2030 жылға қарай қалдықсыз өндіріс үлесін 15%-ға жеткізу көзделген. Бұл бағытта инженерлердің басты рөлі – ресурстарды үнемдеп, қайта өңдеуді арттыру.
Топ B: Табиғатты қорғаушылар (экологтар мен су мамандарының ұстанымы)
Бұл топ табиғат пен адамның денсаулығын бірінші орынға қояды. Олар экологиялық тепе-теңдік бұзылса, экономикалық пайда мағынасыз деп санайды.
Аргумент 1. Ауаның ластану деңгейі өте жоғары**
Атырау қаласы – Қазақстандағы ауасы ең лас қалалардың бірі. ‘Қазгидромет’ деректері бойынша, 2023 жылы атмосфералық ауа сапасының индексі (AQI) – 178 (қауіпті деңгей). H₂S (күкіртсутегі) мөлшері кей аудандарда шекті нормадан 6–8 есе жоғары тіркелген. Бұл өкпе және бронх ауруларының, аллергиялық реакциялардың артуына әкеледі. егізгі себептері және деректер
1. Көмірсутекті өндірістен шығатын шығарындылар — өртеу (flaring), желдету және төгілу (venting, fugitive emissions).
Теңіз және басқа кен орындарындағы факелдар мен ұңғыма операцияларының шығарындылары — SO₂, NOx, күкірт қосылыстары, VOC (летучие органикалық заттар) және бөлшекшелердің (PM) көзі. Бұған қатысты сараптамалық зерттеулер факелдан шығатын заттардың көлемін талдайды және олардың аймақтық әсерін көрсетеді.
2. Өнеркәсіптік өндіріс көлемінің үлкендігі (Теңіз, Атырау мұнай өңдеу зауыты, химия кәсіпорындары).
Теңізшевройл (TCO) — аймақтағы ірі өндірушілердің бірі; компания өз есептерінде 2000 жылдан бері өртеуді (flaring) және шығарындыларды едәуір қысқартқанын жазады, бірақ өндіріс көлемі жоғары болғандықтан абсолюттік әсер аймаққа сезіледі. (TCO: «record low emissions intensity»; flaring көлемі 2000 жылдан бері 93% төмендегені туралы деректер).
3. Мұнай өңдеу зауытының және ескі қондырғылардың әсері — күкірт және бөлшекшелер.
Атырау мұнай өңдеу зауытында жаңғырту жұмыстары жүргізіліп жатқаны туралы ақпарат бар, бірақ үлкен көлемді өңдеу (миллиондаған тонна шикізат) атмосфераға әсерін сақтайды; өңдеу өнімі жоғары болған сайын эмиссия басқаруы маңызды. Мысалы, зауыт энергетикасы мен отын сапасын жақсарту болжамдары бар.
4. Метеорологиялық және географиялық факторлар — жағдайды ушықтыра алады.
Қысқы ауа инверсиялары, желдің әлсіздігі, аймақтың түздығымен (Caspian аймағы) байланысты шаң-тозаң (dust) және Каспийдің тартылуы (сезондық шаңды дауылдар) да ауа сапасын нашарлатуы мүмкін. Бұл факторлар өнеркәсіптік эмиссияларды қалаға жинақтап, тұрғындарға зиян келтіреді. (Аймақтық экология мәселелері мен Каспий деңгейінің өзгеруі туралы мақалалар).
5. Мониторинг және қоғамдық алаңдаушылық — бақылау жүйелерінің шектеулері.
Қалалық және тәуелсіз станциялар арасына айырмашылықтар бар; онлайн-карталар (IQAir, AQICN, AirKaz) нақты уақыттағы PM2.5/PM10 мәндерін көрсетеді — кей күндері AQI «орташа» және «қанағаттанарлық» болса да, қауіпті «жоғары» межені басып өтеді. Жергілікті БАҚ пен белсенділер өнеркәсіптің әсеріне жиі шағымданады.
Аргумент 2. Денсаулыққа тікелей әсері бар**
Нақты деректер (мысал ретінде)
Tengiz/TШO: компания есептерінде 2023 жылы «шығындылық/эмиссия интенсивтігі» 2000 жылдан бергі ең төменгі деңгейге түскені және фларинг көлемі соңғы 5 жылда 57% азайғаны айтылады; сонымен бірге өндіріс көлемі жоғары. (TШO корпоративтік есептері).
Ауа сапасының көрсеткіші (реал-тайм): IQAir және AQICN сайттарында Атырау бойынша PM2.5 және AQI деректері қолжетімді; мысалы, белгілі уақыттарда AQI ~50–60 (орташа деңгей) тіркеледі, ал жоғары ластану күндерінде бірнеше есе көтеріледі. (IQAir, AQICN нақты уақыттық станциялар).
Ғылыми талдаулар: факелдардан шығатын заттар мен олардың көлемін талдаған жарияланымдар бар — факелдық шығарындылардың аймақтық ластаушы рөлін көрсетеді.
Неліктен «зауыттар/кен орындар ауа сапасын сақтамай отыр» деген пікір қалыптасады?
Өндірістің көлемі мен техникалық күрделілігі — тіпті техникалық шаралар жасалғанымен, абсолютті шығарындылар байқалады. (TCO деректері жақсаруға бағытталса да, тұрғындар әсерін сезінуі мүмкін).
Факелдау мен төгілудің (venting) кешенді әсері — жылдам және көрінетін ластану көздері.
Мониторинг желісінің шектеулері мен қоғамдық сенімнің төмен болуы — кейде ресми есептер мен жергілікті тәжірибе арасында сәйкессіздік көрінеді.
Атырау облыстық денсаулық сақтау басқармасының дерегі бойынша, соңғы 5 жылда тыныс алу органдары аурулары 27%-ға артқан. Балалар арасында астма мен бронхит жиілеген. Қала тұрғындары арасында қатерлі ісік ауруларының көрсеткіші де республика бойынша ең жоғары үштікке кіреді.
Аргумент 3. Жайық өзенінің экологиялық жағдайы нашарлап барады**Ғылыми зерттеу мәліметтері бойынша Жайық өзенінің төменгі ағысында (Қазақстандағы бөлігінде) нитриттер, бор (boron) және мұнай өнімдері рұқсат етілген шектен жоғары деңгейде анықталған. Бұрынғы жылдармен салыстырғанда су көлемі едәуір төмендеген: соңғы 20 жылда өзеннің су мөлшері шамамен 12 км³-тен 5 км³-ке дейін азайғаны айтылған.
Жайық басқаратын бассейн бойынша ұзақ мерзімді мониторинг нәтижелері: төмен су деңгейі, су аймағының тарылуы, балығы мен табиғи жаға аймақтарының жойылуы байқалған.
Судың сапасы жағынан: «Поли-хлорланған дифенилдер» (PCBs) сияқты жоғары токсикалы заттардың концентрациясы да өзенде анықталған — мысалы 0.93-1.29 µg/L деңгейінде.
Негізгі мәселелер: Судың азаюы → су аймағы тарылып, жағалау экожүйелері бұзылуда. Қалдықтар мен өнеркәсіптік эмиссиялар (мұнай өнімдері, химиялық заттар) өзен экологиясына зиян келтіруде.
Трансшекаралық өзен болғандықтан (Россия және Қазақстан арқылы) су бөлу, реттеу, су алаптарының дамуы мәселелері маңызды.
Каспий теңізі деңгейінің төмендеуі
Деректер:
Каспий теңізінің суы соңғы жылдары өзінше төмендеуде: мысалы, 1979-2015 жылдар аралығында орташа су бетінің деңгейі төмендегені айтылған.
Қазақстанның экология министрлігі мәліметтері бойынша Каспий жағалауында 22 000 шаршы километрден астам аумақ су деңгейінің төмендеуінен құрғақтанған.
Әсіресе солтүстік бөлігі (Қазақстан жағалауы) қатты зардап шегіп отыр — мысалы, жағалау сызығы 20-30 км-ге шегінген.
Себептері: Су кірісінің азаюы: Теңізге ағатын үлкен өзендердің (мысалы, Волга өзені және Жайық өзені) ағысы тұрақты азайған.
Климаттық өзгерістер: жауын-шашынның азаюы, температураның көтерілуі, буланудың жоғарылауы.
Суға арналған инженерлік құрылымдар: су қоймалары, бөгеттер, трансшекаралық су басқару — өзендердің Каспийге ағып кіруін төмендетуде.
Қауіпті салдары: Экожүйелер зардап шегуде: жағалаудың тарылуы, балық пен маңызы бар түрлердің бағасы төмендеуде.
Суармалы жерлер мен тұрғын аймақтар үшін қауіп: су көзінің азаюы мен тұщы-тұзды теңгерімнің бұзылуы.
Қаржы және инфрақұрылым мәселелері: порттар, теңіз көлігі, мұнай-газ платформалары төмен су деңгейімен күресуде.
Жайық өзенінің су сапасы ‘орташа ластанған’ санатында. Суда мұнай өнімдерінің және ауыр металдардың (мыс, қорғасын, мырыш) мөлшері нормадан 2–5 есе жоғары. Бұл биожүйеге, балық шаруашылығына және ауызсу сапасына зиян келтіреді.
Аргумент 4.1. Халықтың өмір сүру сапасына әсеріне тоқталсам
1.Ауаның ластануы — нақты оқиғалар мен артық көрсеткіштергетоқталсақ (H₂S) — қауіпті және жиі тіркелетін ұшымаған газ: 2023 жылы Атырауда H₂S деңгейінің 20 есе артық тіркелгені туралы ақпарат жарияланған. Кейбір оқиғаларда түнгі уақытта 32 есе артық мөлшер анықталғаны хабарланды. Бұл көрсеткіштер тұрғындардың қатты улануы мен тыныс алудың қиындауына тікелей себеп болады.
2025 жылдың маусымында да жергілікті хабарлар мен мониторинг нәтижелері H₂S деңгейінің қауіпті деңгейден 11 есе жоғары болғанын жариялады (өршіп жатқан шөп-шалдық пен өнеркәсіптен шыққан түтін әсері). Мұндай шоғырланулар тұрғындардың тері, көз күйдіруі, бас айналу, жүрек-тамыр және тыныс алу проблемаларын тудырады.
Не маңызды: H₂S-тің жоғары дозалары өлімге дейін әкелуі мүмкін; төмен деңгейдегі ұзақ мерзімді әсерлері — бас ауруы, жөтел, тыныс алу жолдарының созылмалы аурулары, репродуктивті және жүйелік әсерлер. (экологиялық-медициналық зерттеулер көрсеткен).
2) Денсаулық статистикасы — нақты көрсеткіштер мен тенденциялар
Туберкулез (мысал): Атырау облысы бойынша 2022 жылдың 8 айында жаңадан 271 науқас тіркелген; бұл 2021 жылғы осы кезеңмен салыстырғанда 9.8% кемігенімен аймақ туберкулез бойынша әлі де «қауіпті» топқа жатады — тұрғындардың жалпы жұқпалы ауру жүктемесіне әсері бар. (Ресми облыстық хабарлама).
Жалпы аурушаңдық құрылымы: жергілікті медициналық зерттеулер мен есептер бойынша Атырауда тұрғындардың медициналық мекемелерге жүгінуінің негізгі себептерінің бірі — тыныс алу мүшелерінің аурулары (жоғары орындардың бірі). Бұл зерттеулер өнеркәсіптік шығарындылар мен ауаның нашарлауын себебі ретінде көрсетеді.
3) Халықтың күнделікті өміріне әсері — нақты мысалдар
Кезекші шағымдар: тұрғындар H₂S ұрықтайтын жағымсыз иістен, жөтел мен көз күйдіруінен шағымданады; кей күндері мектептер мен балабақшаларда ауа сапасының нашарлауына байланысты сыртқа шығуға шектеу қойылған немесе адамдар терезелерін ашпаған жағдайлар тіркелген. (жергілікті БАҚ хабарламалары мен тұрғын шағымдары).
Экономикалық әсері: балық шаруашылығының және жағалау инфрақұрылымдарының зардап шегуі — бұл жергілікті халықтың табыс көзіне әсер етеді (порттар, балық өңдеу). Каспий жағалауының тартылуы және өзендердің ағысының азаюы ауыл шаруашылығына да кері әсер етеді. (қоршаған орта сараптамалары).
4) Ғылыми және өңірлік мониторинг нәтижелерінен қорытындылар
Бүгінгі мониторинг пен зерттеулер ауыр және уытты газдардың, сондай-ақ мұнай өнімдері мен химиялық заттардың (органика, бор, т.б.) жиналатынын көрсетеді. Бұл — созылмалы аурулардың өсуіне, әсіресе тыныс алу және жүрек-қантамыр жүйесінің сырқаттарына әкеліп соғуда.
5) Қолдан келетін нақты деректер
H₂S артықшылығы: 11× (маусым 2025), 20× (апрель 2023), 32× (26 қазан, жыл белгіленген оқиға) — әрқайсысы жергілікті мониторинг пен БАҚ-та жарияланған оқиғалар.
Туберкулез — 271 жаңа жағдай (8 ай, 2022) — ресми облыстық дерек.
Ғылыми мақалалар мен жергілікті зерттеулер Атырауда тыныс алу ауруларының (мыс., бронхит, созылмалы бронхит, астма симптомдары) негізгі себептердің бірі екенін растайды.
6) Қорытынды және ұсыныстар (қысқа)
Қорытынды: Атырау өңіріндегі өнеркәсіптік ластану — H₂S-тің бірнеше есе асып кетуі, мұнай және химиялық қалдықтардың су мен топыраққа түсуі, және Каспий деңгейінің төмендеуі — барлығы халықтың денсаулығы мен күнделікті тұрмыс сапасына тікелей әсер етуде: тыныс алу аурулары, экономикалық жоғалту (табыстың төмендеуі), өмір сапасының нашарлауы.
Ұсыныстар (жедел):
1. Тәуелсіз және ашық ауа мониторинг станцияларын көбейту (онлайн және қол жетімді деректер).
2. Халықтың денсаулығын бақылау — медициналық скринингтер (тыныс алу, жүрек-қантамыр) және өкпе функциясын тексеру.
3. Өнеркәсіптік шығарындыларды қысқарту: фларингті азайту, H₂S жинау және тазарту жүйелерін енгізу.
4. Қоғамдық хабардарлық: қауіпті күндерде тұрғындарға алдын ала ескерту және қауіпсіздік нұсқаулары.
БҰҰ деректері бойынша, экологиялық факторлар өмір сүру ұзақтығын 3–5 жылға қысқартады. Атыраудағы ластану деңгейі халықтың денсаулығына және әлеуметтік әл-ауқатына қауіп төндіреді.
Қорытынды
Аргументтерді дайындау кезеңінде екі топ өз көзқарасын ғылыми дәлелдермен нығайтады. Топ A – инженерлер – экологиялық қауіпсіз технологияларды ұсыну арқылы өндіріс пен табиғатты тең ұстауға тырысады. Топ B – экологтар мен су мамандары – адам денсаулығы мен табиғи тепе-теңдікті басты орынға қояды. Мақсат – экологиялық және экономикалық тұрақтылықтың үйлесімді шешімін табу.
34 сабақ ҚМЖ
Сабақтың тақырыбы : Жобалық жұмыс: «Жасыл желек – ауыл экожүйесінің тынысы»
Сабақтың мақсаты : ауылдық аймақтағы экологиялық мәдениетті арттыруға, көгалдандырудың экологиялық әсерін зерттеуге және оқушылардың зерттеушілік қабілеттерін дамытуға бағытталған.
1. Кіріспе
Қазіргі уақытта ауылдық аймақтарда жасыл желектерді көбейту мен экожүйені жақсарту маңызды міндеттердің бірі болып отыр. Ауыл тұрғындарының белсенді қатысуымен көшелер бойына ағаш отырғызу, мектеп ауласын көгалдандыру және демалыс орындарын жасау – экологиялық сана мен ынтымақтастықтың нақты көрінісі болып табылады.
Бұл жобада оқушылар өз ауылындағы көгалдандыру шараларының нәтижесін зерттеп, ғылыми тұрғыда талдау жасайды.
2. Жобаның мақсаты
Ауыл аумағындағы көгалдандыру шараларының тиімділігін анықтау және өсімдіктердің ауыл экожүйесін жақсартудағы рөлін зерттеу.
3. Міндеттері
-
1. Ауылдағы отырғызылған ағаш түрлерін (тал, терек және т.б.) анықтау.
-
2. Жасыл желектің экологиялық маңызын түсіндіру.
-
3. Мектеп ауласы мен көшелер бойындағы ағаштардың өсу динамикасын бақылау.
-
4. Ауыл тұрғындарының экологиялық мәдениеті мен қатысу деңгейін зерттеу.
-
5. Көгалдандыру жұмыстарының тиімділігін арттыру бойынша ұсыныстар жасау.
4. Зерттеу нысаны мен пәні
Зерттеу нысаны: ауыл көшелері мен мектеп ауласындағы отырғызылған ағаштар (тал, терек).
Зерттеу пәні: жасыл желектің экологиялық және әлеуметтік әсері.
Зерттеу аймағы: Атырау облысы, ауылдық елді мекен.
5. Зерттеу әдістері
• Бақылау әдісі – ағаштардың өсу биіктігі, жапырақ көлемі, түсі және жағдайын бақылау.
• Өлшеу және салыстыру әдісі – жылдар арасындағы өсім динамикасын салыстыру.
• Сауалнама және сұхбат – ауыл тұрғындары мен оқушылардың көзқарасын білу.
• Фотофиксация – көгалдандыру процесін фото және бейне материалдармен тіркеу.
• Математикалық талдау – отырғызылған және тірі қалған ағаштардың пайыздық үлесін есептеу.
6. Күтілетін нәтижелер
• Ауыл экожүйесінің сапасы жақсарады (ауа, ылғал, көлеңке).
• Оқушылардың зерттеушілік қабілеті мен экологиялық мәдениеті артады.
• Мектеп пен ауыл тұрғындары арасында экологиялық ынтымақтастық қалыптасады.
• «Жасыл белдеу» картасы жасалады (ағаш түрлері мен орналасқан жерлері).
• Болашақта жобаны кеңейту үшін нақты ұсыныстар әзірленеді.
7. Жобаны орындау кезеңдері
|
Кезең |
Уақыты |
Іс-шара мазмұны |
|
I кезең |
1 апта |
Ағаш түрлері мен отырғызылған орындарды анықтау. |
|
II кезең |
2 апта |
Ағаштардың өсуін бақылау және өлшеу. |
|
III кезең |
3 апта |
Ауыл тұрғындары арасында сауалнама жүргізу. |
|
IV кезең |
4 апта |
Нәтижелерді талдау және диаграмма жасау. |
|
V кезең |
5 апта |
Қорытынды баяндама және ұсыныстар әзірлеу. |
8. Нәтижелерді ұсыну форматы
• Презентация (PowerPoint
форматында);
• Фотоесеп және инфографика;
• «Жасыл белдеу» картасы;
• Ғылыми баяндама (мектеп немесе аудандық
конференцияға).
9. Ұсыныстар
• Әр сынып өз көшесіне жауапты
болсын.
• Әр ағашқа тақтайша немесе QR-код орнатып, «экологиялық паспорт»
жасау.
• Мектеп жанынан «Жасыл зертхана» клубын құру.
• Тамшылатып суару жүйесін енгізу және маусымдық күтім
ұйымдастыру.
10. Қорытынды
«Жасыл желек» жобасы ауылдық экожүйені сақтау мен көркейтуге бағытталған. Жоба барысында оқушылар нақты зерттеу дағдыларын меңгереді, экологиялық сана қалыптастырады және туған жер табиғатына жауапкершілікпен қарауды үйренеді.
Пайдаланылған әдебиеттер:
-
Бейсенова, Ә. С., Шілдебаев, Ж. Б., Сүлейменова, Э. Н. (2019). Жалпы биология. Алматы: Мектеп.
-
Мырзагалиева, А. Т. (2020). Молекулалық биология және генетика. Алматы: Қазақ университетi.
-
Тұрлыбекова, А. С. (2021). Информатика және жасанды интеллект негіздері. Астана: Фолиант.
-
Ахметова, А. Б. (2022). Биоинформатика: оқу құралы. Алматы: Қазақ университеті.
-
Сейтқазина, Г. К. (2023). Биологияны оқыту әдістемесі. Алматы: Рауан.
-
Қазақстан Республикасы Білім және ғылым министрлігі. (2020). Жаратылыстану-математикалық бағыттағы пәндерді оқыту тұжырымдамасы.
-
UNESCO (2021). Ethics of Artificial Intelligence: Global Frameworksand Recommendations. Paris: UNESCO Publishing.
-
Гудфеллоу, И., Бенжио, Й., Курвиль, А. (2020). Глубокое обучение. М.: Диалектика.
-
Норвиг, П., Рассел, С. (2021). Искусственный интеллект: современный подход (4-е изд.). М.: Вильямс.
-
Тарновский, Д. В. (2020). Искусственный интеллект и анализ данных в биомедицине. СПб.: Питер
-
Балди, П., Брунак, С. (2004). Биоинформатика: методы машинного обучения. М.: Мир.
-
Лешев, А. В. (2021). Программирование на Python для анализа биологических данных. М.: ДМК Пресс.
-
Колесников, А. А. (2020). Биоинформатика: анализ последовательностей и геномов. М.: Лань.
-
Лившиц, Б. Л. (2019). Методика преподавания биологии в средней школе. М.: Академия.
-
Орлова, Н. А. (2018). Информационные технологии в биологии и экологии. М.: Инфра-М.
-
Садовничий, В. А., Чубарьян, А. О. (ред.) (2022). Цифровая трансформация науки и образования: сборник статей. М.: Наука.
-
Биология жалпы білім беретін мектептің жаратылыстану –математика бағытындағы
11 сынып оқулығы: Н.Абылайханова, А.Қалыбаева, А.Пәрімбекова, Б.Үсіпбек
Е.Шевцова
шағым қалдыра аласыз

B


ері
байланыс.






























